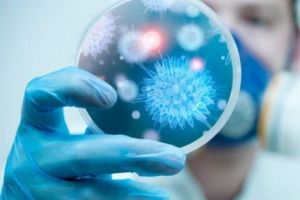
Urgia care a lovit România nu poate fi oprită. Autorităţile sunt depăşite de situaţie

Program 1 Decembrie 2018 la Cluj. Ce concerte sunt şi unde are loc focul de artificii
www.stiridecluj.ro - Cluj
Program 1 Decembrie 2018 la Cluj. Ce concerte sunt şi unde are loc focul de artificii

Bradul de Crăciun din centrul Timişoarei a costat 7000 de euro şi vine tocmai din Italia
www.tion.ro - Timiş
Un brad de 13-14 metri va fi împodobit în centrul Timişoarei cu ocazia sărbătorilor de iarnă. Este primul an în care primăria importă bradul de Crăciun, tocmai din Italia. Municipalitatea plăteşte pentru el cam 7.000 de euro, cu tot cu transport. În alţi ani, pomii de Crăciun au fost donaţi...

Ce să faci în minivacanţa de 1 Decembrie la Timişoara! Programul Târgului de Crăciun
www.tion.ro - Timiş
Timişoara îmbracă straie de sărbătoare. În centrul oraşului a sosit, joi, şi bradul de Crăciun, pom adus din Italia. Pregătirile sunt în toi pentru parada militară de pe Bd. Take Ionescu de Ziua Naţională, când îşi deschide porţile şi Târgul de Crăciun şi când va fi aprins şi iluminatul festiv de sărbători. Vedeţi programul complet de la târg, pe toată perioada lunii decembrie!

În Anul Centenarului, colaboratorii TNT nu sunt plătiţi din cauza Ministerului Culturii
www.tion.ro - Timiş
Din bugetul solicitat Ministerului Culturii şi Identităţii Naţionale, Teatrul Naţional Timişoara nu a primit decât 21,5%. Astfel, 58 de colaboratori ai teatrului nu au fost plătiţi, iar buna funcţionare a TNT şi programul de spectacole din luna decembrie sunt în pericol.

Intersecţia Bălcescu, blocată de tramvaie
www.tion.ro - Timiş
Circulaţia tramvaielor a fost dată peste cap, joi seară, după ce tramvaiul 8 a rămas blocat pe şine. Intersecţia din Piaţa Bălcescu a fost blocată.

Șase maşini sparte într-o singură noapte, pe raza Secţiei 2 Poliţie Timişoara
www.tion.ro - Timiş
Atac al hoţilor, în noaptea de miercuri spre joi, pe raza Secţiei 2 Poliţie Timişoara. Persoane necunoscute au spart şase autoturisme parcate. Au reuşit să fure numai două casetofoane, în rest au provocat distrugeri.

Sibianul Nicolae Ștefănuţă ales pe locul trei pe lista finală a USR pentru europarlamentare
www.oradesibiu.ro - Sibiu
Uniunea Salvaţi România a ales lista celor 43 de candidaţi care vor reprezenta USR la alegerile europarlamentare de pe 26 mai 2019. Din Sibiu au fost aleşi doi candidaţi pe lista USR, Nicolae Ștefănuţă pe locul trei şi Raluca Amariei pe locul 16. Rezultatul vine în urma votului a 5.043…

Protestul celor de la Finanţe cunoaşte o nouă formă. Tot mai multe judeţe se alătură acţiunii
www.tion.ro - Timiş
Angajaţii de la sediul timişorean al Finanţelor continuă protestul, iar inspectorii de specialitate au adoptat o nouă modalitate de a protesta. Una inedită, care teoretic nu afectează activitatea cu publicul, dar care practic poate duce la blocarea acesteia.

Programul manifestărilor de 1 Decembrie la Luduş
www.zi-de-zi.ro - Mureş
Sâmbătă, 1 Decembrie, începând cu ora 14.00, în Piaţa Unirii din Luduş va avea loc manifestarea dedi

Remus Borza, deputat independent: 10 milioane de romani, abandonaţi de România!
ziaruldevalcea.ro - Vâlcea
În 2018, când România aniversează Centenarul Marii Uniri, Guvernul Ungariei alocă 77 milioane euro pentru a finanţa businessuri în inima României, în Ținutul Secuiesc. Singura condiţie este ca proi…

LOVITURĂ de teatru! Darius Vâlcov îi ia locul Liei Olguţa Vasilescu?! Anunţul care a luat prin surprindere pe toată lumea
evz.ro - Bucureşti
Lia Olguţa şi-a sporit şi mai mult notorietatea imediat ce a primit funcţia de ministru al Muncii. Aceasta a luat parte la zeci de emisiuni de la posturile ...

Dromichete, zis Lupul Șchiop şi şchiopul Cuchulan. Apropieri legendare între Irlanda şi România. Horoscop
evz.ro - Bucureşti
Horoscop Sunt multe povestiri despre Lupul Șchiop, dar şi alte popoare au mitologia eroului şchiop, diferit, vulnerabil din cauza beteşugului, dar...

Baschet: România a învins cu 88-83, Kosovo, la Oradea şi păstrează şanse de calificare (FOTO)
www.ebihoreanul.ro - Bihor
Reprezentativa de baschet masculin a României s-a impus joi seară, la Arena Antonio Alexe din Oradea, în faţa selecţionatei Kosovo şi păstrează şanse de calificare pentru următoarea fază din preliminariile Campionatului European, al cărui turneu final se va desfăşura în anul 2021. Cu mai multe absenţe în lot, echipa României şi-a adjudecat partida cu scorul de 88-83, după ce însă pe final de joc oaspeţii au creat mari ermoţii spectatorilor.

Cercul care se închide
www.desteptarea.ro - Bacău
Ne-am învârtit într-un cerc mare, de 100 de ani, ca să ajungem aproape de punctul de la care am pornit. Oficial, sărbătorim Centenarul; neoficial putem vedea că teritoriul ţării nu mai e acelaşi ca acum 100 de ani. Nu o spunem cu gura mare pentru că am semnat nişte tratate ca să putem intra în …

Noi suntem români
www.desteptarea.ro - Bacău
1 Decembrie! Ziua Naţională!! Centenarul!!! Discursuri, steaguri tricolore, defilări, „Deşteaptă-te Române”, mâini duse către inimă, câte o lacrimă în colţul ochiului, festivităţi, poate şi ceva fasole cu ciolan (iuhuhu!), sigur weekend prelungit (oh, yes!) şi, evident, „Noi suntem români”. Bun, şi dincolo de asta? Dincolo de asta, vom continua să trăim într-o ţară pe care …

Proiectul „Laboratorul Infinitronics” propus de Colegiul Naţional „Mircea cel Bătrân” din Râmnicu Vâlcea, printre câştigătorii competiţiei naţionale RO SMART în Țara lui Andrei
ziaruldevalcea.ro - Vâlcea
Un proiect din Râmnicu Vâlcea, printre câştigătorii competiţiei naţionale RO SMART în Țara lui Andrei OMV Petrom a desemnat câştigătorii competiţiei naţionale de proiecte „RO SMART în Țara lui Andr…

Licitatii pentru lucrari de restaurare si conservare a picturilor murale in fresca la doua biserici valcene
ziaruldevalcea.ro - Vâlcea
Parohia „Sf. Gheorghe” din Mun. Rm. Vâlcea, Protopopiatul Râmnicu Vâlcea, jud. Vâlcea, organizează licitaţie pentru adjudecarea lucrărilor de restaurare şi conservare a picturii murale în fr…

Tăriceanu aruncă BOMBA. Va trebui să discutăm cu specialiştii noştri
evz.ro - Bucureşti
Preşedintele Senatului, Călin Popescu-Tăriceanu, admite că există posibilitatea apariţiei unei crize economice la nivel mondial, având în vedere ciclicitate...

INCENDIU la acoperişul unei case din Sebeş
ziarulunirea.ro - Alba
Acoperişul unei case din municipiul Sebeş a luat foc, joi noaptea, în jurul orei 23.50. Pentru stingerea incendiului s-au deplasat la faţa locului 10 ofiţeri de la Garda de pompieri Sebeş, cu 2 Autospeciale şi o ambulanţă SMURD B2, şi voluntari de la SVSU Sebeş. După localizarea şi stingerea în totalitate a incendiului se vor […]

Părerea lui Terente
evz.ro - Bucureşti
Părerea lui Terente...

La mulţi ani, România! Mesajele vedetelor de CENTENAR pentru TOȚI ROMÂNII
evz.ro - Bucureşti
Cele mai îndrăgite vedete de pe micile ecrane au o viziune atipică asupra Zilei Naţionale. Andreea Marin, Paul Surugiu, Radu Buzăianu şi Răzvan Zamfi r ne-a...

Semnele metamorfozei. Editorial de Ingrid Mocanu
evz.ro - Bucureşti
În vremea de dinainte de ’89 un profesor de matematică de liceu le atrăgea atenţia la semnele matematice tinerilor săi învăţăcei, dându-le exemplul profeţii...

Carnea de porc, mai scumpă de sărbători din cauza pestei porcine
evz.ro - Bucureşti
Carnea de porc va fi mai scumpă de Crăciun, iar românii vor pune pe masă carne din Germania sau Spania, dat fiind că pesta porcină nu a afectat doar gospoda...

Despre denigratorii Catedralei Neamului. Istoriile lui Alex Ștefănescu
evz.ro - Bucureşti
Nu există spectacol mai jalnic decât acela al denigrării Catedralei Mântuirii Neamului, cea mai impresionantă realizare a ţării noastre în anii de după 1989...

Modificări importante ale traseelor autobuzelor din Capitală, de Centenar
evz.ro - Bucureşti
În zilele de 30 Noiembrie şi 1 Decembrie, liniile de transport public vor funcţiona după un program de circulaţie corespunzător unei zile de duminică, cu ur...

Vineri, 30 noiembrie
evz.ro - Bucureşti
Nr. 8380, 24 de pagini 2,8 lei...

Sfântul zilei. Întâiul chemat
evz.ro - Bucureşti
Sfântul Apostol Andrei, prăznuit pe 30 noiembrie, s-a născut în Betsaida, provincia Galileea, din nordul Țării Sfinte. Betsaida era aşezată pe malul Lacului...

Robin Williams s-a plimbat pe străzi deghizat în Mrs. Doubtfire şi nimeni nu şi-a dat seama!
evz.ro - Bucureşti
Celebrul actor de comedie, pasionat de munca sa, ar fi făcut orice pentru a intra în pielea personajului. Odată chiar s-a plimbat pe străzi îmbrăcat în Mrs....

Emmanuel Macron faţă cu protestele violente anti-europene şi eurosceptice la Paris
evz.ro - Bucureşti
Franţa se scufundă într-o bătălie politică de stradă plecată de la un protest social pentru preţul carburanţilor, transformată într-o revolută politizată îm...

Unul dintre cele mai bogate oraşe din lume. În urmă cu 30 de ani era un sat de pescari
evz.ro - Bucureşti
Trăim în secolul vitezei, iar cel mai bun exemplu este acest oraş care în 1979 era doar un sat de pesacari, iar acum este o metropolă cu cinci milioane de l...

REVENIRE surpriză în POLITICA ROMÂNEASCĂ: „Am depus această candidatură”
evz.ro - Bucureşti
Fostul preşedinte al PNL, Crin Antonescu, a declarat că revine oficial în politică, după doi ani de retragere din viaţa politică....

MESAJE de SFANTUL ANDREI 2018. Ce SMS-uri, urări, felicitări, mesaje poţi trimite celor care îşi sărbătoresc onomastica de Sf. Andrei
ziarulunirea.ro - Alba
MESAJE DE LA MULTI ANI DE SFÂNTUL APOSTOL ANDREI 2018 • Urări, felicitări şi sms-uri frumoase de Sfântul Andrei pentru cei care îşi sărbătoresc ziua numelui. ”La mulţi ani de Sfântul Andrei”. Texte cu mesaje haioase şi amuzante de Sf Andrei. Ziua de 30 noiembrie este marcata în calendarul creştin-ortodox ca fiind una din cele […]

POLIȚIȘTI valceni avansaţi în grad de Centenar
ziaruldevalcea.ro - Vâlcea
Cu ocazia centenarului Marii Uniri, urmatorii poliţişti din cadrul IPJ Vâlcea au fost avansaţi în gradul profesional următor, înaintea îndeplinirii stagiului minim: Ag. Ceauşescu Sandra – Luiza, ag…

TÂRGOVIȘTE: PatriHoţism local! Doi tineri au furat un steag din micro 12 – VIDEO
www.gazetadambovitei.ro - Dâmboviţa
Imagini de la cititori Doi tineri au fost filmaţi în această seară, în micro raionul 12 al municipiului Târgovişte, furând

Iubita lui Columbeanu, mesaj plin de subînţelesuri! A dezvăluit Oana CEL MAI IMPORTANT DETALIU din relaţia lor?
evz.ro - Bucureşti
Irinel Columbeanu şi Oana Cojocaru formează unul dintre cele mai neconvenţionale cupluri din showbiz-ul românesc. Având în vedere diferenţa mare de vârstă d...

„Unitatea de credinţă este temelia unităţii de neam a românilor”, a spus Înaltpreasfinţitul Părinte Varsanufie la Ședinţa festivă a Consiliului Judeţean Vâlcea
ziaruldevalcea.ro - Vâlcea
Joi, 29 noiembrie, Înaltpreasfinţitul Părinte Varsanufie, Arhiepiscopul Râmnicului, a participat la Ședinţa festivă a Consiliului Judeţean Vâlcea, organizată cu prilejul sărbătoririi Centenarului M…

Florin Piersic de Centenar: Nu am încredere în cei care ne conduc
www.stiridecluj.ro - Cluj
Florin Piersic de Centenar: Nu am încredere în cei care ne conduc

BREAKING NEWS. A ÎNCEPUT RĂZBOIUL! Israelul A ATACAT Siria. Aliaţii se repoziţionează
evz.ro - Bucureşti
Forţe armate israeliene au atacat joi poziţii militare în Siria. Agenţia de presă siriană SANA informează că a atacat „ţinte inamice”, în oraşul Damasc....

Pelerinajul luminii, un semn de mulţumire şi de preţuire pentru Sf. Andrei
stiridegalati.ro - Galaţi
Marşul Luminii este organizat în fiecare an la Galaţi, în ajunul Sfântului Andrei. Tinerii se îmbracă în straie populare şi pleacă de la Catedrala Arhiepiscopală, cu făclii aprinse, refăcând astfel drumul pe care l-a făcut Sfântul Andrei atunci când a venit pe aceste meleaguri pentru a propăvadui creştinismul. „Pelerinajul luminii sau lumina Sfântului Andrei, cum …

Simpozionul „Centenarul Marii Uniri a românilor” (1918 – 2018), implicaţii politice, socio – economice şi culturale
ziaruldevalcea.ro - Vâlcea
Prefectura Judeţului Vâlcea împreună cu Arhivele Naţionale – Serviciul Judeţean Vâlcea au organizat joi, 29 noiembrie, Simpozionul „Centenarul Marii Uniri a Românilor (1918 – 2018), implicaţii poli…

AJUTOR DE DECES: Pentru cate cazuri a dat bani Casa Judeteana de Pensii Maramures in primele noua luni din 2018
ziarmm.ro - Maramureş
In perioada 1 ianuarie 2018 – 30 septembrie 2018, Casa Judeteana de Pensii Maramures a platit cu titlu de ajutor de deces, in cazul decesului pensionarilor sau al unui membru de familie al acestora, s

Fotbal: Minerul Baia Mare-AFC Odorheiu Secuiesc, ultima etapa a turului pentru baimareni
ziarmm.ro - Maramureş
Minerul Baia Mare joaca ultima etapa a turului seriei a V-a a Ligii a III-a de Fotbal in deplasare. Partida impotriva celor de la AFC Odorheiu Secuiesc va avea loc vineri, 30 noiembrie, cu incepere de

Cyber Coaliţia care a alertat Moscova. România şi-a mobilizat zeci de specialişti la un centru avansat
evz.ro - Bucureşti
România a mobilizat zeci de specialişti din MApN şi SRI. Cyber Coalition pune în alertă autorităţile de la Moscova. NATO coordonează totul....

Luna uriaşă din Biserica Piariştilor nu mai poate fi vizitată
www.stiridecluj.ro - Cluj
Luna uriaşă din Biserica Piariştilor nu mai poate fi vizitată

Sibian arestat pentru furturi din mall-uri în Vâlcea şi Cluj – Prada găsită la percheziţii
www.oradesibiu.ro - Sibiu
Un bărbat de 32 de ani din Sibiu a fost reţinut de poliţiştii clujeni în urma unor percheziţii care au avut loc în capitala judeţului nostru. Acesta este acuzat că ar fi săvârşit mai multe furturi din centre comerciale la Râmnicu Vâlcea şi Cluj Napoca. Poliţiştii clujeni au au reţinut,…

Luna uriaşă din Biserica Piariştilor nu mai poate fi vizitată
www.stiridecluj.ro - Cluj
Luna uriaşă din Biserica Piariştilor nu mai poate fi vizitată

Luna uriaşă din Biserica Piariştilor nu mai poate fi vizitată
www.stiridecluj.ro - Cluj
Luna uriaşă din Biserica Piariştilor nu mai poate fi vizitată

„Centenarul Marii Uniri” – Moment istoric şi artistic de excepţie în Scuarul „Mircea cel Bătrân”
ziaruldevalcea.ro - Vâlcea
Teatrul Municipal „Ariel”, cu sprijinul Primăriei Municipiului Râmnicu Vâlcea organizează sâmbătă, 1 decembrie 2018, începând cu ora 19:00, „Centenarul Marii Uniri”, în Scuarul „Mircea cel Bă…

DÂMBOVIȚA: Un primar a tăiat o vacă în curtea instituţiei pentru a împărţi carnea de Centenar
www.gazetadambovitei.ro - Dâmboviţa
FOTO: MDI TV Primăria din comuna dâmboviţeană Vârfuri va sărbători Centenarul într-un mod cu totul deosebit. Astăzi, în curtea instiuţiei,

Sedinta festiva a Consiliului Judetean Valcea a adus PACEA POLITICA in judet
ziaruldevalcea.ro - Vâlcea
La invitaţia preşedintelui Consiliului Judeţean Vâlcea, Constantin Rădulescu, am participat alături de Înaltpreasfinţitul Varsanufie, Arhiepiscopul Râmnicului, primarul municipiului Râmnicu Vâlcea,…

Urgia care a lovit România nu poate fi oprită. Autorităţile sunt depăşite de situaţie
evz.ro - Bucureşti
Autoritatea Naţională Sanitară Veterinară şi pentru Siguranţa Alimentelor a anunţat că România înregistrează 1.124 de focare de pestă porcină africanăşi 361...

Sibianul Nicolae Ștefănuţă ales pe locul trei pe lista finală a USR pentru europarlamentare
revistapresei.oradesibiu.ro - Sibiu
Uniunea Salvaţi România a ales lista celor 43 de candidaţi care vor reprezenta USR la alegerile europarlamentare de pe 26 mai 2019. Din Sibiu au fost aleşi doi candidaţi pe lista USR, Nicolae Ștefănuţă pe locul trei şi Raluca Amariei pe locul 16. Rezultatul vine în urma votului a 5.043…

Judetele Constanta si Tulcea, sub cod galben de intensificari ale vantului. Cand expira atentionarea meteo
www.ziuaconstanta.ro - Constanţa
Administratia Nationala de Meteorologie a emis in aceasta seara cod galben de vant puternic valabil in perioada 29-11-2018 ora 23 00 pana la 29-11-2018 ora 05 00. Este vizat judetul Constanta si ...

Mama copilului ucis de câini a vorbit pentru prima oară: Îngeraşul îmi trimite semne
evz.ro - Bucureşti
Pe 2 septembrie 2013, Ionuţ Anghel era ucis de câini în Parcul Tei din Capitală. La acea vreme, vestea a stârnit indignarea opinie publice, prilej cu care s...

O femeie şi un bărbat cu mandate de arestare, ridicaţi de poliţie
ziaruldevalcea.ro - Vâlcea
Poliţişti ai Serviciului de Investigaţii Criminale şi Postului de poliţie Bărbăteşti au pus în aplicare două mandate de executare a pedepsei cu închisoarea, emise de Judecătoria Horezu şi Tribunalu…

Un tânăr a MURIT în GRECIA. Familia face apel pentru repatrierea trupului neînsufleţit
evz.ro - Bucureşti
Un tânăr din România, care ar fi urmat să împlinească 30 de ani pe 30 noiembrie, a murit în Grecia în urma unui accident....

Un dâmboviţean deschide lista USR pentru Europarlamentare
www.gazetadambovitei.ro - Dâmboviţa
Uniunea Salvaţi România a ales lista celor 43 de candidaţi care vor reprezenta USR la alegerile europarlamentare de pe 26

Transportatorii acuză: Vama Giurgiu e paralizată de 2.000 de camioane de marfă
evz.ro - Bucureşti
O coloană de aproximativ de 40 de kilometri şi 2.000 de camioane. Asta este situaţia la Vama Giurgiu, potrivit FORT, una dintre cele mai importante organiza...

NEPI Rockcastle se prăbuşeşte la Bursă, cu o săptămână înainte să deschidă la Satu Mare
portalsm.ro - Satu Mare
NEPI Rockcastle se prăbuşeşte la Bursă, cu o săptămână înainte să deschidă la Satu Mare

Internarile la Maternitatea Giulesti, sistate incepand de vineri
www.ziuaconstanta.ro - Constanţa
Directia de Sanatate Publica Bucuresti a solicitat Spitalului Clinic de Obstetrica-Ginecologie Prof. Dr. Panait Sirbu Bucuresti sa sisteze internarile incepand de vineri, scrie Romania TV. De ...

Dragnea stă acasă de 1 decembrie – ’’Medicul nu îmi recomandă să stau în frig’’
www.oradesibiu.ro - Sibiu
Liderul social democraţilor nu va fi prezent la nici una dintre festivităţile organizate de Ziua Naţională a României. Spune că nu se prea simte bine. Preşedintele PSD Liviu Dragnea nu va apărea în public de 1 Decembrie, Ziua Naţională a României, anunţă Digi 24. Liviu Dragnea a spus că nu…

Sibian arestat pentru furturi din mall-uri în Vâlcea şi Cluj – Prada găsită la percheziţii
revistapresei.oradesibiu.ro - Sibiu
Un bărbat de 32 de ani din Sibiu a fost reţinut de poliţiştii clujeni în urma unor percheziţii care au avut loc în capitala judeţului nostru. Acesta este acuzat că ar fi săvârşit mai multe furturi din centre comerciale la Râmnicu Vâlcea şi Cluj Napoca. Poliţiştii clujeni au au reţinut,…

Știati ca.....Este Ziua Sfantului Apostol Andrei
www.ziuaconstanta.ro - Constanţa
Andrei a fost un apostol al lui Isus din Nazaret, frate cu Simon Petru, informeaza wikipedia.org. Evanghelia dupa Ioan mentioneaza ca Andrei ar fi fost mai intai ucenic al lui Ioan Botezatorul, care i-ar ...

Remedii naturale pentru mainile umflate
www.ziuaconstanta.ro - Constanţa
Sindromul tunelului carpian, probleme cu circulatia, artrita sau o muscatura de insecta sunt cauze prin care se dezvolta acest fenomen, scrie realitatea.net. Astfel, pentru a ameliora mainile umflate, ...

O firma fondata de un fost primar de municipiu din judetul Constanta cere sa intre in insolventa
www.ziuaconstanta.ro - Constanţa
Societatea comerciala Village Tour SRL, cu sediul social in municipiul Mangalia, cere sa intre in insolventa. Solicitarea se afla pe rolul Tribunalului Constanta. Pana in prezent, nu a fost stabilit ...

Mai era un minut! SSC Farul Constanta, esec dureros la Timisoara: Petre Grigoras - Acesta e fotbalul. Neatentia se plateste“
www.ziuaconstanta.ro - Constanţa
SSC Farul Constanta a ratat la mustata obtinerea unui punct in meciul din deplasare cu Ripensia Timisoara, din etapa a 19-a a Ligii a 2-a. Gazdele s-au impus cu 1-0, marcand golul in al treilea dintre cele ...

O firma din Tulcea va livra pluguri nereversibile Directiei Silvice Constanta (document)
www.ziuaconstanta.ro - Constanţa
Regia Nationala a Padurilor - Romsilva RA cumpara de la o firma din Tulcea doua pluguri nereversibile cu 3 cormane pentru Directia Silvica Constanta. Valoarea contractului atribuit este de 35.700 lei. ...

Firma controlata de fratele fostului primar din Cogealac, Ion Soare, se va ocupa de construirea unei sali de sport la Școala 2 Mai (document)
www.ziuaconstanta.ro - Constanţa
Primaria Limanu a semnat cu societatea Eraos SA, care si-a adjudecat contractul Servicii de proiectare si executie lucrari privind infiintarea unei sali de sport la Scoala Gimnaziala 2 Mai, comuna ...

Oameni de afaceri si directori din Consiliul Judetean, condamnati. Ce a decis Inalta Curte
www.ziuaconstanta.ro - Constanţa
Inalta Curte de Casatie si Justitie a Romaniei a finalizat pentru acest an cercetarea specifica in dosarul in care Nicusor Daniel Constantinescu, fostul presedinte al Consiliului Judetean Constanta, a ...

CFR Constanta urmeaza sa repare sobele din statiile din judet. Ce costuri au lucrarile (document)
www.ziuaconstanta.ro - Constanţa
Compania Nationala de Cai Ferate CFR SA organizeaza o licitatie pentru atribuirea unui contract pentru reparatii sobe la cladiri de pe raza SRCF Constanta. Lucrarile de refacere, construire, ...

Firma General Concrete Cernavoda SRL a prins un contract cu Societatea Nationala Nuclearelectrica SA (document)
www.ziuaconstanta.ro - Constanţa
Societatea Nationala Nuclearelectrica SA a atribuit un contract pentru achizitia de servicii de exploatare, intretinere si reparatii la obiectivele circuitului hidrotehnic al apei de racire la CNE ...

Modificari importante in Legea Adoptiei. Sume importante pentru copiii adoptati in conditii speciale (document)
www.ziuaconstanta.ro - Constanţa
Senatul a aprobat o lege prin care sume semnificative vor fi acordate lunar celor care adopta copii peste trei ani, cu handicap sau frati, potrivit unui proiect de lege. Cu cat vor fi indeplinite mai multe ...

La Cernavoda descinde liderul: Meciul de fotbal Axiopolis - Rapid Bucuresti se joaca fara spectatori
www.ziuaconstanta.ro - Constanţa
Partida incepe la ora 14.00 ca de altfel toate meciurile rundei, care au fost programate tot astazi . In clasament, Axiopolis se afla pe locul noua, cu 14 puncte, in vreme ce Rapid conduce ierarhia cu 35 de ...

Declaratie de avere - Denis Mugurel Gogirnoiu, sef serviciu in cadrul Serviciului Teritorial Sud-Vest al ONJN (document)
www.ziuaconstanta.ro - Constanţa
Denis Mugurel Gogirnoiu este sef serviciu la Serviciul Teritorial Sud-Vest din cadrul Oficiului National pentru Jocuri de Noroc. El si-a depus declaratia de avere la data de 15 iunie 2018. Astfel, ...

Aristocratul periscoapelor: Cruciera recunostintei (galerie foto)
www.ziuaconstanta.ro - Constanţa
Intre personalitatile evocate si omagiate anul acesta de cotidianul ZIUA de Constanta, odata cu acordarea plachetei ,,Meritul Dobrogean , se afla, la loc de mare cinste si de binemeritata onoare, ...

Ședintele de Consiliu Local vor urma viata orasului. Consilierii s-au reunit in Gara Maritima. Ce proiecte au fost aprobate
www.ziuaconstanta.ro - Constanţa
Primarul municipiului Constanta a ajuns la concluzia ca intalnirile lunare consacrate sub numele de sedinta de Consiliu Local trebuie sa urmeze viata orasului. Din acest motiv, sedinta din luna ...

Sediul firmei New Byblos SRL, controlata de Serghei Niculescu Mizil si George Papari, mutat in Constanta
www.ziuaconstanta.ro - Constanţa
Controversatul om de afaceri Serghei Niculescu Mizil si prietenul sau George Papari au operat schimbari in societatea New Byblos SRL. Astfel, potrivit deciziei publicate in Monitorul Oficial al Romaniei, ...

Meniu de zile mari, oferit pacientilor din Constanta de catre Arimex Comexim 2000 SRL, de Sfantul Apostol Andrei
www.ziuaconstanta.ro - Constanţa
Biserica Ortodoxa si Biserica Romano-Catolica il praznuiesc, pe 30 noiembrie, pe Sfantul Apostol Andrei, cel dintai chemat , fratele Sfantului Apostol Petru. Arimex Comexim 2000 SRL nu a uitat de cele ...

Un militar profesionist, eliminat din sistem pentru ca era prea gras! Primul termen in recurs, la finele anului 2020
www.ziuaconstanta.ro - Constanţa
Judecatorii din cadrul Sectiei de Contencios Administrativ si Fiscal din Inalta Curte de Casatie si Justitie a Romaniei au stabilit primul termen in dosarul in care un militar profesionist a fost dat ...

Modificari in societatea Santierul Naval 2 Mai SA Mangalia. Administratori noi, votati de Adunarea Generala
www.ziuaconstanta.ro - Constanţa
Santierul Naval 2 Mai SA Mangalia a luat mai multe decizii in cadrul Adunarii Generale Ordinare a Actionarilor, care a avut loc in data de 28 noiembrie 2018. Una dintre hotarari este aprobarea prin vot ...

Uniunea Salvati Romania deschide portile Parlamentului pentru cetateni. Ce mesaj are deputatul Stelian Ion
www.ziuaconstanta.ro - Constanţa
Deputatul USR de Constanta Stelian Ion invita si constantenii miercuri, 5 decembrie, intre orele 9.00 - 14.00, sa vina sa descopere Parlamentul si sa urmareasca live o sedinta de Plen a Camerei ...

Rocka Genco SRL din Chiajna si-a adjudecat un contract de la Academia Navala Mircea cel Batran“ din Constanta (document)
www.ziuaconstanta.ro - Constanţa
Academia Navala Mircea cel Batran Constanta - Unitatea Militara 02192 Constanta a semnat cu Rocka Genco SRL, care si-a adjudecat contractul Lucrari de reparatii curente de asfaltare in Cazarma 1369 , ...

Interviu cu prof. Adrian Ilie, director adjunct al Scolii Constantin Brancusi“ Medgidia: Desi timpul ramas este limitat, pasiunea pentru istorie si pentru scris nu s-a estompat in niciun fel“
www.ziuaconstanta.ro - Constanţa
Sarguinciosul profesor Adrian Ilie, exceptional colaborator al cotidianului ZIUA de Constanta, ale carui articole le puteti lectura in categoria Invitati, a dedicat Centenarului o ampla lucrare, ...

O fata cu har / Ce a iesit din neamul armanesc“: Simona Halep a dansat la Calarasi si pe ritmurile melodiei inchinate ei (video)
www.ziuaconstanta.ro - Constanţa
Marea campioana Simona Halep, aflata de 56 de saptamani pe locul intai in clasamentul mondial al tenisului feminin, a primit un nou titlu de cetatean de onoare, dupa cele acordate de autoritatile ...

Cine nu respecta regulile va fi evacuat: Decebal Fagadau - Daca acest campus social va fi un esec, va fi esecul nostru!“
www.ziuaconstanta.ro - Constanţa
In luna decembrie va incepe predarea locuintelor modulare din Campusul Social Henri Coanda, a anuntat primarul municipiului Constanta, Decebal Fagadau. Etapa a II-a a programului de constructie de ...

Se poate si invers!: O tanara din Constanta a fost condamnata pentru ca a santajat un baiat
www.ziuaconstanta.ro - Constanţa
Judecatoria Constanta a dispus ieri condamnarea unei tinere acuzate ca a santajat un baiat. Fata a fost trimisa in judecata de procurorii din Parchetul de pe langa Judecatoria Constanta, pentru ...

Intersecţia groazei: Un Duster şi-a făcut botul praf, lovindu-se de un Ford, lângă podul Dacia (FOTO/VIDEO)
www.ebihoreanul.ro - Bihor
O nouă tamponare a avut loc, joi seara, în intersecţia bulevardului Magheru cu Parcul Traian, provocată de neacordarea de prioritate. Un Duster, intrat în coliziune cu un autoturism Ford, a înregistrat avarii serioase în partea frontală. Din fericire, nimeni nu a fost rănit.

MESAJ fără precedent al marelui FLORIN PIERSIC: „Toată viaţa mea am fost un om care a sperat şi a crezut”
evz.ro - Bucureşti
Actorul Florin Piersic a transmis joi seară că speră ca România să fie „cea mai dulce, bună şi generoasă” şi să „îşi ia frâiele în mâini”....

Ecaterina Andronescu, la Alba Iulia, despre creşterea veniturilor din Educaţie: Ministrul Finanţelor s-a angajat că sunt bani
ziarulunirea.ro - Alba
Ecaterina Andronescu a spus că ministrul Finanţelor s-a angajat că o să avem bani pentru creşterea veniturilor alocate Educaţiei, precizând că majorările sunt necesare, dar că efortul financiar e important. Ecaterina Andronescu a fost întrebată, joi, la Alba Iulia, după ce a participat la o şedinţă solemnă a Guvernului, de unde vor fi bani pentru […]

Doliu in lumea muzicii romanesti! O cunoscuta cantareta de muzica populata a decedat
www.ziuaconstanta.ro - Constanţa
E doliu in folclorul romanesc, dupa ce Anuta Tite a murit, scrie Antena3.ro. Cantareata de muzica populara, a carei voce a impresionat in filmul Pintea , s-a stins din viata la Spitalul Municipal ...

FABULOS. 5.000 de schiori pe 20 km de pârtie! Semenic, cel mai mare domeniu schiabil din România!
expressdebanat.ro - Caraş-Severin
Ministerul Turismului a dat aviz favorabil proiectului prin care Consiliul Judeţean Caraş-Severin, Primăria Reşiţa şi Primăria Văliug transformă spectaculos zona turistică Semenic! Peste 40 de milioane de euro vor fi investite în două pârtii care coboară de pe Semenic la Văliug, în telegondolă, tunuri de zăpadă, dar şi în mijloace de agrement pentru sezonul estival!…

Adevărul despre copilul ce cerşeşte pentru sora sa. Are mamă şi merge la şcoală
portalsm.ro - Satu Mare
Informaţiile apărute în această seară pe Facebook potrivit căruia un copil, în vârstă de 11 ani, îşi creşte singur sora, în vârstă de 1 an, au stârnit reacţii din partea mai multor mămici. Surse avizate au precizat pentru PortalSM că micuţul locuieşte cu mama lui, are o soră mai mare şi merge la şcoală.

DĂNCILĂ, contestată din interiorul PSD. ATACUL la IOHANNIS care CONTRAZICE PREMIERUL
evz.ro - Bucureşti
Secretarul general al PSD, Codrin Ștefănescu, i-a oferit un răspuns Preşedintelui Klaus Iohannis, după ce acesta a făcut un apel la politicienii PSD să nu a...

Cu timişoreanul Olah titular, naţionala de baschet masculin a câştigat meciul cu Kosovo
expressdebanat.ro - Caraş-Severin
Naţionala României de baschet masculin s-a impus cu 88-83 în meciul cu Kosovo, jucat la Oradea şi contând pentru pre-calificările la Eurobasket 2021. Din lot au făcut parte un timişorean şi doi jucători de la SCM Timişoara.

FOTO. Haine pe copaci pentru cei nevoiaşi, la Satu Mare. Au mai rămas două geci!
portalsm.ro - Satu Mare
Campania ”Haine pe copaci” s-a dovedit a fi un succes şi la Satu Mare. Din 22 noiembrie şi până astăzi au mai rămas doar două geci în copacii din centrul Sătmarului.

Liviu Dragnea nu va fi prezent la manifestarile de 1 Decembrie. Care este motivul
www.ziuaconstanta.ro - Constanţa
Presedintele PSD Liviu Dragnea nu va participa la evenimentele dedicate Zilei Nationale a Romaniei, dupa ce medicul i-a recomandat sa nu stea atatea ore la temperaturi scazute, transmit reprezentantii ...

Dacă ar mai trăi, Caragiale ar găsi inspiraţia pentru opera sa satirică în şedinţele aleşilor locali din Caransebeş
expressdebanat.ro - Caraş-Severin
Circ în Consiliul Local Caransebeş în preajma Centenarului Marii Uniri, chiar dacă aleşii locali declarau cu câteva ore înaintea şedinţei de azi, la un alt eveniment, că măcar în aceste zile trebuie să uite de politică şi să nu fie dezbinaţi... În cauză, primarul liberal Felix Borcean şi consilierul PSD Florin Bogdea.

SECRETUL TERIBIL al unei vedete de la noi! Arată IMPECABIL la televizor, dar nimeni nu bănuia CE ASCUNDE
evz.ro - Bucureşti
La televizor arată impecabil, de fiecare dată când îşi face apariţia, însă o vedetă extrem de cunoscută de la noi ascunde un secret teribil....

Dragnea stă acasă de 1 decembrie – ’’Medicul nu îmi recomandă să stau în frig’’
revistapresei.oradesibiu.ro - Sibiu
Liderul social democraţilor nu va fi prezent la nici una dintre festivităţile organizate de Ziua Naţională a României. Spune că nu se prea simte bine. Preşedintele PSD Liviu Dragnea nu va apărea în public de 1 Decembrie, Ziua Naţională a României, anunţă Digi 24. Liviu Dragnea a spus că nu…

FOTO / VIDEO: Peste 500 de rotarieni, din ţară şi din străinătate, sărbătoresc, alături de Rotary Club Alba Iulia, 100 de ani de la Marea Unire
ziarulunirea.ro - Alba
Peste 500 de rotarieni participă în aceste zile, alături de Rotary Club Alba Iulia, la evenimentele dedicate împlinii a 100 de ani de la Marea Unire din 1918, evenimente care se derulează în perioada 29 noiembrie – 2 decembrie, sub genericul ”Alba Iulia 100”. Evenimentul, organizat de Clubul Rotary Alba Iulia, împreună cu Districtul Rotary […]

Operă de artă UNICĂ în cea mai VECHE BISERICĂ din Cluj
evz.ro - Bucureşti
Biserica Catolică a Piariştilor din Cluj găzduieşte în aceste zile o machetă la „Lunii”, cu un diametru de şapte metri. Mii de persoane au vizitat creaţia u...

Decizie socanta, luata de actorul Alexandru Arsinel. Ce se va intampla cu Teatrul de Revista Constantin Tanase
www.ziuaconstanta.ro - Constanţa
Alexandru Arsinel, celebrul actor roman, a luat o hotarare foarte grea, scrie Romania TV. Acesta a decis sa se retraga din activitate, intrucat anii si-au pus amprenta asupra sanatatii sale. ...

Toţi şoferii sunt vizaţi! Cum vă pot lăsa medicii fără permisul de conducere
evz.ro - Bucureşti
Șoferii vor fi obligaţi să se prezinte la control medical în cazul în care un medic le descoperă o problemă medicală care le-ar putea afecta capacitatea de ...

Aradul va avea cel puţin un EUROPARLAMENTAR, din 2019! Și nu este vorba de Gheorghe Falcă
newsar.ro - Arad
Citeşte azi ce scriu ziarele de mâine!

DESCOPERIRE EPOCALĂ în lumea creştină! Un mesaj MISTERIOS a ieşit de-abia acum la iveală
evz.ro - Bucureşti
O inscripţie veche de 2000 de ani purtând numele „Pilat”, de pe un inel, a fost descifrată de curând de cercetătorii israelieni. Inscripţia ar putea face tr...

Ministrul Justiţiei, întrebat la Alba Iulia despre amnistie şi graţiere: La această întrebare am mai răspuns
ziarulunirea.ro - Alba
Ministrul Justiţiei, Tudorel Toader, a fost întrebat, joi, la Alba Iulia, de două ori, dacă va fi dată vreo ordonanţă de amnistie şi graţiere, însă a evitat să răspundă, precizând de fiecare dată că a mai răspuns, iar decizia rămâne valabilă. Prima dată Tudorel Toader a fost întrebat despre amnistie şi graţiere în Sala Unirii […]

România – ţara în care toată lumea vrea stîrpirea Corupţiei, dar de ales sînt aleşi tot corupţii! România lui Cristoiu
evz.ro - Bucureşti
Din motive care ţin de paralele date sau doar făgăduite de Majestatea Sa, Carol al II-lea, Tudor Arghezi se manifestă în scrisul la gazetă ca un menestrel a...

Mesajul lui Florin Piersic cu ocazia Centenarului
www.ziuaconstanta.ro - Constanţa
Actorul Florin Piersic a declarat joi seara, la un eveniment dedicat Centenarului, ca la 100 de ani de la Marea Unire ii transmite Romaniei sa-si ia soarta in maini, scrie Antena3.ro. Romaniei nu pot ...

LOVITURĂ pentru TOADER. I se cere DEMISIA din Ministerul JUSTIȚIEI. IORDACHE este IMPLICAT
evz.ro - Bucureşti
Se impune demisia ministrului Justiţiei, Tudorel Toader, şi a preşedintelui Comisiei speciale Florin Iordache, ca urmare a promovării a zeci de articole nec...

FOTO. Alertă la Aeroportul Satu Mare! Accident aviatic de proporţii (exerciţiu)
portalsm.ro - Satu Mare
O defecţiune tehnică şi prezenţa unui bagaj suspect în cala de bagaje a unui avion abia decolat de pe Aeroportul Satu Mare a pus rapid în acţiune Comitetul de Management al Situaţiilor de Risc, în cadrul căruia ISU are funcţie de sprijin.

DĂNCILĂ, răspuns despre AMNISTIE şi GRAȚIERE. Ce i-a transmis lui IOHANNIS
evz.ro - Bucureşti
Premierul Viorica Dăncilă a reacţionat după ce Preşedintele Klaus Iohannis a lansat o serie de atacuri la adresa Guvernului. Ea a făcut referire şi despre O...

Gardurile jandarmilor, daramate de sutele de credinciosi din fata Catedralei Mantuirii Neamului
www.ziuaconstanta.ro - Constanţa
Au fost scene incredibile in fata Catedralei Mantuirii Neamului, unde sute de credinciosi au daramat gardurile jandarmilor si au fortat intrarea, scrie Observator TV. Se temeau ca nu vor mai apuca sa ...

Vreme la extreme: Temperaturi deosebit de reci în zilele următoare, inclusiv în Bihor. De duminică, vremea se încălzeşte accentuat
www.ebihoreanul.ro - Bihor
Administraţia Naţională de Meteorologie a emis, joi, o infomare meteorologică de vreme deosebit de rece valabilă în mai multe zone ale ţării, inclusiv pentru judeţul Bihor. De duminică, însă, vom avea parte de un proces de încălzire accentuată.

Teodorovici, REPLICĂ ACIDĂ pentru Iohannis, după ce a fost atacat de preşedinte: „Îi urez succes până în 2019, când va fi SCHIMBAT”
evz.ro - Bucureşti
Ministrul de Finanţe Eugen Teodorovici a reacţionat joi seară, după atacul lansat de preşedintele Klaus Iohannis la adresa sa, pe tema limitării dretului ro...

Simona Halep a semnat un nou contract de sponsorizare. Câţi bani a luat de la sponsori anul acesta
evz.ro - Bucureşti
Simona Halep, cea mai bună jucătoare de tenis din lume, numărul 1 mondial, a anunţat astăzi că a semnat un nou contract de sponsorizare cu o firmă din Român...

VIDEO: Accident rutier pe DN7, în apropiere de Lutsch 2000: Două maşini s-au făcut praf în intersecţia cu drumul spre Vinţu de Jos
ziarulunirea.ro - Alba
Un accident rutier cu pagube semnificative pentru şoferii implicaţi a avut loc, joi seara, pe DN7, la intersecţia cu drumul spre Vinţu de Jos. În filmul primit de la un participant la trafic se vede gradul de distrugere al celor două autoturisme. Revenim cu detalii Ziarul Unirea Email: stiri@ziarulunirea.ro Tel: 0258.811.419

Bugetarea participativă a ajuns la final – Nouă proiecte de la sibieni, pentru sibieni
www.oradesibiu.ro - Sibiu
Programul de bugetare participativă 2018 se va încheia în 30 noiembrie cu publicarea proiectelor care au fost selectate în etapa finală de vot, Primăria Sibiu urmând să aloce fonduri din bugetul local şi să le implementeze. Acestea pot fi consultate pe site-ul programului https://bugetareparticipativa.sibiu.ro/. Scurtă descriere a proiectelor selectate, în…

FC Hermannstadt – Concordia Chiajna de Ziua Naţională a României. ”Tati” vrea MUSAI o victorie
www.oradesibiu.ro - Sibiu
Echipa sibiană joacă, sâmbătă, 1 decembrie, de la ora 14:00, pe Stadionul ”Trans-Sil” din Tg. Mureş, cu Concordia Chiajna, în etapa a XVII-a a Ligii 1. În tur, ilfovenii au câştigat cu 2-0. FC Hermannstadt este neînvinsă în ultimele 4 etape de campionat, în care a adunat 10 puncte din…

Piatra-Neamţ: S-a aprins iluminatul ornamental pentru sărbătorile de iarnă (FOTO)
www.stiri-neamt.ro - Neamţ
Primăria Piatra Neamţ a pornit în această seară, 29 noiembrie, iluminatul ornamental şi se pregăteşte de sărbătorile de iarnă. Zona cea mai „îmbrăcată” în

O seară magică la Coloneşti
www.desteptarea.ro - Bacău
Primăria Coloneşti, sprijinită de elevii şi cadrele didactice de la Școala Gimnazială „Smaranda Apostoleanu”, a organizat „o seară magică” dedicată Centenarului Marii Uniri. Dintre activităţile desfăşurate în Coloneşti cele mai spectaculoase au fost parada copiilor şi localnicilor, însoţiţi de tineri călare pe cai, cu drapelele în mână, slujba de pomenire a eroilor neamului la monumentul …

Ziua Naţională a României, sărbătorită la IPJ Bacău
www.desteptarea.ro - Bacău
Poliţiştii Inspectoratului de Poliţie Judeţean Bacău au sărbătorit astăzi într-un cadru festiv 100 de ani de la Marea Unire din 1918. De Ziua Naţională a României, 13 agenţi şi 12 ofiţeri de poliţie din cadrul Inspectoratului de Poliţie Judeţean Bacău au fost avansaţi în gradul profesional următor, aceştia demonstrând profesionalism, cinste şi corectitudine în activităţile …

Un muzeu din Ungaria, acuzat că ar distorsiona imaginea Holocaustului
www.tion.ro - Timiş
Muzeul ”House of Fates” din Budapesta stârneşte controverse, unele persoane fiind de părere că acesta ar distorsiona realitatea Holocaustului. Deşi lucrările la muzeu s-au încheiat acum trei ani, acesta nu a fost deschis încă publicului.

COPIL-EROU. La numai 11 ani şi creşte singur surioara în vârstă de 1 an
portalsm.ro - Satu Mare
Papici Marcela, fost viceprimar al municipiului Satu Mare şi manager al Spitalului Judeţean, a publicat povestea vieţii nenorocite pe care o trăieşte un copil în vârstă de 11 ani. Micuţul îşi creşte singur sora, în vârstă de 11 ani.

Au mobilizat 5.000 de pompieri pe zi
evz.ro - Bucureşti
Peste 5.000 de pompieri vor fi zilnic la datorie în minivacanţa de 1 Decembrie, anunţă Inspectoratul General pentru Situaţii de Urgenţă....

Șoc pentru Liviu Dragnea! Ce se pregăteşte pe la spatele său-Apel către membrii PSD
evz.ro - Bucureşti
Șoc pentru Liviu Dragnea. Se cere demisia liderului PSD. Fostul senator PSD, Sorin Ilieşiu, face un apel cître toţi membrii PSD. Acesta îl consideră „cea ma...

Un nou contract semnat de Simona Halep
www.ziuaconstanta.ro - Constanţa
Simona Halep va incheia al doilea an pe prima pozitie in clasamentul WTA iar acest lucru ii aduce numai beneficii, scrie digisport.ro Daca pe plan sportiv, campioana noastra se afla inca in cautarea ...

Klaus Iohannis sare în APARAREA judecătoarei numită de el, în chestiunea completurilor de judecată: „Nu este niciun fel de problemă”
evz.ro - Bucureşti
Klaus Iohnnis a comentat joi la Cotroceni motivarea Curţii Constituţionale cu privire la compunerea completurilor de judecată, susţinând că instanţele vor a...

Trasee deviate în 1 Decembrie 2018
www.ebihoreanul.ro - Bihor
Sâmbătă, 1 Decembrie 2018, în Piaţa Unirii vor fi organizate o serie de manifestǎri publice dedicate Zilei Naţionale a României.

Adunarea Generala Ordinara a actionarilor societatii Brise Agricultura SA, convocata in sedinta. Ce subiecte sunt pe ordinea de zi
www.ziuaconstanta.ro - Constanţa
Consiliul de administratie al Brise Agricultura SA, cu sediul in municipiul Constanta, bd Mamaia nr.286, convoaca adunare generala ordinara a actionarilor pentru data de 20.12.2018, ora 10.00, la sediul ...

După Radio Omega, azi probleme mari şi la Acces TV! Ziua s-a terminat cu demisii şi cu un preaviz generalizat
www.gorjeanul.ro - Gorj
Televiziunea Accest TV din Târgu-Jiu şi-a trimis jurnaliştii acasă. Astăzi, toţi salariaţii au fost băgaţi în preaviz, iar trei dintre angajaţi şi-au dat demisia pe loc. Este vorba despre regizorul de emisie, sunetistul şi editorul de imagine, motivul fiind neîncasarea salariilor resta

După Radio Omega, azi probleme mari şi la Acces TV! Ziua s-a terminat cu demisii şi un preaviz generalizat
www.gorjeanul.ro - Gorj
Televiziunea Accest TV din Târgu-Jiu şi-a trimis jurnaliştii acasă. Astăzi, toţi salariaţii au fost băgaţi în preaviz, iar trei dintre angajaţi şi-au dat demisia pe loc. Este vorba despre regizorul de emisie, sunetistul şi editorul de imagine, motivul fiind neîncasarea salariilor resta

MOBILIZARE. Adolescent, în vârstă de 15 ani, dispărut de acasă!
portalsm.ro - Satu Mare
Era imbrăcat cu geaca bleumarin, blugi de culoare albastru deschis, iar în picioare purta converse, de culoare bej. Semnalmente: înălţime 1,70m; păr şaten, spre blond; ochi căprui; constiţutie atletică, fără semne particulare.

MOBILIZARE. Adolescent, în vârstă de 15 ani, dispărut de acasă!
portalsm.ro - Satu Mare
Era imbrăcat cu geaca bleumarin, blugi de culoare albastru deschis, iar în picioare purta converse, de culoare bej. Semnalmente: înălţime 1,70m; păr şaten, spre blond; ochi căprui; constiţutie atletică, fără semne particulare.

FOTO, VIDEO: “Steagul Unirii Diasporei cu ţara “ ajunge pe 1 Decembrie la Alba Iulia. Un banner cu 100 de steguleţe din ţările un trăiesc români, însoţeşte tricolorul
ziarulunirea.ro - Alba
“Steagul Unirii Diasporei cu ţara “ ajunge pe 1 Decembrie la Alba Iulia. Un banner cu 100 de steguleţe din ţările un trăiesc români, însoţeşte tricolorul. „Venim la Alba Iulia pe 1 Decembrie cu “ STEAGUL UNIRII DIASPOREI CU ȚARA “ şi bannerul pe care sunt cusute 100 de ţări unde se află românii noştri […]

Întâmplare TRAGICĂ în PENITENCIAR. Gestul EXTREM făcut de un DEȚINUT
evz.ro - Bucureşti
Un deţinut din Botoşani, în vârstă de 42 de ani, condamnat la 15 ani pentru viol, şi-a pus capăt zilelor după ce a evadat şi a fost prins....

Mesajul Vioricai Dancila catre laureatii galei '100 pentru Centenar'
www.ziuaconstanta.ro - Constanţa
Premierul Viorica Dancila le-a transmis laureatilor galei 100 pentru Centenar ca reprezinta adevarate exemple pentru ceilalti compatrioti, iar succesul lor este succesul Romaniei, scrie Antena3.ro. ...

"Magicienii Moşului": Spectacol de magie cu Eduard şi Bianca, la Filarmonica orădeană
www.ebihoreanul.ro - Bihor
Pe 5 decembrie, de la ora 18, la Filarmonica de Stat din Oradea, magicienii Eduard şi Bianca prezintă un spectacol de magie extraordinar pentru întreaga familie. 'Vino să vezi un stil de magie nou, modern în care tehnologia se împleteşte cu magia, iar elementele dintr-o simplă proiecţie video pot prinde viaţă', transmit organizatorii.

Sute de oameni salvaţi din nămeţi, maşini deblocate, drumuri desfundate. Cât a plătit CJ Constanţa pentru stăpânirea urgiei albe
evz.ro - Bucureşti
Consiliul Judeţean Constanţa a cheltuit, în mai puţin de 15 ore, aproape 200.000 de lei pentru deszăpezirea
drumurilor judeţene, în timpul codului galben ...

Acest bărbat ar putea fi criminalul în serie cu cele mai multe victime din SUA
www.tion.ro - Timiş
Samuel Little, un bărbat în vârstă de 78 de ani, condamnat pe viaţă la închisoare pentru uciderea a trei persoane, ar putea fi criminalul în serie cu cele mai multe victime din Statele Unite ale Americii. El a mărturisit că a ucis 90 de persoane, scăpând de fiecare dată. FBI îl crede.

300 de mineri de la Cariera Lupoaia continuă greva spontană!
www.gorjeanul.ro - Gorj
De la ora 7.00 până în prezent, la Cariera Lupoaia, aparţinând CE Oltenia, niciun salariat din producţie nu a intrat la muncă. Minerii, peste 300, stau încă în sala de apel, supăraţi că, primele discuţii cu reprezentanţii administraţiei, care au avut loc la ora 11.00 au eşuat. Salar

A FĂCUT INFARCT CÂND A VĂZUT PREŢURILE!
ziarulargesul.ro - Argeş
Ieri-dimineaţă, o femeie de 80 de ani a mers la un magazin alimentar situat în zona Pieţei Centrale din Cîmpulung. În timp ce era printre rafturi şi făcea cumpărături, i s-a făcut rău şi a căzut ca secerată în stare de inconştienţă, printre rafturile magazinului. Un echipaj SMURD sosit în scurt...

S-a AFLAT cine stă în SPATELE Pactului ONU pentru migraţie
evz.ro - Bucureşti
Guvernul german a înşelat publicul, declară liderul partidului populist de opoziţie, pentru Breitbart Londra, deoarece documentele interne ale Oficiului Fed...

Anunţul făcut de CFR! Se închide una dintre cele mai folosite linii
evz.ro - Bucureşti
Tronsonul de cale ferată Predeal-Braşov, una dintre cele mai folosite linii din România, se va închide pentru modernizări. CFR a demarat deja procedura de l...

Primele posibile cazuri de scarlatină din acest sezon în judeţul Alba. Recomandări pentru populaţie din partea DSP
ziarulunirea.ro - Alba
Primele posibile cazuri din acest sezon de scarlatină, boală contagioasă care se manifestă prin febră, dureri în gât şi erupţii roşii pe corp, au fost semnalate la copii din judeţul Alba. Acestea sunt considerate ”posibile” cazuri deoarece întrunesc criteriile clinice, iar testele la exsudatele faringiene recoltate nu au fost confirmate încă, fiind în lucru. Sunt […]

HC Dobrogea Sud i-a administrat liderului CSM Bucuresti prima infrangere stagionala si l-a detronat
www.ziuaconstanta.ro - Constanţa
Sala Sporturilor din Constanta a gazduit in aceasta seara derby-ul Ligii Nationale de handbal masculin, intre primele doua clasate, CSM Bucuresti si HC Dobrogea Sud Constanta. Partida a contat ...

Ce cadou a primit premierul Viorica Dăncilă de la preşedintele Consiliului Judeţean Alba, Ion Dumitrel
ziarulunirea.ro - Alba
Premierul Viorica Dăncilăa primit, joi, de la preşedintele Consiliului Judeţean Alba, Ion Dumitrel, un stilou inscripţionat cu mesajul „2004 aderarea Romaniei la NATO”, cu care a semnat în Cartea de Onoare. Ea a spus că îl va folosi când România va prelua Preşedinţia Consiliului Uniunii Europene. „Sper ca acest stilou să fie cel cu care […]

A FUGIT DE LUPI ŞI L-AU ÎNCOLŢIT CÂINII!
ziarulargesul.ro - Argeş
Un frumos exemplar de cerb carpatin a ajuns zilele trecute aproape de barajul Vidraru, după ce fusese hăituit de câţiva câini sălbăticiţi. Pădurarii şi jandarmii l-au zărit în vreme ce, epuizat, falnicul animal încerca să scape de atacatori. Din câte se pare, cerbul ar fi fost urmărit de lupi şi...

Vezi aici programul bancilor si oficiilor postale in minivacanta de 1 Decembrie
ph-online.ro - Prahova
Oficiile poştale şi unităţile bancare sunt închise vineri, 30 noiembrie, de Sfântul Andrei, şi sâmbătă, 1 decembrie, de Ziua Naţională a României, îns...

TVR, decizie RADICALĂ. CERINȚĂ ieşită din COMUN pentru JURNALIȘTI
evz.ro - Bucureşti
Televiziunea Română a trimis o notivicare, joi, prin care cere jurnaliştilor care au publicat sumele cheltuite la festivalul Cerbul de Aur 2018 să îşi dezvă...

Trump a anunţat că NU se va mai întâlni cu Putin, la summitul G20
evz.ro - Bucureşti
Preşedintele SUA Donald Trump a decis să anuleze întâlnirea pe care urma să o aibă cu preşedintele rus Vladimir Putin. Anunţul a fost făcut de Trump, pe Twi...

ANUNŢ PUBLITRANS pentru CIRCULAŢIA AUTOBUZELOR
ziarulargesul.ro - Argeş
Publitrans 2000 SA Piteşti informează publicul călător că, în perioada 30 noiembrie - 2 decembrie, circulaţia autobuzelor în municipiu se va desfăşura după un program specific zilelor de sărbătoare. În această perioadă vor circula şi autobuzele de pe linia Centru - Cimitirul "Sf. Gheorghe" cu...

Ministrul Șova recunoaşte înfrângerea: vine iarna pe şantierul lotului 4
www.tion.ro - Timiş
Sosit la Şoimuş să inspecteze situaţia de pe lotul 4 din Lugoj – Deva, ministrul Lucian Şova a recunoscut în sfârşit că... vine iarna. El nu a mai insistat cu terminarea lucrărilor şi a admis că pe şantier s-a muncit toată vara.

Ger de Ziua Naţională
www.jurnaldevrancea.ro - Vrancea
ANM a actualizat informarea meteorologică emisă anterior, având ca interval de valabilitate perioada 29 noiembrie, ora 14.00 – 2 decembrie, ora 10.00. | Jurnal de Vrancea

Mădălin Zamfir este noul şef al Centrului Operaţional
ziarulargesul.ro - Argeş
Subcomisarul Mădălin Ionuţ Zamfir, purtător de cuvânt al Poliţiei Judeţene Argeş, a fost declarat câştigător al concursului organizat de IGPR pentru funcţia de şef birou Centru Operaţional din cadrul poliţiei argeşene şi va avea ca atribuţii coordonarea structurii care monitorizează evenimentele...

Pregătiri în linie dreaptă pentru festivalul Florentin Delmar
www.jurnaldevrancea.ro - Vrancea
În perioada 12-13 decembrie va avea loc cea de-a 43 ediţie a Festivalului de Muzică Uşoară Românească FLORENTIN DELMAR, la Sala Mare a Ateneului Popular | Jurnal de Vrancea

Dăncilă, CONVOCATĂ la Cotroceni, pe tema amnistiei şi graţierii. Mesajul preşedintelui Iohannis către premier
evz.ro - Bucureşti
Preşedintele Klaus Iohannis a avut joi seară o poziţie fermă referitoare la o eventuală ordonanţă de urgenţă privind aministia şi graţierea, despre care spune că ar putea declanşa o criză politică fără precedent....

Bulevardul Unirii va fi închis sâmbătă pentru sărbătorirea Centenarului
www.jurnaldevrancea.ro - Vrancea
Cu ocazia Centenarului Marii Uniri, pe data de 1 Decembrie la Focşani vor fi mai multe manifestări dedicate acestui eveniment. Pentru buna desfăşurare a | Jurnal de Vrancea

Restrictia de tonaj pe DN 38, Agigea – Negru Voda (Vama) a fost ridicata
www.ziuaconstanta.ro - Constanţa
In urma interventiei drumarilor de la DRDP Constanta, circulatia rutiera pe DN 38, Agigea Negru Voda Vama , a fost redeschisa pentru toate categoriile de autovehicole, fara restrictii de tonaj, ...

Și de ninge, şi de plouă! Uzinele de apă ale Lugojului, pregătite pentru sezonul rece
expressdebanat.ro - Caraş-Severin
Societatea de distribuţie a apei, Meridian 22, a anunţat că a luat măsuri pentru asigurarea funcţionării în bune condiţii a celor trei uzine de apă ale Lugojului pe perioada sezonului rece.

Euro si dolarul au incheiat luna pe scadere
ziarmm.ro - Maramureş
Leul a avut luna aceasta o evolutie surprinzatoare, reusind sa se aprecieze fata de euro, in ciuda datelor economice fundamentale care indicau intrarea pe o panta descendenta. Cursul euro a scazut in

PSD vrea să dea "tunul" amnistiei şi graţierii. "Ar fi o catastrofă pentru România", avertizează Iohannis
www.ebihoreanul.ro - Bihor
Se pregăteşte o bombă cu efecte devastatoare! După înlăturarea adversarilor interni, liderul PSD, Liviu Dragnea, vrea să rezolve cât mai repede problema amnistiei şi graţierii, printr-o ordonanţă de urgenţă iniţiată de Carmen Dan, cu care ALDE nu este însă de acord. Adoptarea unei ordonanţe de urgenţă pe amnistie şi graţiere ar fi o catastrofă pentru România, a avertizat preşedintele Klaus Iohannis.

EXCLUSIV. Cum sunt "stoarse" de bani companiile profitabile de stat. CULISELE unei afaceri de câteva MILIARDE
evz.ro - Bucureşti
Guvernul a găsit o soluţie de moment, cât se poate de legală, prin care obligă companii de stat, între cele mai profitabile, să contribuie cu sume mari la b...

Decizia CCR care îngroapă VIITORUL POLITIC al lui Liviu DRAGNEA! O victorie cât o înfrângere.
evz.ro - Bucureşti
Liviu Dragnea nu are motive de bucurie pentru decizia CCR de astăzi. Chiar dacă ea pare o victorie, modul în care CCR a analizat extrem de dur maniera ICCJ ...

USR si-a ales candidatii la alegerile europarlamentare din mai 2019
ziarmm.ro - Maramureş
USR si-a ales candidatii la alegerile europarlamentare din mai 2019. Este pentru prima data cand intr-un partid din Romania votul s-a desfasurat transparent, printr-un sistem electronic securizat si v

Liceeni constanteni, prezenti la activitatea “Reunion de famille (galerie foto)
www.ziuaconstanta.ro - Constanţa
Astazi, in amfiteatrul Ghe. Coriolan al Colegiului National Mircea cel Batran , s-a desfasurat a XIII-a editie a activitatii Reunion de famille a claselor a IX-a cu profil bilingv-franceza din ...

Iohannis: O ordonanta privind amnistia si gratierea ar declansa o criza politica fara precedent
ziarmm.ro - Maramureş
Presedintele Klaus Iohannis a declarat joi ca o ordonanta privind amnistia si gratierea ar fi "o catastrofa pentru Romania" si ar declansa o criza politica fara precedent, informeaza AGERPRES. "O astf

Nici un vrâncean de la USR pe un loc eligibil la Europarlamentare
www.jurnaldevrancea.ro - Vrancea
USR şi-a desemnat candidaţii pentru alegerile europarlamentare, care vor avea loc anul viitor. Pe primele două locuri sunt Cristian Ghinea şi Clotilde | Jurnal de Vrancea

Momente de GROAZĂ la EXATLON! CUTREMURELE în LANȚ au pus CONCURENȚII în ALERTĂ
evz.ro - Bucureşti
Republica Dominicană a fost scena unor cutremure consecutive de pestre trei grade pe scara Richter. Evenimentele i-au făcut pe concurenţii de la Exatlon să ...

Simona Gherghe a făcut ANUNȚUL BOMBĂ! Ultimele detalii despre sarcină
evz.ro - Bucureşti
Prezentatoarea Tv Simona Gherghe este din nou însărcinată. Frumoasa vedetă a anunţat cu mare bucurie care va fi sexul bebeluşului....

Măsuri speciale de ordine publică de Ziua Naţională
www.jurnaldevrancea.ro - Vrancea
Aproximativ 258 jandarmi din cadrul IJJ Vrancea şi de la Gruparea de Jandarmi Mobilă Bacău, 55 poliţişti, 6 pompieri şi 9 poliţişti locali vor acţiona în | Jurnal de Vrancea

DOLIU în conducerea unei UNIVERSITĂȚI arădene
newsar.ro - Arad
Citeşte azi ce scriu ziarele de mâine!

Restrictii de circulatie pe DN1A in data de 1 decembrie
www.ziuaconstanta.ro - Constanţa
Centrul INFOTRAFIC din Inspectoratul General al Politiei Romane informeaza ca, potrivit Companiei Nationale de Administrare a Infrastructurii Rutiere, circulatia rutiera pe DN1A Ploiesti Brasov va fi ...

Prinţul Nicolae al României şi soţia sa, Alina, prezenţi la Alba Iulia de Ziua Naţională a României. Alături de ei va fi şi Indrei Raţiu, fiul omului politic Ion Raţiu
ziarulunirea.ro - Alba
Prinţul Nicolae al României, nepotul Regelui Mihai I şi soţia sa, Alina, vor fi la Alba Iulia cu ocazia Centenarului Marii Uniri. Alături de ei va fi prezent la evenimente şi Indrei Raţiu, fiul lui Ion Raţiu şi nepotul lui Augustin Raţiu, unul dintre cei 1.228 de delegaţi de la Alba Iulia, pe 1 decembrie […]

UNICEF: Circa 360.000 de adolescenti ar putea muri de SIDA pana in 2030
ziarmm.ro - Maramureş
Circa 360.000 de adolescenti ar putea muri de SIDA pana in 2030 daca investitiile facute in prevenirea HIV nu vor fi intensificate, avertizeaza un raport UNICEF publicat joi si citat de DPA, informeaz

Cum se lucrează de Sfântul Andrei la Primărie şi în instituţiile din subordine
www.jurnaldevrancea.ro - Vrancea
30 noiembrie este, pentru bugetari, zi liberă, conform Codului Muncii. Cu toate acestea, unii angajaţi ai Primăriei Focşani vor merge la lucru şi de ziua | Jurnal de Vrancea

Copil de 8 ani, in coma profunda dupa ce a fost spulberat de o masina
www.ziuaconstanta.ro - Constanţa
O fetita de doar 8 ani din Oradea este in stare critica, dupa ce a fost spulberata de o masina in timp ce incerca sa traverseze strada printr-un loc interzis, scrie Observator TV. Copila se intorcea ...

Iohannis RUPE TĂCEREA în cazul numirilor de miniştri. Răspuns DUR pentru PSD: „Eu respect ad-literam Constituţia”
evz.ro - Bucureşti
Preşedintele Klaus Iohannis a reacţionat joi, în legătură cu posibila sesizare a PSD la Curtea Constituţională în cazul numirilor noilor miniştri....

DECIZIA radicală a unei COMPANII AUTO. Ce se va întâmpla din 2019 cu MAȘINILE din EUROPA
evz.ro - Bucureşti
Unul dintre cei mai importanţi producători auto a anunţat că va renunţa, din 2019, la motoarele pe motorină. Măsura va fi implementată în Europa....

Până în anul 2020, toate clădirile din zona centrală a Oradiei vor fi reabilitate
www.ebihoreanul.ro - Bihor
Până în 2020 cel târziu, toate clădirile din centrul istoric ale Oradiei vor fi reabilitate. Municipalitatea va investi peste 22 milioane lei în refacerea unui număr de 16 imobile din zona centrală, precum şi a clădirii Colegiului Naţional Mihai Viteazul. Pe lista clădirilor pentru care Consiliul Local a aprobat joi indicatorii tehnico-economici ai lucrărilor de reafacere se numără casele Adorján I şi II din strada Patrioţilor, Ertler din strada Mihai Pavel 8, Füchsl din strada Independenţei sau hanul Arborele Verde din strada Vasile Alecsandri.

OTL vă urează la mulţi ani
www.ebihoreanul.ro - Bihor
Conducerea şi colectivul S.C. Oradea Transport Local S.A. vă urează La Mulţi Ani cu ocazia Zilei Naţionale a României şi a celebrării celor 100 de ani de la Marea Unire.

Un student spaniol, „deranjat” de jardinierele de pe Podul Michelangelo
www.tion.ro - Timiş
Un tânăr student din Spania s-a distrat în noaptea de miercuri spre joi cu jardinierele instalate pe Podul Michelangelo. Este doar una dintre multele persoane amendate de Poliţia Locală pentru distrugerea florilor.

Șase copii năascuţi la maternitatea Giuleşti au stafilococ
feedproxy.google.com
Opt copii internaţi la Spitalul Clinic de Urgenţă pentru Copii “Grigore Alexandrescu”. Dintre aceştia, şase au fost diagnosticaţi cu bacteria stafilococ

A inceput cosmarul pe DN1. Se circula bara la bara spre Valea Prahovei si pe Centura Ploiestiului
ph-online.ro - Prahova
Potrivit IJP Prahova, pe DN 1 traficul s a intensificat pe sensul catre Brasov, incepand de la Barcanesti, Centura de Vest Ploiesti si zona monta...

Rezultate loto 6 din 49, joi 29 noiembrie 2018
www.ziuaconstanta.ro - Constanţa
In aceasta seara au avut loc noi trageri Loto 6 49, Noroc, Joker, Noroc Plus, Loto 5 40 si Super Noroc, iar numerele extrase sunt urmatoarele Loto 6 49 3, 12, 27, 18, 9, 4 Joker 39, 37, 43, 44, 2 ...

Au avertizat că nu vor putea opri flageul. Vor muri sute de mii de copii
evz.ro - Bucureşti
Circa 360.000 de copii ar putea muri de SIDA până în 2030 dacă investiţiile făcute în prevenirea HIV nu vor fi intensificate, avertizează un raport UNICEF....

Jurnalistul Ion Cristoiu: „Doamna Tarcea ar trebui să demisioneze”
evz.ro - Bucureşti
Jurnalistul Ion Cristoiu a analizat motivarea Curţii Constituţionale privind completurile de cinci judecători, declarând că şefa ÎCCJ, Cristina Tarcea, ar t...

Nici un vrâncean de la USR pe un loc eligibil la Europarlamentare
www.jurnaldevrancea.ro - Vrancea
USR şi-a desemnat candidaţii pentru alegerile europarlamentare, care vor avea loc anul viitor. Pe primele două locuri sunt Cristian Ghinea şi Clotilde | Jurnal de Vrancea

Senatorii au dat liber la arme de foc. Aproape orice român poate deţine un pistol
ph-online.ro - Prahova
Un proiect de lege care prevede că aproape orice român va putea deţine arme letale cu glonţ a trecut deja de Senat. Dacă până în prezent puteau deţine...

Ion Cristoiu, despre motivarea CCR privind completurile: „Doamna Tarcea ar trebui să-şi dea demisia”
ph-online.ro - Prahova
Ion Cristoiu a comentat în emisiunea 100 de minute motivarea Curţii Constituţionale privind completurile de cinci judecători. Jurnalistul crede că şef...

Atentionare de calatorie in Republica Elena. Prognoza de ploi si furtuni
www.ziuaconstanta.ro - Constanţa
Ministerul Afacerilor Externe informeaza cetatenii romani care se afla, tranziteaza sau doresc sa calatoreasca in Republica Elena ca Serviciul de Meteorologie grec a transmis o atentionare de ...

FESTIVAL GASTRONOMIC la masa populară pregătită serbările Centenarului de la Alba Iulia. 4 oi la proţap şi 3 feluri de mâncare se vor distribui gratuit, în trei locuri din Cetatea Alba Carolina
ziarulunirea.ro - Alba
Românii de pretutindeni care vin de 1 Decembrie în Oraşul Marii Uniri, locul în care spiritul sărbătorii se simte mai bine ca oriunde, vor fi ospătaţi cu o masă populară la care vor fi servite, gratuit, 36.000 de porţii de mâncare. Surpriza pregătită de organizatori este că, în acest an, oamenii vor putea alege unul […]

România, sub invazia afganilor şi pakistanezilor! Vin de la nord, în adidaşi, prin zăpadă
evz.ro - Bucureşti
Nici nu s-a liniştit bine discuţia despre Pactul ONU pe migraţie, că a şi început migraţia. România, invadată în adidaşi!...

În primăvara şi toamna acestui an, ADP Oradea a plantat peste 2.000 de puieţi (FOTO)
www.ebihoreanul.ro - Bihor
Administraţia Domeniului Public Oradea a demarat, în primăvara acestui an, o campanie de plantări de puieţi la Grădina Zoologică, Cimitirul Municipal Rulikowski şi Adăpostul Grivei. Acţiunea a fost finalizată zilele trecute, în total fiind plantaţi 2.250 de arbuşti din specia paltin.

Dubla aniversare pentru Ilie Floroiu: 66 de ani de viata si un an de cand este consilierul primarului Constantei
www.ziuaconstanta.ro - Constanţa
Astazi este ziua lui Ilie Floroiu, a implinit 66 de ani. Este fostul director al Clubului sportiv Farul Constanta, si tot astazi are un an de zile de cand e consilierul primarului Decebal Fagadau pe ...

Ministerul Finanţelor propune ca pe tichetele cadou şi pe voucherele de vacanţă să fie tipărite numele şi CNP-ul
expressdebanat.ro - Caraş-Severin
Ministerul Finanţelor Publice (MFP) a pus în dezbatere publică astăzi, 29 noiembrie, un proiect de Hotărâre de Guvern privind Normele metodologice de aplicare a Legii nr. 165/2018, care prevede acordarea biletelor de valoare, norme care se vor aplica începând cu 1 ianuarie 2019, informează Mediafax.

OFTA TOTAL Sibiu – Tratamente complete pentru afecţiunile vederii
www.oradesibiu.ro - Sibiu
Vederea este simţul care ne conectează cel mai bine de lumea exterioară. De aceea, sănătatea ochilor este foarte importantă. Când intervine o problemă este bine să apelăm la cei mai buni specialişti oftalmologi. În Sibiu, clinica Ofta Total are grijă de ochii tăi de la o consultaţie competenta până la…

FC Hermannstadt – Concordia Chiajna de Ziua Naţională a României. ”Tati” vrea MUSAI o victorie
revistapresei.oradesibiu.ro - Sibiu
Echipa sibiană joacă, sâmbătă, 1 decembrie, de la ora 14:00, pe Stadionul ”Trans-Sil” din Tg. Mureş, cu Concordia Chiajna, în etapa a XVII-a a Ligii 1. În tur, ilfovenii au câştigat cu 2-0. FC Hermannstadt este neînvinsă în ultimele 4 etape de campionat, în care a adunat 10 puncte din…

MOTIVUL incredibil al unui INCENDIU PUTERNIC. Câţi ANI de ÎNCHISOARE riscă autorul. VIDEO
evz.ro - Bucureşti
Incendiul care a cuprins Arizona, SUA, anul trecut a fost cauzat de un bărbat care dorea să dezvăluie invitaţilor sexul copilului său....

Exclusiv! Toţi clienţii ING sunt vizaţi. Ce se întâmplă cu conturile lor
evz.ro - Bucureşti
ING Bank a trimis, astăzi, o informare către clienţii săi prin care anunţă modificări la conturile ING Economii.
...

ÎN DIRECT Ședinţă la Consiliul Local Bod
feedproxy.google.com - Braşov
La această orăc, consilierii locali din Bod sunt reuniţi în plen. Iată ce discută, în clipul de mai jos. Share pe FacebookTwitterGoogle+Linkedin

O fetiţă este în comă, după ce a fost lovită de o maşină lângă Parcul Salca
www.ebihoreanul.ro - Bihor
O fetiţă în vârstă de 8 ani din Oradea a ajuns în comă, la spital, după ce a fost lovită de maşină pe strada Meiului, de lângă Parcul Salca. Micuţa este în stare foarte gravă, intrând direct în sala de operaţie.

Lizuca, Patrocle, Scufiţa Roşie şi Gulliver la final de an pe scena de la Gong
www.oradesibiu.ro - Sibiu
Teatrul pentru Copii şi Tineret „Gong” Sibiu încheie programul din acest an cu spectacolele „Dumbrava minunată” în regia lui Gabriel Apostol, „Scufiţa Roşie” în regia lui Diego Aramburo şi „Cel mai mare Gulliver” în regia lui Alexandru Dabija. Una dintre cele mai emoţionante poveşti din literatura românească prinde viaţă într-o…

Tânăr din Avrig închis la Sibiu pentru ultraj
www.oradesibiu.ro - Sibiu
Poliţiştii din cadrul Poliţiei Oraşului Avrig au identificat şi prins un bărbat în vârstă de 34 de ani, din Avrig, pe numele căruia Judecătoria Turda a emis mandat de executare a pedepsei închisorii. Bărbatul a fost condamnat la o pedeapsă de un an închisoare pentru săvârşirea infracţiunii de ultraj. Persoana în…

Jurnalist BBC, şocat de masacrul din pădurile din România: „Defrişarea e evidentă”
www.oradesibiu.ro - Sibiu
Defrişările masive din Parcul Naţional Domogled Valea Ccernei, loc în care se află una dintre ultimele mari păduri de fag din Europa, sunt subiect de discuţie şi în presa străină. Un jurnalist BBC a vizitat meleagurile româneşti şi a rămas şocat de defrişarea mult prea evidentă. Potrivit BBC, doar jumătate…

FOTO Bustul lui Alexandru Vaida Voevod, dezvelit în parcul Astra
www.oradesibiu.ro - Sibiu
Primăria Municipiului Sibiu a dezvelit joi, 29 noiembrie, bustul lui Alexandru Vaida Voevod, vicepreşedinte al Consiliului Dirigent şi prim-ministru în primul Guvern al României Mari, o personalitate marcantă, cu o contribuţie importantă în realizarea Marii Uniri. „Am realizat acest bust în cadrul programului de manifestări dedicate Centenarului Marii Uniri. Cu…

DRAGNEA, probleme MEDICALE. NU va participa la evenimentele de CENTENAR. Mesajul liderului PSD
evz.ro - Bucureşti
Preşedintle PSD, Liviu Dragnea, a anunţat că va lipsi de la evenimentele dedicate Zilei Naţionale a României, invocând probleme de sănătate....

Recordurile româneşti în Cupele Europene (P)
evz.ro - Bucureşti
Chiar dacă nicio echipă din Liga 1 Betano nu este prezentă în grupele cupelor europene din acest sezon, România e la loc de cinste în fotbalul continental. ...

Anunţ CRUNT de la meteorologi! Vine URGIA în acest weekend. Unde va fi CEL MAI FRIG
evz.ro - Bucureşti
Iarna a început să se impună din ce în ce mai mult în România, temperaturile negative fiind deja cele care persistă în majoritatea regiunilor ...

FOTO: Zeci de poliţişti din Gorj au donat sânge
www.gorjeanul.ro - Gorj
40 de poliţişti din judeţul Gorj au trecut, astăzi, pragul Centrului de Transfuzie Sanguină, din Târgu-Jiu, pentru a dona sânge. Acţiunea face parte din campania ”100 de poliţişti donează sânge, pentru viaţă”. Poliţiştii au avut iniţiativa, ca, pe lângă principala lor

CJ Alba, pregătit să plătească până la 5,7 milioane de lei pentru întreţinere pe timp de iarnă a drumurilor judeţene
ziarulunirea.ro - Alba
Consiliul Judeţean Alba a lansat invitaţia la procedura de negociere fară publicarea prealabilă a unui anunţ de participare pentru atribuirea contractului având ca obiect „întreţinere curentă pe timp de iarnă a drumurilor judeţene din judeţul Alba”, în iarna 2018- 2019. Contractul este împărţit pe două loturi – zona de şes a judeţului cuprinzând drumurile judeţene […]

Inspectoratul Școlar Judetean Constanta: Care au fost premiantii concursului La Centenar, tinerii dezbat (galerie foto)
www.ziuaconstanta.ro - Constanţa
In perioada 28-29.11.2018, la Liceul Teoretic Traian si in sala Remus Opreanu - Palatul Administrativ Constanta, s-a desfasurat Concursul judetean La Centenar, tinerii dezbat , organizat de Institutia ...

Încă două zile în care puteţi vota Festivalul AWAKE la European Festival AWARDS!
www.zi-de-zi.ro - Mureş
Festivalul AWAKE a fost nominalizat la European Festival AWARDS la categoria Best Medium-Sized Festi

Bugetarea participativă a ajuns la final – Nouă proiecte de la sibieni, pentru sibieni
revistapresei.oradesibiu.ro - Sibiu
Programul de bugetare participativă 2018 se va încheia în 30 noiembrie cu publicarea proiectelor care au fost selectate în etapa finală de vot, Primăria Sibiu urmând să aloce fonduri din bugetul local şi să le implementeze. Acestea pot fi consultate pe site-ul programului https://bugetareparticipativa.sibiu.ro/. Scurtă descriere a proiectelor selectate, în…

OFTA TOTAL Sibiu – Tratamente complete pentru afecţiunile vederii
revistapresei.oradesibiu.ro - Sibiu
Vederea este simţul care ne conectează cel mai bine de lumea exterioară. De aceea, sănătatea ochilor este foarte importantă. Când intervine o problemă este bine să apelăm la cei mai buni specialişti oftalmologi. În Sibiu, clinica Ofta Total are grijă de ochii tăi de la o consultaţie competenta până la…

Mihai Trăistariu nu mai are nicio limită a ruşinii sau a decenţei! S-a pozat gol puşcă 100%, cu zonele intime la vedere! Detaliul şocant observat de fani
ph-online.ro - Prahova
Mihai Trăistariu o comite din nou, demonstrând că rămâne acelaşi artist nonconformist care stârneşte polemici în urma apariţiilor din mediul online. D...

1 Decembrie, la Ploiesti. Vezi aici programul complet al evenimentelor de Ziua Nationala
ph-online.ro - Prahova
Primăria Municipiului Ploieşti şi Garnizoana Ploieşti invită ploieştenii să participe la acţiunile organizate, în municipiul nostru, cu prilejul Zilei...

Un MILIARDAR polonez A DAT LOVITURA în România. A cumpărat o reţea de MAGAZINE
evz.ro - Bucureşti
Miliardarul Michał Sołowow (56 de ani), fost pilot de raliuri şi al doilea cel mai bogat polonez, a cumpărat firma care gestionează cele 21 de magazine Prog...

Ministerul Sănătăţii anunţă că ÎNCHIDE Maternitatea Giuleşti: Mai mulţi angajaţi au stafilococ auriu
ph-online.ro - Prahova
UPDATE Toate maternităţile din ţară vor fi controlate, după scandalul copiilor născuţi la Maternitatea Giuleşti, care au ajuns cu infecţii stafilocice...

Satu Mare, ca-n poveşti! Municipiul se îmbrăcă cu luminiţe de Crăciun. Programul evenimentului
portalsm.ro - Satu Mare
Satu Mare, ca-n poveşti! Municipiul se îmbrăcă cu luminiţe de Crăciun. Programul evenimentului

Galaţi 4X4 Salvare – Recuperare, Moş Nicolae pentru copiii nevoiaşi
feedproxy.google.com
Galaţi 4X4 Salvare – Recuperare şi-a propus să fie Moş Nicolae pentru 50 de copii nevoiaşi. Astfel, aceştia au început să pregătească punguţele

FOTO Centenarul Marii Uniri, sărbătorit la Biblioteca ASTRA din Sibiu
www.oradesibiu.ro - Sibiu
Biblioteca Judeţeană ASTRA Sibiu organizează un vernisaj al expoziţiei tematice şi la prezentarea albumelor documentare dedicate Marii Uniri, sâmbătă, 1 decembrie, începând cu ora 12.30. Acest eveniment va avea loc la Biblioteca Judeţeană ASTRA Sibiu, în Muzeul Asociaţiunii din str. George Bariţiu, nr. 5, et. 1, începând cu ora 12:30…

Tânăr din Cisnădie, prins beat la volan pe Calea Dumbrăvii
www.oradesibiu.ro - Sibiu
La data de 28 noiembrie a.c., poliţiştii Biroului Rutier Sibiu au reţinut un bărbat, cercetat penal pentru săvârşirea de infracţiuni la regimul rutier. În fapt, la data de 12 noiembrie a.c., în jurul orei 03,30, în municipiul Sibiu, bărbatul în vârstă de 26 de ani, din Cisnădie, a fost depistat…

Bonusurile angajaţilor de sărbători – Ce „cadouri” oferă companiile
www.oradesibiu.ro - Sibiu
Sărbătorile de iarnă sunt tot mai aproape, iar angajatorii se gândesc cum ar putea să-şi răsplătească angajaţii pentru munca depusă de-a lungul anului. Cele mai multe dintre companii aleg să ofere bonusuri şi tichete cadou. Tichetele cadou sunt deja în lucru pentru companiile care aleg să ofere acest tip de…

FOTO Zeci de saci cu donaţii ajung în judeţul Sibiu – Darurile vin tocmai de la Galaţi
www.oradesibiu.ro - Sibiu
O caravană filantropică, pornită din Galaţi cu destinaţia Alba Iulia, se opreşte în data de 30 noiembrie şi în judeţul Sibiu, pentru a lăsa mai multe pachete cu donaţii la Centrul de Plasament Orlat. Caravana „Galaţiul Dăruieşte De Centenar” este iniţiată de comunitatea RO100 Curăţăm Galaţiul cu sprijinul RO100 Sibiu,…

Spitalul din Năsăud a primit un computer tomograf adus tocmai de la Vatican (FOTO)
www.timponline.ro - Bistriţa-Năsăud
Pacienţii de pe Valea Someşului Mare vor putea fi diagnosticaţi mult mai bine. Spitalul "George Trifon" din Năsăud a primit un computer tomograf donat tocmai din Vatican, o premieră pentru unitatea medicală ameninţată nu cu mult timp în urmă cu închiderea. Oficiali italieni au fost prezenţi astăzi l

Simona Halep a pornit o nouă afacere. Cu ce se mai ocupă sportiva
www.stiridecluj.ro - Cluj
Simona Halep încheie anul pe locul 1 în clasamentul WTA, îns...

Premierul Dăncilă DĂ ȘAH OPOZIȚIEI. Mişcarea PERVERSĂ ce poate NĂRUI planurile celor ce vor CĂDEREA GUVERNULUI PSD-ALDE
evz.ro - Bucureşti
Premierul Viorica Dăncilă a cerut să vorbească în Parlament pe 12 decembrie, chiar la data la care PNL a anunţat că va depune moţiune de cenzură....

Iohannis, DECLARAȚII ȘOCANTE! ATAC FĂRĂ PRECEDENT la adresa Guvernului: „Românii sunt SECHESTRAȚI în interiorul graniţelor”
evz.ro - Bucureşti
Preşedintele Klaus Iohannis a reacţionat dur la propunerea ministrului Eugen Teodorovici de a limita la cinci ani dreptul românilor de a lucra într-o ţară m...

Care este situatia traficului la aceasta ora in judetul Constanta si in judetele limitrofe
www.ziuaconstanta.ro - Constanţa
Potrivit DRDP Constanta, in judetul Constanta, pe autostrada A2 si pe autostrada A4 este partial umed uscat Pe DN2A este partial umed zapada framantata 1cm.,DN22A partial umed partial uscat ...

Floreştiul inaugurează cel mai înalt catarg din Transilvania - VIDEO
www.stiridecluj.ro - Cluj
Floreştiul inaugurează cel mai înalt catarg din Transilvania - VIDEO

Poliţiştii şi militarii pot utiliza banii de chirie pentru ratele de locuinţe
www.stiridecluj.ro - Cluj
Preşedintele Klaus Iohannis a semnat, joi, decretul pentru modificarea legilor privind st...

FOTO Bustul lui Alexandru Vaida Voevod, dezvelit în parcul Astra
revistapresei.oradesibiu.ro - Sibiu
Primăria Municipiului Sibiu a dezvelit joi, 29 noiembrie, bustul lui Alexandru Vaida Voevod, vicepreşedinte al Consiliului Dirigent şi prim-ministru în primul Guvern al României Mari, o personalitate marcantă, cu o contribuţie importantă în realizarea Marii Uniri. „Am realizat acest bust în cadrul programului de manifestări dedicate Centenarului Marii Uniri. Cu…

Mesajul dur al Academiei Române pentru liderii statului
www.stiridecluj.ro - Cluj
Academia Română a transmis un mesaj dur prin cae le cere instituţiilor statulu...

ADIO moţiune de cenzură! MUTAREA DECISIVĂ a premierului Dăncilă. Opoziţia este ÎN CORZI
evz.ro - Bucureşti
Premierul Viorica Dăncilă a cerut să vorbească în Parlament pe 12 decembrie, chiar la data la care PNL a anunţat că va depune moţiune de cenzură....

Fostul ministrul “genunche” şi-a angajat soţia la un important Minister-Ce funcţie ocupă aceasta
evz.ro - Bucureşti
Fostul ministrul “genunche” şi-a pus soţia foarte bine. Aceasta ocupă, din vară, o funcţie într-unul din ministere. Chiar Liviu Pop a făcut ace...

S-a AFLAT cine stă în SPATELE Pactului ONU pentru migraţie
evz.ro - Bucureşti
Guvernul german a înşelat publicul, declară liderul partidului populist de opoziţie, pentru Breitbart Londra, deoarece documentele interne ale Oficiului Fed...

Mesajul neaşteptat al părintelui Arsenie Boca despre post
www.stiridecluj.ro - Cluj
Mesajul neaşteptat al părintelui Arsenie Boca despre post

FOTO Zeci de saci cu donaţii ajung în judeţul Sibiu – Darurile vin tocmai de la Galaţi
revistapresei.oradesibiu.ro - Sibiu
O caravană filantropică, pornită din Galaţi cu destinaţia Alba Iulia, se opreşte în data de 30 noiembrie şi în judeţul Sibiu, pentru a lăsa mai multe pachete cu donaţii la Centrul de Plasament Orlat. Caravana „Galaţiul Dăruieşte De Centenar” este iniţiată de comunitatea RO100 Curăţăm Galaţiul cu sprijinul RO100 Sibiu,…

Fără KFC la Alba Iulia, de 1 Decembrie. Restaurantul se deschide doar în 4 decembrie
ziarulunirea.ro - Alba
Albaiulienii nu vor avea ”pui american” de la KFC, de 1 Decembrie. Potrivit unor surse, fast-food-ul se deschide numai în data de 4 decembrie. Lucrările de amenajare a spaţiului la restaurantul KFC din centrul comercial Alba Mall sunt aproape finalizate, însă cu toate acestea nu este posibilă deschiderea până la 1 Decembrie şi, se pare, […]

Scoala Gimnaziala Nr. 1 din Cuza Voda, judetul Constanta angajeaza ingrijitor copii
www.ziuaconstanta.ro - Constanţa
Scoala Gimnaziala Nr. 1 din Cuza Voda, Judetul Constanta organizeaza concurs pentru ocuparea pe perioada determinata de 1 an si 10 luni in cadrul proiectului Masuri integrate pentru comunitate POCU ...

MATERNITATEA Giuleşti va fi ÎNCHISĂ! Mesajul ministrului SĂNĂTĂȚII. BREAKING NEWS
evz.ro - Bucureşti
Ministrul Sănătăţii, Sorina Pintea, a declarat că Maternitatea Giuleşti va fi închisă, după ce un control a descoperit că mai mulţi angajaţi au stafilococ a...

Festivitate la IPJ Bistriţa-Năsăud, cu ocazia Centenarului
www.timponline.ro - Bistriţa-Năsăud
Împlinirea a 100 de ani de la înfăptuirea Marii Uniri a fost marcată la sediul Inspectoratului de Poliţie Judeţean Bistriţa-Năsăud printr-o şedinţă festivă.
”Şedinţa a debutat solemn, cu intonarea Imnului Naţional al României. Pe tot parcursul acesteia, au fost proiectate imagini din activităţile

Bonusurile angajaţilor de sărbători – Ce „cadouri” oferă companiile
revistapresei.oradesibiu.ro - Sibiu
Sărbătorile de iarnă sunt tot mai aproape, iar angajatorii se gândesc cum ar putea să-şi răsplătească angajaţii pentru munca depusă de-a lungul anului. Cele mai multe dintre companii aleg să ofere bonusuri şi tichete cadou. Tichetele cadou sunt deja în lucru pentru companiile care aleg să ofere acest tip de…

"Colindător la porţile cerului": Fuego concertează pe 6 decembrie la Oradea
www.ebihoreanul.ro - Bihor
În seara de 6 decembrie, Fuego va colinda la Oradea, pe scena Casei de Cultură a Sindicatelor. Biletele pentru concertul lui Fuego, intitulat 'Colindător la porţile cerului', au fost puse în vânzare pe site-ul blt.ro.

Klaus Iohannis face ceremonie pentru o promulgarea unei legi
www.ziuaconstanta.ro - Constanţa
Premiera in Romania Klaus Iohannis organizeaza o ceremonie publica pentru a promulga o lege!, scrie Antena 3.ro. Mai exact, este vorba despre legea initiata in Parlament si care obliga Guvernul sa ...

Program Cinema Inspire Alba Mall. Ce filme vor rula în perioada 30 noiembrie – 6 decembrie 2018
ziarulunirea.ro - Alba
Programul Inspire Cinema Alba Iulia, pentru perioada 30 noiembrie – 6 decembrie 2018. Ce filme vor rula la cinematograful din centrul comercial Alba Mall. Mortal Engines 3D / Maşinării infernale Regia: Christian Rivers Cu: Hugo Weaving, Robert Sheehan, Stephen Lang, Jihae, Hera Hilmar Gen Film: Actiune, Fantastic, SF, Thriller Durată: 133 min Rating: AP12 IMDB: […]

Producătorul de mezeluri Agra’s din Alba: Sunt optimist pentru următorii ani şi continuăm investiţiile
ziarulunirea.ro - Alba
Producătorul de mezeluri Agra’s din judeţul Alba, controlat de antreprenorii locali Dan Sărmăşan şi Sanda Stăncel, şi-a bugetat o creştere a cifrei de afaceri de sub 10% faţă de anul precedent şi este posibil să depăşească pragul de 100 de milioane de lei ca vânzări. „Lucrurile sunt foarte bine puse la punct, este loc şi […]

TAROM, oferta speciala de Centenar: Bilete mai ieftine cu 20% pe rutele interne
ziarmm.ro - Maramureş
Compania aeriana nationala TAROM anunta discounturi de 20% la pretul biletelor achizitionate pentru rutele interne, in perioada 29 noiembrie - 1 decembrie, oferta lansata cu ocazia Centenarului, infor

Doua institutii unice din Romania vizitate, in premiera, de marinarii militari (galerie foto)
www.ziuaconstanta.ro - Constanţa
Potrivit navy.ro, un grup de militari din Fortele Navale Romane a vizitat, in premiera, miercuri, 28 noiembrie, doua institute din Magurele, care au inscris cateva recorduri deosebite in paginile de istorie ...

LA MULȚI ANI ANDREI ȘI ANDREEA! Cele mai frumoase urări şi mesaje de Sfântul Andrei pentru cei dragi
ziarulunirea.ro - Alba
Cele mai frumoase mesaje, felicitări şi urări de ”la mulţi ani pentru Andrei sau Andreea şi pentru alte nume derivate care îşi sărbătoresc onomastica de Sfântul Andrei. Pe 30 noiembrie este prăznuit Sfântul Andrei, ocrotitorul românilor. Peste 600.000 de români îşi serbează ziua numelui cu aceasă ocazie. Iată ce mesaje de Sfântul Andrei poţi trimite, […]

FOTO. Marcaje rutiere pe Podul Decebal din municipiul Satu Mare
portalsm.ro - Satu Mare
Marcaje rutiere pe Podul Decebal din municipiul Satu Mare. După câteva luni de absenţă a marcajelor rutiere, o firmă specializată a început demararea lucrărilor în acest sens.

ATENŢIE! Capitala, dată peste cap. Avem TOATE modificările liniilor de autobuz
evz.ro - Bucureşti
În zilele de 30 Noiembrie şi 1 Decembrie, liniile de transport public vor funcţiona după un program de circulaţie corespunzător unei zile de duminică. STB (...

DOLIU în ROMÂNIA! Un lider POLITIC important a MURIT
evz.ro - Bucureşti
Fostul parlamentar de Vaslui, Vasile Mihalachi, a murit joi, la vârsta de 70 de ani. El a fost şi preşedintele Consiliului Judeţean Vaslui....

Cazul care a CUTREMURAT lumea ştiinţifică! Experiment GENETIC pe bebeluşi. Cum s-au născut gemenele Nana şi Lulu
evz.ro - Bucureşti
Cazul care a CUTREMURAT lumea ştiinţifică! Experiment GENETIC pe bebeluşi. Cum s-au născut gemenele Nana şi Lulu...

Aproape 1.200 de posturi vacante la Cluj, la final de lună
www.stiridecluj.ro - Cluj
Potrivit datelor Agenţiei Naţionale pentru Ocuparea Forţei de Muncă (ANOFM), la nivel ...

Neamţ: Mădălina Ciubotaru şi-a dat demisia din funcţia de consilier judeţean
www.stiri-neamt.ro - Neamţ
Mădălina Ciubotaru (PSD) şi-a dat demisia astăzi, 29 noiembrie, din funcţia de consilier judeţean. „În perioada următoare mă voi implica în umele proiecte

Viorica Dăncilă huiduită la Alba Iulia: Ruşine să vă fie - VIDEO
www.stiridecluj.ro - Cluj
Viorica Dăncilă huiduită la Alba Iulia: Ruşine să vă fie - VIDEO

Acces gratuit in mai multe institutii din Constanta, cu ocazia zilei de 1 Decembrie
www.ziuaconstanta.ro - Constanţa
Cu ocazia zilei de 1 decembrie, Ziua Romaniei, in institutiile din subordinea Consiliului Judetean Constanta accesul va fi gratuit. Astfel, la Complexul Muzeal de Stiinte ale Naturii, respectiv ...

Cristina Neagu, înaintea DEBUTULUI la Campionatul European: „Nu mă gândesc prea mult la lucrurile astea”. Care este cea mai mare dorinţă a vedetei handbalului feminin
evz.ro - Bucureşti
Cristina Neagu a declarat că nu pune mare preţ pe titlurile individuale pe care le-a primit de-a lungul carierei şi visează să câştige o medalie de aur....

IRANUL a FĂCUT anunţul! SUBMARINELE sunt pregătite şi gata să lanseze RACHETE
evz.ro - Bucureşti
Comandantul Forţelor navale din Iran, amiralul Moytaba Mohamadi, a anunţat că Iranul a adăugat flotei sale din Golful Persic încă două submarine capabile să...

Peste 700 de poliţişti la datorie pentru minivacanţa de 1 Decembrie
www.tion.ro - Timiş
Desfăşurare de forţe, la nivelul întregului judeţ, în minivacanţa de 1 decembrie. Peste 700 de poliţişti vor fi la datorie şi vor acţiona atât pe linie de ordine publică, cât şi pe linie rutieră.

Marea Unire prin ochii copiilor la SPS Codlea
feedproxy.google.com - Braşov
Elevii Şcolii Profesionale Speciale Codlea au rememorat prin momente deosebite, reunite în proiectul „Românaşii de astăzi”, actul Marii Uniri de la 1918, sărbătorind 100 de ani de la marele eveniment. Copiii, alături de profesorii coordonatori: prof. Lungoci Maria Valentina, prof. Urs Simona şi prof. Durbacă Alina, cu sprijinul dnei. director Grecu Claudia, au pus în

Va ninge la Cluj, de 1 Decembrie? Ce anunţă meteorologii
www.stiridecluj.ro - Cluj
Meteorologii de la ANM anunţă un sfâşit de săptămână deosebit de...

Un nou cod galben de vreme rea pentru judetele Constanta si Tulcea. Cat va dura
www.ziuaconstanta.ro - Constanţa
Administratia Nationala de Meteorologie a emis in aceasta seara cod galben de vant puternic valabil in perioada 29-11-2018 ora 17 00 pana la 29-11-2018 ora 23 00. Este vizat judetul Constanta si ...

SUTE DE MII DE ROMÂNI primesc 5.000 de euro
evz.ro - Bucureşti
Guvernul României a semnat astăzi un acord cu Federaţiile Sindicale Reprezentative din Învăţământ, prin care Executivul se angajează să ia măsuri de sprijin...

ALDE DOLJ: ZECE DOLJENI DE NOTA 100
www.oltenasul.ro - Dolj
Related Posts via CategoriesSenatorul Lavinia Craioveanu participă la “Forumul Global al Femeilor Lider”Alexandra Presură, propunere legislativă pentru copiii ce nu deţin cod numeric personalDeputat PSD Dolj, Alina-Elena TĂNĂSESCU: Cabinetele medicilor de familie, cele de medicină dentară, ambulatoriile de specialitate, exceptate de la prevederile Legii nr. 185/2017ALDE DOLJ: REAFIRMĂM NEVOIA UNUI ”ARMISTIȚIU”POLITICALDE DOLJ: TINERII DIN ALDE CAUTĂ SOLUȚII INTELIGENTE PENTRU MODERNIZAREA […]

MEGA SHOW. Trupe internaţionale în Poiana Golului, la Zilele Reşiţei 2019!
expressdebanat.ro - Caraş-Severin
Cel puţin 4 trupe internaţionale şi 20.000 de oameni. Aşa vor arăta Zilele Reşiţei anul viitor. Primul pas a fost făcut chiar astăzi. Zilele Reşiţei 2019 sau Custom Reşiţa, aşa cum se numeşte evenimentul începând din acest an, se anunţă unul cu expunere internaţională, susţine primarul Ioan Popa. Și asta pentru că sunt discuţii avansate…

Dorel a asfaltat roţile unei maşini în Floreşti - FOTO
www.stiridecluj.ro - Cluj
Dorel a asfaltat roţile unei maşini în Floreşti - FOTO

Ministrul Educatiei, Ecaterina Andronescu anunta schimbari pentru liceeni
www.ziuaconstanta.ro - Constanţa
Ministrul Educatiei, Ecaterina Andronescu, a afirmat joi, la Alba Iulia, ca va fi crescuta cifra de scolarizare la scolile profesionale si ca se va cauta sa fie gasita o forma de liceu tehnologic ...

Avertisment din partea meteorologilor! Urmează trei zile de ger în toată ţara
www.stiridecluj.ro - Cluj
Meteorologii de la ANM au emis un avertisment de vreme rea, care afectează aproximativ to...

SURPRIZĂ de proporţii la Hollywood! Un regizor URIAȘ a luat DECIZIA VIEȚII. Fanii sunt ULUIȚI
evz.ro - Bucureşti
Regizorul american Quentin Tarantino s-a căsătorit cu actriţa şi top-modelul israelian Daniella Pick. Cei doi s-au căsătorit miercuri în SUA....

SURPRIZĂ de proporţii la Hollywood! Un regizor URIAȘ a luat DECIZIA VIEȚII. Fanii sunt ULUIȚI
evz.ro - Bucureşti
Regizorul american Quentin Tarantino s-a căsătorit cu actriţa şi top-modelul israelian Daniella Pick. Cei doi s-au căsătorit miercuri în SUA....

Castelul Huniade, tot cu porţile închise. Fără recepţia lucrărilor nu se pot accesa fonduri
www.tion.ro - Timiş
Castelul Huniade (Muzeul Naţional al Banatului) este în renovare de peste 10 ani. Porţile acestui castel din centrul Timişoarei rămân încă închise, deşi anul 2021 va pune Timişoara pe harta capitalelor culturale europene. Este posibil ca până în acel an să se deschidă o parte din castel şi curtea interioară. Este posibil...

Jurnalist BBC, şocat de masacrul din pădurile din România: „Defrişarea e evidentă”
revistapresei.oradesibiu.ro - Sibiu
Defrişările masive din Parcul Naţional Domogled Valea Ccernei, loc în care se află una dintre ultimele mari păduri de fag din Europa, sunt subiect de discuţie şi în presa străină. Un jurnalist BBC a vizitat meleagurile româneşti şi a rămas şocat de defrişarea mult prea evidentă. Potrivit BBC, doar jumătate…

Bradul din Parcul Mare din Gherla, parcă e dintr-un film horror - FOTO
www.stiridecluj.ro - Cluj
Bradul din Parcul Mare din Gherla, parcă e dintr-un film horror - FOTO

VIDEO. Avioane MIG şi elicoptere Puma deasupra Sătmarului
portalsm.ro - Satu Mare
Avioane MIG şi elicoptere Puma deasupra Sătmarului

Comunicat ANOFM: 787 de job-uri, vacante în Gorj!
www.gorjeanul.ro - Gorj
Potrivit datelor furnizate de agenţii economici privind locurile de muncă vacante, în evidenţele Agenţiei Naţionale pentru Ocuparea Forţei de Muncă (ANOFM) sunt înregistrate 30.946 locuri de muncă, în data de 29 noiembrie 2018.Situaţia locurilor de muncă vacante, în fiecare judeţ:

CLAY – Un nou proiect Interreg Europe care susţine competitivitatea întreprinderilor din sectorul ceramicii artistice
www.oltenasul.ro - Dolj
Related Posts via CategoriesIstorie şi viitor, la Ziua BucovineiAcord pentru dezvoltarea domeniului construcţiilorAcord pentru susţinerea educaţieiGuvernul instituie un mecanism de economisire pentru copii care să le faciliteze accesul la educaţieConcurs de afişe “Reciclăm pentru natură” pentru liceeniProiectele de acte normative care ar putea fi incluse pe agenda şedinţei Guvernului României din 29 noiembrie 2018Senatorul Lavinia Craioveanu participă la “Forumul Global […]

Simbolul Bistriţei, decorat de Centenar (FOTO)
www.timponline.ro - Bistriţa-Năsăud
Turnul Bisericii Evanghelice din Bistriţa, cel mai important monument istoric al oraşului, a fost decorat pentru Ziua Naţională a României.
Balconul de la înălţime a fost înconjurat cu steagul tricolor, iar pe cele patru laturi ale turnului a fost pus logo-ul Centenarului Marii Uniri: ”Român

Mesaj DUR din Parlamentul European pentru GUVERNUL Dăncilă: „România are şanse mai mici”
evz.ro - Bucureşti
Guvernul român are o mare responsabilitate în a lua măsuri adecvate pentru consolidarea statului de drept şi combaterea corupţiei, a declarat candidatul PPE...

Alertă din Costa Rica! Udrea, în pericol? Ce s-a întâmplat în închisoare
evz.ro - Bucureşti
Elena Udrea şi Alina Bica ar fi în pericol în închisoarea din Costa Rica. Se pare că două femei ar fi fost omorâte în închisoarea unde sunt încarcerate Udr...

METEO: O nouă avertizare meteo de vreme deosebit de rece
www.stiri-neamt.ro - Neamţ
Administraţia Naţională de Meteorologie (ANM) a emis astăzi (29 noiembrie), o nouă informare de vreme deosebit de rece, valabilă în toată ţara până

ANM: Informare meteo de ger până duminică!
www.gorjeanul.ro - Gorj
Administraţia Naţională de Meteorologie (ANM) a emis în această după - amiază o nouă informare de vreme deosebit de rece, valabilă în toată ţara până duminică dimineaţă.Potrivit meteorologilor, în intervalul 29 noiembrie, ora 14:00 - 2 decembrie, ora 10:00, vremea se va menţine

Piaţa Unirii, fără schele. A fost finalizată reabilitarea faţadei clădirii de la colţul străzii Alecsandri (FOTO)
www.ebihoreanul.ro - Bihor
În piaţa centrală a Oradiei au început pregătirile pentru Târgul de Crăciun, în cadrul căruia vor fi proiectate imagini de sezon pe clădirile din jur. Anul acesta, proiecţiile nu vor fi obturate căci, de curând, au fost date jos schelele de pe faţada clădirii aflată la intersecţia Pieţei Unirii cu strada Vasile Alecsandri, cu sediul Distrigaz.

Cand va fi redat circulatiei Podul de la butelii
www.ziuaconstanta.ro - Constanţa
Primarul Constantei , Decebal Fagadau a confirmat faptul ca Podul de la butelii va fi redat circulatiei. Acest lucru se va intampla maine dimineata la ora 08.30. ...

Comisarul şef Florin Dogaru şi-a preluat funcţia de comandant al IPJ Alba
ziarulunirea.ro - Alba
Comisarul şef Florin Dogaru şi-a preluat, începând cu data de 29 noiembrie 2018 funcţia de comandant al IPJ Alba, pe care a câştigat-o prin concurs. Deocamdată este vorba despre o împuternicire, până la întocmirea tuturor documentelor necesare pentru a ocupa definitiv postul. Până în prezent, el a ocupat postul de şef al Serviciului de Investigare […]

Istorie şi viitor, la Ziua Bucovinei
www.oltenasul.ro - Dolj
Related Posts via CategoriesAcord pentru dezvoltarea domeniului construcţiilorAcord pentru susţinerea educaţieiGuvernul instituie un mecanism de economisire pentru copii care să le faciliteze accesul la educaţieConcurs de afişe “Reciclăm pentru natură” pentru liceeniProiectele de acte normative care ar putea fi incluse pe agenda şedinţei Guvernului României din 29 noiembrie 2018Senatorul Lavinia Craioveanu participă la “Forumul Global al Femeilor Lider”Alexandra Presură, propunere […]

Tânăr din Cisnădie, prins beat la volan pe Calea Dumbrăvii
revistapresei.oradesibiu.ro - Sibiu
La data de 28 noiembrie a.c., poliţiştii Biroului Rutier Sibiu au reţinut un bărbat, cercetat penal pentru săvârşirea de infracţiuni la regimul rutier. În fapt, la data de 12 noiembrie a.c., în jurul orei 03,30, în municipiul Sibiu, bărbatul în vârstă de 26 de ani, din Cisnădie, a fost depistat…

Urmărit internaţional, reţinut în Vama Oancea
stiridegalati.ro - Galaţi
Marţi dimineaţă, în Punctul de Trecere a Frontierei Oancea, s-a prezentat pentru efectuarea formalităţilor necesare trecerii frontierei de stat, pe sensul de intrare în ţară, un cetăţean basarabean de 25 de ani. La controlul de frontieră, poliţiştii de frontieră au constatat că pe numele bărbatului autorităţile din Austria au emis un mandat de arestare, la …

Programul de 1 Decembrie la Iernut
www.zi-de-zi.ro - Mureş
Primăria şi Consiliul Local Iernut organizează cu ocazia sărbătoririi Centenarului Marii Uniri de la

Ministrul Turismului, Bogdan Trif, la sedinta solemna de guvern, de la Alba Iulia (galerie foto)
www.ziuaconstanta.ro - Constanţa
Ministrul Turismului, Bogdan Trif, a participat la sedinta solemna de Guvern organizata la Alba Iulia, dedicata celebrarii Zilei Nationale a Romaniei in anul Centenarului Marii Uniri. Este o onoare ...

Intervenţie contratimp pentru salvarea unui bărbat prins sub un mal de pământ, la Bistriţa (VIDEO)
www.timponline.ro - Bistriţa-Năsăud
Un bărbat a fost surprins de un mal de pământ în timp ce lucra în propria gospodărie, pe str. Ulmului din Bistriţa, la realizarea unui dren.
https://www.youtube.com/watch?v=L2lnfZQXfy8&feature=youtu.be
Când echipajele de intervenţie au ajuns la locul indicat, bărbatul de 53 de ani era conş

Dorel a asfaltat roţile unei maşini în Floreşti - FOTO
www.stiridecluj.ro - Cluj
Dorel a asfaltat roţile unei maşini în Floreşti - FOTO

"Fă, vă bateţi sau nu? Că eu iau absenţă acum!" Două eleve din Ploieşti s-au bătut cu sălbăticie
ph-online.ro - Prahova
Violenţa în şcolile din România este un fapt incontestabil. Iar scene reprobabile în care elevi sau eleve se iau la bătaie sunt la ordinea zilei. Lice...

Programul de 1 Decembrie al secţiilor Școlii Populare de Artă Târgu-Jiu
www.gorjeanul.ro - Gorj
Programul manifestărilor dedicate Centenarului Marii Uniri şi Zilei Naţionale în ziua de 1 Decembrie: Ora 9:00, în incinta magazinului Carrefour Târgu Jiu, va putea fi vizitată expoziţia meşterilor populari – Ar

Ponta vine mâine la Târgu-Jiu!
www.gorjeanul.ro - Gorj
Deputaţii de Gorj afiliaţi Partidului Pro România, Victor Ponta şi Alin Văcaru, vor susţine mâine dimineaţă, de la ora 10.00, la Târgu-Jiu, la sediul formaţiunii politice, o conferinţă de presă. Momentan nu sunt cunoscute temele ce vor fi abordate mâine de cei doi parlamentari de Gorj

Spectacol dedicat zilei de Mos Nicolae, la sediul Teatrului Calutul de mare din Constanta
www.ziuaconstanta.ro - Constanţa
Joi, 06 decembrie 2018, ORA 10.00, la Teatrul Calutul de mare are loc un spectacol cu ocazia zilei de Mos Nicolae. Actorii nostri vor avea o reprezentatie a spectacolului Spargatorul de nuci regia ...

ISU Neamţ: Avansări în grad şi depunerea jurământului militar cu ocazia Zilei Naţionale a României
www.stiri-neamt.ro - Neamţ
Astăzi, 29.11.2017, începând cu ora 14:00, în cadrul ceremoniei militare organizate de Inspectoratul pentru Situaţii de Urgenţă „Petrodava” al judeţului

Precizări BOMBĂ ale MAE despre Pactul ONU pe migraţie: Documentul nu creează o categorie nouă de drepturi ale migranţilor
evz.ro - Bucureşti
Ministerul Afacerilor Externe face câteva precizări de presă referitoare la Compactul Global pentru Migraţie, pe site-ul oficial. În mesajul făcut public M...

MESAJE HAIOASE de SFANTUL ANDREI: SMS-uri, felicitari şi urări amuzante de Sfantul Andrei
ziarulunirea.ro - Alba
Mesaje haioase de Sfantul Andrei 2018 • Urări de „La multi ani„ hazlii şi amuzante pentru toţi cei care îşi serbează onomastica. Sarbatoarea Sfantului Andrei, ocrotitorul romanilor, celebrata pe 30 noiembrie este o buna ocazie pentru a trimite mesaje haioase, de felicitare, sms-uri si urari celor care poarta numele de Andrei sau derivate ale acestuia. […]

Atenţie mureşeni! Înşelăciuni cu maşini de cusut Singer!
www.zi-de-zi.ro - Mureş
Escrocheriile cu maşini vechi de cusut sunt din nou ”la modă” ! Atenţie la cazurile de escrocherie p

Guvernul a adoptat OUG prin care vor fi deschise automat conturi de economii la Trezorerie pentru copiii cu vârsta sub 18 ani
ph-online.ro - Prahova
Guvernul a adoptat joi o ordonanţă de urgenţă privind implementarea programului guvernamental ''gROwth-Contul individual de economii Junior Centenar''...

Programul de 1 Decembrie ale secţiilor Școlii Populare de Artă Târgu-Jiu
www.gorjeanul.ro - Gorj
Programul manifestărilor dedicate Centenarului Marii Uniri şi Zilei Naţionale în ziua de 1 Decembrie: Ora 9:00, în incinta magazinului Carrefour Târgu Jiu, va putea fi vizitată expoziţia meşterilor populari – Ar

E-Distributie Dobrogea intrerupe furnizarea energiei electrice pentru efectuarea unor lucrari in judetul Constanta!
www.ziuaconstanta.ro - Constanţa
Pentru lucrarile anuale de reparatii si intretinere instalatii si retele electrice, precum si posturi de transformare, SC E- Distributie Dobrogea SA - Zona MT-JT Constanta, anunta intreruperea ...

Tânăr din Avrig închis la Sibiu pentru ultraj
revistapresei.oradesibiu.ro - Sibiu
Poliţiştii din cadrul Poliţiei Oraşului Avrig au identificat şi prins un bărbat în vârstă de 34 de ani, din Avrig, pe numele căruia Judecătoria Turda a emis mandat de executare a pedepsei închisorii. Bărbatul a fost condamnat la o pedeapsă de un an închisoare pentru săvârşirea infracţiunii de ultraj. Persoana…

Deţinuţii Penitenciarului Târgu-Jiu, la Muzeul Iluziilor
www.gorjeanul.ro - Gorj
Astăzi, 29.11.2018, un grup de 14 deţinuţi aflaţi în custodia Penitenciarului Tg Jiu , au avut ocazia să viziteze ,,Muzeul Iluziilor”, găzduit de Muzeul Judeţean ”Alexandru Ștefulescu”. În cadrul vizitei, participanţii au avut ocazia să intre

Apare o MINĂ DE AUR. Oricine se poate ÎMBOGĂŢI!
evz.ro - Bucureşti
O cantitate uriaşă de date s-a acumulat la nivel global, iar, pe măsură ce transformarea digitală prinde contur, acestea vor începe să fie exploatate cu câş...

Piatra-Neamţ: Dorina Drexler, diplomă de apreciere pentru implicarea în proiectele dedicate Centenarului
www.stiri-neamt.ro - Neamţ
Luminiţa Dorina Drexler, profesor de istorie al Colegiului Naţional Petru Rareş din Piatra-Neamţ a primit în cadrul şedinţei Consiliului Local de

Acord pentru dezvoltarea domeniului construcţiilor
www.oltenasul.ro - Dolj
Related Posts via CategoriesAcord pentru susţinerea educaţieiGuvernul instituie un mecanism de economisire pentru copii care să le faciliteze accesul la educaţieConcurs de afişe “Reciclăm pentru natură” pentru liceeniProiectele de acte normative care ar putea fi incluse pe agenda şedinţei Guvernului României din 29 noiembrie 2018Senatorul Lavinia Craioveanu participă la “Forumul Global al Femeilor Lider”Alexandra Presură, propunere legislativă pentru copiii ce […]

Google lanseaza noi colectii Street View cu ocazia Centenarului
ziarmm.ro - Maramureş
Google a lansat noi imagini Street View si galerii Google Earth pentru a marca aniversarea a 100 de ani de la Unirea Romaniei, se arata intr-un comunicat al companiei, informeaza AGERPRES. Astfel, Muz

Cum arată bradul ”made in Italy” adus să împodobească centrul Timişoarei. FOTO în text
evz.ro - Bucureşti
Primăria Timişoara a plătit peste 7.000 de euro pe un brad de Crăciun care a fost adus tocmai din Italia. Pomul a ajuns joi în capitala Banatului şi a fost ...

Acord pentru susţinerea educaţiei
www.oltenasul.ro - Dolj
Related Posts via CategoriesGuvernul instituie un mecanism de economisire pentru copii care să le faciliteze accesul la educaţieConcurs de afişe “Reciclăm pentru natură” pentru liceeniProiectele de acte normative care ar putea fi incluse pe agenda şedinţei Guvernului României din 29 noiembrie 2018Senatorul Lavinia Craioveanu participă la “Forumul Global al Femeilor Lider”Alexandra Presură, propunere legislativă pentru copiii ce nu deţin cod […]

ANM: Informare meteo de ger la nivelul intregii tari, pana duminica dimineata
ziarmm.ro - Maramureş
Administratia Nationala de Meteorologie (ANM) a emis, joi, o noua informare de vreme deosebit de rece, valabila in toata tara pana duminica dimineata, informeaza AGERPRES. Potrivit meteorologilor, in

Cetatea uitată: Ce a ajuns astăzi Cetatea Bihariei, cândva o fortăreaţă strategică importantă pentru Bihor (FOTO)
www.ebihoreanul.ro - Bihor
Având o poziţie strategică importantă la începutul Evului Mediu, Cetatea Bihariei a fost centrul de greutate al zonei actuale a Bihorului. Uitată de autorităţi şi aproape complet necunoscută publicului, fortăreaţa aflată la marginea comunei Biharia a trecut într-un timp relativ scurt de la glorie la un rol neînsemnat din punct de vedere religios şi militar.

Constantenii doneaza haine pentru semenii lor nevoiasi
www.ziuaconstanta.ro - Constanţa
Primarul Decebal Fagadau vorbeste despre proiectul de colectare de haine pentru persoanele nevoiase. Containerele au fost astazi golite pentru a treia oara. Este vorba despre containerele ...

Piastrelle a aniversat 20 de ani în România
www.tion.ro - Timiş
ADVERTORIAL. După 20 de ani de prezenţă pe piaţa din România, Piastrelle continuă seria evenimentelor cu iz mediteranean şi propune partenerilor şi furnizorilor săi o scurtă incursiune în cel mai pur Stile di Vita Italiano.

Noi promisiuni de la Transporturi: Licitaţia pentru tronsonul cu tuneluri de pe A1 are loc în decembrie
www.tion.ro - Timiş
Probabil dezamăgit că nu va putea tăia panglici la loturile 3 şi 4 din Lugoj – Deva în acest an, ministrul demisionar al Transporturilor, Lucian Şova, a venit în vizită de lucru în zona de vest a ţării cu noi promisiuni. De această dată acestea sunt legate de porţiunea cu tuneluri, de pe lotul 2.

Lizuca, Patrocle, Scufiţa Roşie şi Gulliver la final de an pe scena de la Gong
revistapresei.oradesibiu.ro - Sibiu
Teatrul pentru Copii şi Tineret „Gong” Sibiu încheie programul din acest an cu spectacolele „Dumbrava minunată” în regia lui Gabriel Apostol, „Scufiţa Roşie” în regia lui Diego Aramburo şi „Cel mai mare Gulliver” în regia lui Alexandru Dabija. Una dintre cele mai emoţionante poveşti din literatura românească prinde viaţă într-o…

UVT Agroland Timişoara a păşit cu stângul în Europa: înfrângere cu Vasas Budapesta
expressdebanat.ro - Caraş-Severin
UVT Agroland Timişoara a pierdut primul meci de cupe europene din istoria clubului. Timişorencele au cedat cu 3-1 în deplasare la Vasas Budapesta, joc care a contat pentru Cupa Challenge.

Aplicaţie mobilă pentru starea drumurilor din judeţul Cluj
feedproxy.google.com - Cluj
Consiliul judeţean lucrează în acest moment la o aplicaţie mobilă ce va cuprinde informaţii despre starea drumurilor din judeţul Cluj.

Anunţ pentru mii de bugetari! Ce le pregăteşte Guvernul
evz.ro - Bucureşti
Guvernul s-a reunit, joi, în şedinţă solemnă la Alba Iulia, cu prilejul celebrării Centenarului. Șefa Guvernului, premierul Viorica Dăncilă, a rostit un ...

PSD, pregătit să dea amnistia şi graţierea? „Ne vom asuma”
evz.ro - Bucureşti
Social-democraţii vor să dea Ordonanţa de Urgenţă pe amnistie şi graţiere, intenţionează să-şi asume textul de lege, însă nu au stabilit momentul oportun. ...

AVIONUL LUI TRUMP a fost LOVIT de un BOMBARDIER. Stare de alertă la Casa Albă! Breaking news internaţional
evz.ro - Bucureşti
Avionul privat al preşedintelui Statelor Unite ale Americii, Donald Trump, a fost implicat recent într-un incident pe aeroportul LaGuardia din New York....

Închis la Centrul Regional de Transfuzie Sanguină Timişoara de Sfântul Andrei
www.tion.ro - Timiş
Cei de la Centrul de Transfuzie Sanguină din Timişoara au liber vineri, în 30 noiembrie, de Sfântul Andrei. Prin urmare, dacă vineri aveţi liber de la „lucru” şi doreaţi să mergeţi să donaţi sânge, atunci puteţi lăsa această activitate pe luni. Oricum primiţi o zi liberă de la serviciu în urma donării de sânge.

Guvernul instituie un mecanism de economisire pentru copii care să le faciliteze accesul la educaţie
www.oltenasul.ro - Dolj
Related Posts via CategoriesConcurs de afişe “Reciclăm pentru natură” pentru liceeniProiectele de acte normative care ar putea fi incluse pe agenda şedinţei Guvernului României din 29 noiembrie 2018Senatorul Lavinia Craioveanu participă la “Forumul Global al Femeilor Lider”Alexandra Presură, propunere legislativă pentru copiii ce nu deţin cod numeric personalASOCIATIA TINERILOR CU INITIATIVA DIN ZONA OLTENIEI – Stop excluziunii sociale a tinerilor […]

FOTO/VIDEO. Satu Mare în 1918! Aşa s-a hotărât unirea cu ţara!
portalsm.ro - Satu Mare
VIDEO. Satu Mare în 1918! Aşa s-a hotărât unirea cu ţara!

VIDEO. Satu Mare în 1918! Aşa s-a hotărât unirea cu ţara!
portalsm.ro - Satu Mare
VIDEO. Satu Mare în 1918! Aşa s-a hotărât unirea cu ţara!

Deputat PNL Sorin Bumb: ”La Centenarul Unirii trebuie să fim uniţi în jurul valorilor de libertate, dreptate şi justiţie”
ziarulunirea.ro - Alba
România se află acum la un moment deosebit de important pentru românii de pretutindeni: ţara noastră îşi sărbătoreşte primii 100 de ani ca stat naţional, unitar, modern, primii 100 de ani de recunoaştere a locului şi rolului său în marea familie europeană şi pe scena internaţională. Alba Iulia este, privită din această perspectivă, capitala unirii […]

FOTO Accident pe Strada Avrig. Șoferului i s-a făcut rău
www.oradesibiu.ro - Sibiu
Joi, în jurul amiezii, două autoturisme au fost implicate într-un eveniment de circulaţie din cauza nepăstrării distanţei regulamentare. În urma impactului nimeni nu a fost rănit, dar după 10 minute şoferului vinovat i s-a făcut rău. La faţa locului a venit un echipaj SMURD care i-a acordat primele îngrijiri medicale.…

Huliţi la Sibiu, vâlcenii sunt primiţi cu braţele deschise la Șelimbăr
www.oradesibiu.ro - Sibiu
Prin Sibiu circulă mitul cum că vâlcenii nu sunt prea bine primiţi. Se spune că sunt discriminaţi şi că se fac tot felul de glume pe seama lor şi a celor veniţi din sudul ţării, în general. Administraţia locală le este recunoscătoare. Mare parte dintre cei care au cumpărat locuinţe…

FOTO Centenarul Marii Uniri, sărbătorit la Biblioteca ASTRA din Sibiu
revistapresei.oradesibiu.ro - Sibiu
Biblioteca Judeţeană ASTRA Sibiu organizează un vernisaj al expoziţiei tematice şi la prezentarea albumelor documentare dedicate Marii Uniri, sâmbătă, 1 decembrie, începând cu ora 12.30. Acest eveniment va avea loc la Biblioteca Judeţeană ASTRA Sibiu, în Muzeul Asociaţiunii din str. George Bariţiu, nr. 5, et. 1, începând cu ora 12:30…

Anunţ: S.C. GREENGOLD VALUE FOREST S.R.L., titularul: ”Planului de Amenajament silvic U.P. XIV Secu”
ziarharghita.ro - Harghita
S.C. GREENGOLD VALUE FOREST S.R.L., titularul: ”Planului de Amenajament silvic U.P. XIV Secu”, pe teritoriul administrativ al mun. Topliţa şi oraşului

IORDACHE: SPITALUL JUDETEAN, PENTRU CA ARE UN MANAGEMENT DE DOI LEI, PIERDE 11 MILIARDE LEI VECHI SI CJ ACOPERA GAURA PENTRU CA MANAGERUL RASNOVEANU ESTE RUDA CU TUDOSE
www.infobraila.ro - Brăila
Comentarii comentariu

Expoziţie de fotografii: Arhitectura Centenarului
www.desteptarea.ro - Bacău
Astăzi,de la ora 12.00, la parterul Palatului Administrativ din Bacău, a avut loc vernisajul unei interesante şi instructive expoziţii de fotografii, intitulată „Arhitectura Centenarului”, organizată de Filiala Regională Bacău – Neamţ a Uniunii Arhitecţilor din România şi Filiala Teritorială Bacău-Neamţ a Ordinului Arhitecţilor din România, în parteneriat cu CREART – Centrul de Creaţie, Artă şi …

Jucarii in valoare de aproximativ 21600 lei, confiscate de inspectorii vamali constanteni
www.ziuaconstanta.ro - Constanţa
In data de 28 noiembrie 2018, inspectorii vamali din cadrul Biroului vamal de frontiera Constanta Sud, actionand in baza atributiilor de serviciu, au descoperit, la efectuarea controlului fizic, 1080 ...

Naţional Sebiş – CS Ocna Mureş, vineri, ora 14.00 | “Lanterna roşie”, criză majoră de efectiv!
ziarulunirea.ro - Alba
CS Ocna Mureş pare victimă sigură în ultima etapă a turului eşalonului terţ, vineri, 30 noiembrie, în deplasarea de la Sebiş, de la ora 14.00. Asta pentru că “lanterna roşie” a Seriei a 4-a, dincolo de rezultatele dezamăgitoare (un singur punct, 7 eşecuri la rând, trei jocuri în care a primit de fiecare data 5 […]

Concurs de afişe “Reciclăm pentru natură” pentru liceeni
www.oltenasul.ro - Dolj
Related Posts via CategoriesProiectele de acte normative care ar putea fi incluse pe agenda şedinţei Guvernului României din 29 noiembrie 2018Senatorul Lavinia Craioveanu participă la “Forumul Global al Femeilor Lider”Alexandra Presură, propunere legislativă pentru copiii ce nu deţin cod numeric personalASOCIATIA TINERILOR CU INITIATIVA DIN ZONA OLTENIEI – Stop excluziunii sociale a tinerilor defavorizaţi! – Proiect finanţat din fondurile bugetului […]

IORDACHE, SPRE CHIRIAC: ATI SPUS CA AU FURAT DOCTORII SI ASISTENTELE?! SUNTETI IN DEPLINATATEA FACULTATILOR MINTALE? CEEA CE FACETI LA SPITAL ESTE O MAGARIE FARA DE MARGINI!
www.infobraila.ro - Brăila
Comentarii comentariu

Programul Cimitirului Minicipal în minivacanţă – Acces gratuit pentru maşini
www.oradesibiu.ro - Sibiu
Serviciul Public Administrarea Cimitirului Municipal Sibiu informează cetăţenii municipiului faptul că zilele de 30 noiembrie şi 1 decembrie au fost declarate zile de sărbătoare legală în care nu se lucrează. În consecinţă, personalul Serviciului Public Administrarea Cimitirului Municipal Sibiu îşi va desfăşura activitatea după următorul program: VINERI 30 noiembrie 2018…

Program modificat la Evidenţa Persoanelor din Sibiu în minivacanţă – Când se pot declara decesele
www.oradesibiu.ro - Sibiu
Serviciul Public Comunitar de Evidenţă a Persoanelor Sibiu - Serviciul Stare Civilă informează cetăţenii municipiului că zilele de 30 noiembrie şi 1 decembrie au fost declarate zile de sărbătoare legală în care nu se lucrează. În consecinţă, personalul Serviciului Stare Civilă - decese din cadrul Serviciului Public Comunitar de Evidenţă…

Sezonul gripelor – Câţi sibieni au ajuns până acum la spital
www.oradesibiu.ro - Sibiu
În cadrul Sistemului de supraveghere de rutină a infecţiilor respiratorii şi a gripei, la nivelul judeţului Sibiu, în săptămâna precedentă (19.11.2018 – 25.11.2018) a crescut uşor numărul Infecţiilor Respiratorii Acute (2275), cu circa 5.42% faţă de cazurile din săptămâna anterioară de raportare (2158), fiind cu 16.97% mai mare faţă de…

S-a lansat a treia ediţie a cărţii Femei puternice, femei de succes la Sibiu
revistapresei.oradesibiu.ro - Sibiu
Cea de a treia ediţia a volumului Femei puternice, femei de succes!, care este o culegere de intreviuri cu cele mai importante doamne ale Sibiului, a fost lansastă în 27 noiemnrie, la Teatrul ”Gong”. Sibiencele care prin munca şi pasiunea pentru domeniul în care activează - şi în care excelează…

Încă o facilitate pentru bugetari – Din decembrie, primesc 300 de lei lunar
revistapresei.oradesibiu.ro - Sibiu
Începând cu luna decembrie, bugetarii vor primi o indemnizaie de hrană de 300 de lei lunar, prevăzută în legea salarizării unitare. Până acum numai angajaţii din Ministerul de Interne, Ministerul Apărării, Ministerul Justiţiei, SRI, SIE şi SPP, alături de poliţia locală beneficiau de drepturi de hrană, începând cu decembrie 2018…

29-30 noiembrie: Noaptea Sfântului Andrei. Tradiţii şi superstiţii
www.stiri-neamt.ro - Neamţ
Sfântul Andrei, ocrotitorul românilor, este prăznuit pe 30 noiembrie. Potrivit tradiţiei populare româneşti, noaptea de 29 spre 30 noiembrie este plină de

MApN: Activitati dedicate Zilei Nationale a Romaniei
www.ziuaconstanta.ro - Constanţa
Joi, 29 noiembrie, in contextul activitatilor dedicate Zilei Nationale a Romaniei, din ordinul sefului Statului Major al Apararii, generalul Nicolae Ciuca, la nivelul tuturor structurilor din compunerea ...

MApN: Activitati dedicate Zilei Nationale a Romaniei
www.ziuaconstanta.ro - Constanţa
Joi, 29 noiembrie, in contextul activitatilor dedicate Zilei Nationale a Romaniei, din ordinul sefului Statului Major al Apararii, generalul Nicolae Ciuca, la nivelul tuturor structurilor din compunerea ...

Un tanar din Ramnicelu a fost prins de catre politie in timp ce fura lemne
www.infobraila.ro - Brăila
Comentarii comentariu

Nouă avertizare meteo de vreme foarte rece
www.timponline.ro - Bistriţa-Năsăud
Administraţia Naţională de Meteorologie (ANM) a emis o nouă avertizare devreme deosebit de rece, valabilă de joi 29 noiembrie, ora 14.00, până duminică 2 decembrie, ora 10.00.
În intervalul menţionat, vremea se va menţine deosebit de rece în toată ţara.
Temperaturile vor continua să fie perman

Nouă avertizare meteo de vreme foarte rece
www.timponline.ro - Bistriţa-Năsăud
Administraţia Naţională de Meteorologie (ANM) a emis o nouă avertizare devreme deosebit de rece, valabilă de joi 29 noiembrie, ora 14.00, până duminică 2 decembrie, ora 10.00.
În intervalul menţionat, vremea se va menţine deosebit de rece în toată ţara.
Temperaturile vor continua să fie perman

Nouă avertizare meteo de vreme foarte rece
www.timponline.ro - Bistriţa-Năsăud
Administraţia Naţională de Meteorologie (ANM) a emis o nouă avertizare devreme deosebit de rece, valabilă de joi 29 noiembrie, ora 14.00, până duminică 2 decembrie, ora 10.00.
În intervalul menţionat, vremea se va menţine deosebit de rece în toată ţara.
Temperaturile vor continua să fie perman

Educaţie Culturală Comprehensivă, ediţia I: 100 de Ani Înapoi în Viitor, la Teatrul Ariel
www.zi-de-zi.ro - Mureş
Asociaţia ANIMACT are plăcerea de a vă invita să vedeţi rezultatele programului cultural 100 de Ani

Premieră la paradă. Jandarmii defilează în uniforme de epocă
evz.ro - Bucureşti
În anul Centenarului Marii Uniri s-au împlinit 168 de ani de la înfiinţarea Jandarmeriei Române. Un eveniment deosebit pentru jandarmi care vor defila ...

Care va fi programul Spitalului Judetean Constanta in minivacanta de 1 Decembrie
www.ziuaconstanta.ro - Constanţa
Conducerea Spitalului Clinic Judetean de Urgenta Sf. Apostol Andrei Constanta aduce la cunostinta publicului ca activitatea medicala din cadrul Spitalului Judetean Constanta va decurge normal in ...

Cum a fost sărbătorit Centenarul la Spermezeu
www.timponline.ro - Bistriţa-Năsăud
În comuna Spermezeu a fost sărbătorit în avans Centenarul Marii Uniri. Cu mic cu mare, în frunte cu primarul Sorin Hognogi, oamenii s-au îmbrăcat în costume populare şi au urmărit un spectacol susţinut de elevi.
Apoi, toată lumea s-a prins în Hora Unirii, în timp ce mai mulţi tineri au fluturat s

Lecţiile lui UMBERTO ECO - falsificarea istoriei şi OBSESIA COMPLOTULUI
evz.ro - Bucureşti
Cele 12 texte publicate în acest volum reprezintă prelegeri susţinute de Umberto Eco în cadrul festivalului La Milanesiana, între 2001 şi 20015. Acestea au ...

Rusia MUTĂ AGRESIV la Marea Neagră. Pregătiri de război la Kremlin? Breaking news
evz.ro - Bucureşti
Rusia intenţionează să construiască o nouă staţie radar de avertizare în cazul unui atac cu rachete în Crimeea anul viitor, a informat astăzi Agenţia de pre...

FOTO/VIDEO. Drapelul României, arborat pe Palatul Administrativ
portalsm.ro - Satu Mare
Drapelul României, arborat pe Palatul Administrativ

Procedurile de ADOPŢIE au fost SIMPLIFICATE. Ce stimulent FINANCIAR vor primi părinţii adoptivi
ph-online.ro - Prahova
Senatul a adoptat, în plenul de miercuri, un proiect de lege privind adopţia, care prevede debirocratizarea şi simplificarea procedurilor. Deputatul i...

VIDEO: MARȘUL UNIRII dă startul zilei de 1 DECEMBRIE la Alba Iulia. Participă mii se basarabeni, nord-bucovineni şi români din ţară veniţi pe jos sau cu căruţele, ca acum 100 de ani
ziarulunirea.ro - Alba
Ziua de 1 Decembrie la Alba Iulia va debuta cu Marşul Unirii, organizat de Platforma Unionistă Acţiunea 2012, de la ora 8.00, cu pornire de la gara feroviară. La eveniment vor participa mii de basarabeni şi nord-bucovineni, membri ai Asociaţiei Diaspora Europeană, reuniţi din statele europene la vama Borş, dar şi români din ţară veniţi […]

Program cultural bogat de Centenar la Târnăveni
www.zi-de-zi.ro - Mureş
Cu ocazia Centenarului Marii Uniri, Primăria municipiului Târnăveni organizează un foarte bogat prog

România, PE ULTIMUL LOC loc în UE la cheltuielile pentru sănătate
evz.ro - Bucureşti
Romania este statul din Uniunea Europeana care în 2016 a alocat cel mai mic procent din PIB (5%) pentru sănătate, la polul opus fiind Franţa (11,5%), German...

Bogdan Toader taie in carne vie! Doua posturi de la Directia Tehnica, desfiintate. Vezi aici motivul
ph-online.ro - Prahova
Doua posturi de conducere din cadrul Consiliului Judetean Prahova vor fi desfiintate ca urmare a neindeplinirii sarcinilor de serviciu, a anuntat prez...

Spitalul de Copii de pe Moţilor va fi modernizat şi extins
feedproxy.google.com - Cluj
Alin Tişe, preşedintele CJ Cluj a declarat că Spitalul de Copii de pe Moţilor va intra într-un proces de modernizare şi extindere.

Pompierii actioneaza in Mutfatlar. Un autoturism cu patru persoane in flacari
www.ziuaconstanta.ro - Constanţa
Potrivit ISU Constanta, un incendiu a avut loc in localitatea Murfatlar din judetul Constanta. Din primele informatii, este vorba despre un autoturism. Potrivit IPJ Constanta, in jurul orei 14.30, pe ...

Comunicat de presă lansare proiect „Creşterea eficienţei energetice a clădirii contagioase din cadrul spitalului municipal Sebeş”, cod MySMIS 118577
ziarulunirea.ro - Alba
COMUNICAT DE PRESĂ 29.11.2018 ANUNȚ LANSARE PROIECT Proiectul “Creşterea eficienţei energetice a clădirii contagioase din cadrul spitalului municipal Sebeş”, cod MySMIS 118577, finanţat prin Programul Operaţional Regional 2014-2020 este implementat de către Municipiul Sebeş şi are o valoare totală de 1.512.217,22 lei, din care 1.389.536,36 lei reprezintă finanţare nerambursabilă. Programul Operaţional Regional 2014-2020 […]

FOTO / VIDEO: MARȘUL UNIRII dă startul zilei de 1 DECEMBRIE la Alba Iulia. Participă mii se basarabeni, nord-bucovineni şi români din ţară veniţi pe jos sau cu căruţele, ca acum 100 de ani
ziarulunirea.ro - Alba
Ziua de 1 Decembrie la Alba Iulia va debuta cu Marşul Unirii, organizat de Platforma Unionistă Acţiunea 2012, de la ora 8.00, cu pornire de la gara feroviară. La eveniment vor participa mii de basarabeni şi nord-bucovineni, membri ai Asociaţiei Diaspora Europeană, reuniţi din statele europene la vama Borş, dar şi români din ţară veniţi […]

Romanii au cautat joburi in vanzari, contabilitate si resurse umane in 2018
ziarmm.ro - Maramureş
Aproape 3,5 milioane de CV-uri au fost depuse in 2018 de catre candidatii activi pe platforma de recrutare online eJobs.ro, cei mai multi dintre ei cautand un job in vanzari, contabilitate si resurse

Serviciul de Ambulanta Judetean Constanta angajeaza. Ce post este vacant
www.ziuaconstanta.ro - Constanţa
Serviciul de Ambulanta Judetean Constanta organizeaza concurs de recrutare pentru ocuparea, pe perioada nedeterminata, a functiilor contractuale de executie, vacante, de operator registrator de ...

Percheziţii în Bistriţa. 4 bărbaţi, în arest după ce au furat bani dintr-o locuinţă. Ce au confiscat poliţiştii
www.timponline.ro - Bistriţa-Năsăud
Poliţiştii specializaţi în investigaţii criminale din Bistriţa-Năsăud, sub coordonarea Parchetului de pe lângă Judecătoria Beclean, au reuşit identificarea a patru bărbaţi bănuiţi de comiterea unui furt din locuinţă al cărui prejudiciu total este de peste 140.000 de lei.
La data de 28 noiembrie,

Angela Merkel respinge cererea lui Poroşenko de nave NATO, îndemând Kievul la calm
evz.ro - Bucureşti
Angela Merkel a îndemnat astăzi Kievul la reţinere, după ce preşedintele ucrainean Petro Poroşenko a cerut ca Kievul să fie susţinut cu nave NATO la Marea A...

Directia Silvica Prahova vinde pomi de Craciun. Cat costa
ph-online.ro - Prahova
Directia Silvica Prahova vinde pomi de Craciun. Mai mult, silvicultorii nu vand doar brazi si molizi taiati ci si in ghivece sau in balot de pamant. P...

Eugen Teodorovici, despre scandările împotriva Guvernului de la Alba Iulia: Nu am auzit nimic
ziarulunirea.ro - Alba
Eugen Teodorovici a spus, joi, după ce a ieşit din Sala Unirii unde a participat la şedinţa solemnă a Guvernului, că nu a auzit scandările împotriva Guvernului, în contextul în care chiar în acel moment un grup restrâns de oameni strigau demisia. Un jurnalist a adus în discuţie faptul că grupuri mici de oameni au […]

Schimbare
www.ziuaconstanta.ro - Constanţa
-Aurul expus in aer liber sufera vreo schimbare? -Da,domnule profesor. -Intr-adevar! Si anume? -O schimbare de proprietar. ...

Festivalul Folcloric Concurs „În paşi de dans şi voie bună”
www.desteptarea.ro - Bacău
O SCENĂ DE MICI ARTIȘTI – frumuseţe, dansuri, muzică populară, tradiţii şi obiceiuri populare româneşti Festivalul Folcloric Concurs „În paşi de dans şi voie bună”, este un eveniment ce s-a desfăşurat, sâmbătă 24 noiembrie 2018, la Filarmonica „Mihail Jora” Bacău, realizat cu sprijinul PRIMARULUI MUNICIPIULUI BACĂU ŞI AL CONSILIULUI LOCAL AL MUNICIPIULUI BACĂU, fără de …

Vreme deosebit de rece până duminică
ziarulteleormanul.ro - Teleorman
Potrivit meteorologilor, în intervalul 29 noiembrie, ora 14:00 – 2 decembrie, ora 10:00, vremea se va menţine deosebit de rece în toată ţara. Temperaturile vor continua să fie permanent negative în majoritatea regiunilor, iar în cursul nopţilor şi al dimineţilor va fi ger (temperaturi sub -10 grade) în nordul, nord-estul şi centrul ţării, local în sud şi est şi izolat în rest. Administraţia Naţională de Meteorologie (ANM) a emis, joi, o nouă informare de vreme deosebit de rece, valabilă în toată ţara până duminică dimineaţă. Astfel, joi (29 noiembrie) şi vineri (30 noiembrie), vântul va

Ultima oră! Apare o nouă BANCNOTĂ în România
evz.ro - Bucureşti
BNR emite o Bancnotă aniversară pentru colecţionare dedicată împlinirii a 100 de ani de la Marea Unire de la 1 Decembrie 1918....

Ministrul ZERO euro din fondurile europene, locul întâi pe lista pentru europarlamentare. Un traseist politic este recompensat şi el cu o poziţie bună
evz.ro - Bucureşti
După o procedură internă de campanie şi vot, după câteva scandaluri de răsunet, USR a stabilit lista pentru alegerile europarlamentare....

Eurostat confirmă că România este PE ULTIMUL LOC loc în UE la cheltuielile pentru sănătate
evz.ro - Bucureşti
Romania este statul din Uniunea Europeana care în 2016 a alocat cel mai mic procent din PIB (5%) pentru sănătate, la polul opus fiind Franţa (11,5%), German...

Tractorist fără permis, implicat într-un accident. A lovit o maşină condusă de o tânără de 19 ani
portalsm.ro - Satu Mare
Tractorist fără permis, implicat într-un accident. A lovit o maşină condusă de o tânără de 19 ani

Phillip Morris a lansat la Cluj cea mai recentă generaţie de produse IQOS, liderul produselor de tutun încălzit (P)
www.stiridecluj.ro - Cluj
După lansarea globală din Tokyo, cele mai noi dispozitive IQOS 3 şi IQOS 3 MULTI ajung ...

Eugen Teodorovici, despre de scandările împotriva Guvernului de la Alba Iulia: Nu am auzit nimic
ziarulunirea.ro - Alba
Eugen Teodorovici a spus, joi, după ce a ieşit din Sala Unirii unde a participat la şedinţa solemnă a Guvernului, că nu a auzit scandările împotriva Guvernului, în contextul în care chiar în acel moment un grup restrâns de oameni strigau demisia. Un jurnalist a adus în discuţie faptul că grupuri mici de oameni au […]

Phillip Morris a lansat la Cluj cea mai recentă generaţie de produse IQOS, liderul produselor de tutun încălzit
www.stiridecluj.ro - Cluj
După lansarea globală din Tokyo, cele mai noi dispozitive IQOS 3 şi IQOS 3 MULTI ajung ...

Tineri reţinuti după ce au tâlhărit un alt tânăr pe stradă, la Timişoara
www.tion.ro - Timiş
Acuzaţii de tâlhărie calificată pe numele a trei tineri cu vârste cuprinse între 16 şi 20 de ani, la Timişoara. Ei au fost reţinuţi pentru 24 de ore după ce au tâlhărit un tânăr de 30 de ani pe stradă.

Handbal: CSM Oradea dispută vineri ultimul joc oficial din acest an
www.ebihoreanul.ro - Bihor
Handbaliştii de la CSM Oradea vor disputa în acest sfârşit de săptămână ultimul joc din acest an calendaristic. Astfel, bihorenii vor primi, vineri, de la ora 17, replica echipei HC Sibiu. Meciul este programat la Arena Antonio Alexe, iar intrarea spectatorilor este liberă.

UPDATE/ Accident rutier MORTAL, la Ighiu: Un bărbat şi-a pierdut viaţa după ce fost lovit de o maşină, în timp ce mergea pe marginea drumului
ziarulunirea.ro - Alba
Un accident rutier soldat cu rănirea gravă şi ulterior decesul unui bărbat s-a produs, miercuri seara, pe raza localităţii Ighiu. Potrivit IPJ Alba, un pieton în vârstă de circa 60 de ani a fost acroşat de un autovehicul, în timp ce se deplasa pe marginea carosabilului. Victima a fost supusă manevrelor de resuscitare şi apoi […]

Teodorovici, OMUL RUŞILOR? Acuzaţii grele la nivel înalt. Ce reacţie va avea Dragnea? News alert
evz.ro - Bucureşti
Propunerea ministrului de Finanţe, Eugen Teodorovici, privind limitarea dreptului de muncă al românilor din străinătate, a stârnit numeroase controverse....

Weekend-ul începe de joi la Cotton Pub – Trei seri fulminante cu trei DJ de top
www.oradesibiu.ro - Sibiu
Minivacanţa de 1 decembrie aduce şi la Cotton Pub mega surprize. Și dacă e vacanţă, să fie distracţie! Aşa că sărbătoarea începe încă de joi seara, când toţi cei cu numele de Andrei şi Andreea primesc din partea casei o sticlă de vin spumant. Toţi cei care vor veni în…

Grigore, interimat terminat!
ph-online.ro - Prahova
Interimatul lui Octavian Grigore în funcţia de antrenor principal al FC Petrolul Ploieşti s-a încheiat după eşecul de la Academica Clinceni, meci din...

FOTO. Documentele şi obiectele sătmărenilor care au făcut Unirea. Expoziţie unică la Muzeul Judeţean
portalsm.ro - Satu Mare
Documentele şi obiectele sătmărenilor care au făcut Unirea. Expoziţie unică la Muzeul Judeţean

Timişorenii, chemaţi să cunoască istoria oraşului la o expoziţie cu cele mai importante premiere
www.tion.ro - Timiş
Timişoara şi Banatul au fost primele în România, chiar şi în Europa, la numeroase capitole. Din păcate, puţini dintre concetăţenii noştri le cunosc, iar Societatea Inventatorilor din Banat ne vine în ajutor, oferindu-ne expoziţia „Premierele Timişorene, Bănăţene, Naţionale, Europene şi Mondiale”.

Ce facem în weekend, la Timişoara?
www.tion.ro - Timiş
În acest sfârşit de săptămână timişorenii vor sărbători Centenarul Unirii cu concerte explozive şi petreceri pe toate gusturile! Oraşul de pe Bega a îmbrăcat haine de sărbătoare şi îşi aşteaptă locuitorii la un weekend lung, nemaipomenit.

AVERTISMENT dur: NU MAI VIN companii noi în România!
evz.ro - Bucureşti
Omul de afaceri Liviu Tudor, care administrează două parcuri de afaceri în Bucureşti, previzionează că proprietarii de clădiri de birouri vor fi nevoiţi să ...

ARŞINEL A CEDAT! Teribila veste care a zguduit TEATRUL ROMÂNESC a picat ca un trăsnet. Breaking news
evz.ro - Bucureşti
Alexrandru Arşinel, celebrul actor român, a luat o decizie finală. Acesta a decis să se retragă din activitatea sa, întrucât anii şi-au pus amprenta asupra ...

Trafic restricţionat pe PODUL Râul Doamnei
ziarulargesul.ro - Argeş
Primăria Municipiului Piteşti anunţă că în ziua de vineri, 30.11.2018, în intervalul orar 08:30-16:00, circulaţia pe podul peste râul Doamnei va fi restricţionată (fără întreruperea circulaţiei) ca urmare a lucrărilor de reparaţii la suprafaţa căilor de rulare, lucrări ce se impun în vederea...
 ziarulargesul.ro - Argeş
ziarulargesul.ro - Argeş
Primăria Municipiului Piteşti anunţă că în ziua de vineri, 30.11.2018, în intervalul orar 08:30-16:00, circulaţia pe podul peste râul Doamnei va fi restricţionată (fără întreruperea circulaţiei) ca urmare a lucrărilor de reparaţii la suprafaţa căilor de rulare, lucrări ce se impun în vederea...

FOTO/ Scutul pădurii în Alba: Lemn fără acte confiscat de la o firmă din Lupşa
ziarulunirea.ro - Alba
În urma unor controale efectuate la o societate comercială şi la o persoană fizică autorizată în exploatarea de material lemnos, din comuna Lupşa, poliţiştii specializaţi în combaterea delictelor silvice au confiscat 234 de metri cubi de material lemnos. Controalele vor continua. La data de 28 noiembrie 2018, poliţiştii Serviciului de Ordine Publică din cadrul Inspectoratului […]

Andre Rieu sold out la Cluj în timp record. Ce ţeapă şi-au luat cei care s-au înghesuit
www.stiridecluj.ro - Cluj
Andre Rieu sold out la Cluj în timp record

Huliţi la Sibiu, vâlcenii sunt primiţi cu braţele deschise la Șelimbăr
revistapresei.oradesibiu.ro - Sibiu
Prin Sibiu circulă mitul cum că vâlcenii nu sunt prea bine primiţi. Se spune că sunt discriminaţi şi că se fac tot felul de glume pe seama lor şi a celor veniţi din sudul ţării, în general. Administraţia locală le este recunoscătoare. Mare parte dintre cei care au cumpărat locuinţe…

Weekend începe de joi la Cotton Pub – Trei seri fulminante cu trei DJ de top
revistapresei.oradesibiu.ro - Sibiu
Minivacanţa de 1 decembrie aduce şi la Cotton Pub mega surprize. Și dacă e vacanţă, să fie distracţie! Aşa că sărbătoarea începe încă de joi seara, când toţi cei cu numele de Andrei şi Andreea primesc din partea casei o sticlă de vin spumant. Toţi cei care vor veni în…

Andre Rieu sold out la Cluj în timp record
www.stiridecluj.ro - Cluj
Andre Rieu sold out la Cluj în timp record

Țigănaşu dă trezirea!
ph-online.ro - Prahova
,,Trebuie sa ne trezim!''. Asa a spus fundasul Țigănaşu, după eşecul de pe Clinceni Arena. El susţine că sunt obligaţi să-şi revină pentru că altfel v...

Marea Unire, sărbătorită la Şcoala „Tudor Vladimirescu”
ziarulargesul.ro - Argeş
Astăzi, cei 100 de ani de la înfăptuirea Marii Uniri de la Alba Iulia au fost sărbătoriţi atât la Şcoala "Tudor Vladimirescu" Piteşti, cât şi la Structura Nr. 2 din cadrul aceleiaşi instituţii de învăţământ. Centenarul a fost un prilej important pentru cadrele didactice şi elevii şcolii de a...

După ce a reclamat calul tatălui furat, unul din fii a aflat că fratele-ar fi vinovat
ziarharghita.ro - Harghita
La data de 27.11.2018, în jurul orei 17:00, Postul de Poliţie Corund a fost sesizat de un localnic despre faptul că, în aceeaşi zi, persoane necunoscute

Consiliul Local Baia Mare aproba contractarea unui imprumut de 24 milioane lei de la Ministerul Finantelor
ziarmm.ro - Maramureş
Consilierii locali baimareni au aprobat in sedinta ordinara de miercuri, 28 noiembrie, un proiect de hotarare care vizeaza contractarea unui imprumut in valoare de 24 milioane lei, in conformitate cu

Prefectura Neamţ: Despre programul Cornul şi laptele
www.stiri-neamt.ro - Neamţ
Urmare a Hotărârii Guvernului României nr. 640 din 7 septembrie 2017 s-a creat cadrul legal pentru aprobarea Programului pentru şcoli al României în

S-a CONFIRMAT dezastrul în România! Adevărul a ieşit la iveală
evz.ro - Bucureşti
Eurostat confirmă că România este pe ultimul loc în UE la cheltuielile pentru sănătate....

FOTO/ 17 poliţişti de la IPJ Alba avansaţi în grad, de Ziua Naţională a României
ziarulunirea.ro - Alba
Cu ocazia Zilei Naţionale a României, 17 poliţişti din cadrul Inspectoratului de Poliţie Judeţean Alba au fost avansaţi în gradul profesional următor, înaintea îndeplinirii stagiului minim. În cursul zilei de ieri, 28 noiembrie a.c., în cadrul unei şedinţe festive prilejuite de sărbătorirea, la IPJ Alba, a Zilei Naţionale a României, 1 Decembrie, 17 poliţişti au […]

ARȘINEL, decizie FINALĂ. Actorul român luat cea mai GREA HOTĂRÂRE din viaţa sa
evz.ro - Bucureşti
Alexrandru Arşinel, celebrul actor român, a luat o decizie finală. Acesta a decis să se retragă din activitatea sa, întrucât anii şi-au pus amprenta asupra ...

In premiera, sedinta Consiliului Local al municipiului Constanta are loc la Gara Maritima. Ce proiecte sunt pe ordinea de zi
www.ziuaconstanta.ro - Constanţa
Consiliul local al municipiului Constanta a fost convocat in sedinta ordinara astazi de la ora 14.00, la sediul Companiei Nationale Administratia Porturilor Maritime Constanta - Sala de Marmura a ...

Adevărata poveste a tatuatorului de la Auschwitz. Misterul numerelor verzi-albăstrui de pe braţele prizonierilor trimişi la moarte
evz.ro - Bucureşti
Editura Humanitas Fiction lansează astăzi, ora 19.00, la Librăria Humanitas de la Cişmigiu (Bd. Regina Elisabeta nr.38) romanul Tatuatorul de la Auschwitz d...

LOVITURĂ pentru BĂNCI. O NOUĂ CRIZĂ FINANCIARĂ? Percheziţiile DOVEDESC TOTUL
evz.ro - Bucureşti
Mai multe percheziţii au fost efectuate la sucursalele băncilor Deutsche Bank din oraşul Frankfurt. Acestea erau bănuite de spălare de bani....

Familia unui sportiv LEGENDAR vrea să părăsească România: „Este O RUȘINE pentru noi, ca oameni, ca oraş”
evz.ro - Bucureşti
Supărat pentru că a fost nevoit să-şi mute pub-ul la peluza stadionului „Ilie Oană”, Leonard Doroftei a anunţat că se gândeşte să plece din ţară. ...

1 DECEMBRIE: Clopotele BISERICILOR ORTODOXE din România vor răsuna în amintirea MARII UNIRI
ziarharghita.ro - Harghita
La 100 ani de la Marea Unire, sâmbătă, 1 Decembrie 2018, clopotele lăcaşurilor de cult ortodoxe din România vor răsuna la ora 10:00, timp de trei minute,

Presedintele Consiliului Judetean Constanta, Horia Tutuianu, anunt despre situatia Teatrului de Stat Constanta
www.ziuaconstanta.ro - Constanţa
Presedintele Consiliului Judetean Constanta a explicat joi, 29 noiembrie, in urma unei conferinte de presa sustinuta in Sala Remus Opreanu ca situatia de la Teatrul de Stat se apropie de final. In ...

În 30 noiembrie: Concertul ”Centenar”, la Alba Iulia – O paradă a celor mai desăvârşiti instrumentişti şi solişti reuniţi într-un eveniment muzical excepţional
ziarulunirea.ro - Alba
Pentru cei care aleg să petreacă sărbătoarea Centenarului la Alba Iulia, organizatorii au pregătit un moment special, o unire a tuturor punctelor cardinale muzicale. Pe scurt, în 30 noiembrie, la Casa de Cultură a Sindicatelor sunteţi invitaţi să ascultaţi cum sună Unirea. O paradă a celor mai desăvârşiţi instrumentişti şi solişti alături de cele mai […]

ANUNT LICITATIE: SC Mymob Myjob SRL scoate la vanyare un teren intravilan in comuna Topalu
www.ziuaconstanta.ro - Constanţa
SC Mymob Myjob SRL, prin lichidator, anunta vanzarea la licitatie publica a terenului intravilan in suprafata de 4.632 mp, situat in com Topalu, str. Soarelui, nr.710, jud. Constanta, inscris in CF 10223 a ...

VEȘTI BUNE pentru Români. Procesul de adopţie a fost SIMPLIFICAT
evz.ro - Bucureşti
Veste bună pentru cei care vor să adopte un copil. Senatul a adoptat, în plenul de miercuri, un proiect de lege care prevede debirocratizarea...

Se dau bani de la 1 ianuarie! Mii de români vor beneficia-Vezi dacă eşti pe LISTĂ
evz.ro - Bucureşti
Se dau bani de 1 Ianuarie! Guvernul a aprobat, în şedinţa de astăzi, o ordonanţă de urgenţă care majorează semnificativ, de la 1 ianuarie 2019, valoarea indemnizaţiilor prevăzute de Legea nr. 49/1991 pentru invalizii, veteranii şi văduvele de război....

Neamţ: Încă o reţinere în cazul jafului de la Zăneşti
www.stiri-neamt.ro - Neamţ
Un bărbat din Mureş a fost reţinut de poliţişti, fiind bănuit de comiterea infracţiunii de furt calificat. Anterior, în cadrul aceluiaşi dosar au mai fost

Expoziţia „100 de flori, 100 de ani”, vernisată în Palatul Administrativ
www.zi-de-zi.ro - Mureş
Asociaţia Artiştilor Plastici Mureş propune iubitorilor de frumos o inedită expoziţie de pictură, in

Autobuze deviate, in Ploiesti, pe 1 decembrie. Vezi rutele ocolitoare
ph-online.ro - Prahova
Pe data de 1 decembrie 2018, intre orele 09:45 – 14:00 se inchide circulatia rutiera intre intersectia str.Pta. Victoriei cu T...

Proiectele de acte normative care ar putea fi incluse pe agenda şedinţei Guvernului României din 29 noiembrie 2018
www.oltenasul.ro - Dolj
Related Posts via CategoriesSenatorul Lavinia Craioveanu participă la “Forumul Global al Femeilor Lider”Alexandra Presură, propunere legislativă pentru copiii ce nu deţin cod numeric personalASOCIATIA TINERILOR CU INITIATIVA DIN ZONA OLTENIEI – Stop excluziunii sociale a tinerilor defavorizaţi! – Proiect finanţat din fondurile bugetului judeţului Dolj, alocate pentru activităţi non-profitJandarmii prezenţi la datorie cu ocazia Zilei Naţionale a RomânieiMesajul preşedintelui Consiliului […]

Sfârşit de săptămână sub semnul Centenarului, la cel mai mare mall din Timişoara
www.tion.ro - Timiş
În acest final de săptămână, timişorenii sunt aşteptaţi să sărbătorească împreună Ziua Naţională a României şi Centenarul Marii Uniri, la principalul centru comercial din Timişoara. Ei vor afla cine sunt românii valoroşi care au marcat lumea şi îşi pot crea amintiri frumoase, la photo corner-ul tematic. Și pentru că debutează luna cadourilor, evenimentele speciale vor continua la Iulius Mall întregul week-end.

Delegatie prahoveana la Targul Pollutec din Lyon: Consulul Anca Opris i-a invitat pe ploiesteni la dezbaterea "Aglomeratie urbana", in 2019
ph-online.ro - Prahova
Delegatia prahoveana aflata la targul Pollutec -2018 de la Lyon a partcipat la simpozionul cu tema “Aglomerari urbane-exemplul Lyon” in pregatirea int...

Câştigătorii concursului dedicat CENTENARULUI MARII UNIRI de la 1918 „Uniţi în cuget şi-n simţiri”
ziarharghita.ro - Harghita
Întru cinstirea Centenarului Marii Uniri şi a eroilor Primului Război Mondial, Asociaţia Virtus Vivens, cu sprijinul Instituţiei Prefectului Judeţul

Tişe – Guvernul nu vrea să facă Spitalul Regional pentru că nu are bani
feedproxy.google.com - Cluj
Preşedintele Alin Tişe, nu renunţă la Spitalul regional de Urgenţă. CJ Cluj ar putea deveni eligibil să se ocupe de acest proiect

Victorie de serviciu pentru handbaliştii de la SCM Poli. Alb-violeţii rămân pe podium
expressdebanat.ro - Caraş-Severin
SCM Poli Timişoara s-a impus cu CSM Focşani, în penultima etapă a turului de campionat, la scorul de 33-29. Cu acest rezultat, Poli ajunge la 25 de puncte şi rămâne pe locul 3 în Liga Zimbrilor. Timişoara a jucat bine în apărare din prima repriză, atât pe semicerc, dar şi datorită intervenţiilor portarului Cristian Tcaciuc.…

“Ma lupt cu mine”
www.infobraila.ro - Brăila
Comentarii comentariu

Senatorul Lavinia Craioveanu participă la “Forumul Global al Femeilor Lider”
www.oltenasul.ro - Dolj
Related Posts via CategoriesAlexandra Presură, propunere legislativă pentru copiii ce nu deţin cod numeric personalDeputat PSD Dolj, Alina-Elena TĂNĂSESCU: Cabinetele medicilor de familie, cele de medicină dentară, ambulatoriile de specialitate, exceptate de la prevederile Legii nr. 185/2017ALDE DOLJ: REAFIRMĂM NEVOIA UNUI ”ARMISTIȚIU”POLITICALDE DOLJ: TINERII DIN ALDE CAUTĂ SOLUȚII INTELIGENTE PENTRU MODERNIZAREA ORAȘELORALDE DOLJ: CĂLIN POPESCU TĂRICEANU – PROFIL CONSOLIDAT DE […]

Sezonul gripelor – Câţi sibieni au ajuns până acum la spital
revistapresei.oradesibiu.ro - Sibiu
În cadrul Sistemului de supraveghere de rutină a infecţiilor respiratorii şi a gripei, la nivelul judeţului Sibiu, în săptămâna precedentă (19.11.2018 – 25.11.2018) a crescut uşor numărul Infecţiilor Respiratorii Acute (2275), cu circa 5.42% faţă de cazurile din săptămâna anterioară de raportare (2158), fiind cu 16.97% mai mare faţă de…

FOTO Accident pe Strada Avrig. Șoferului i s-a făcut rău
revistapresei.oradesibiu.ro - Sibiu
Joi, în jurul amiezii, două autoturisme au fost implicate într-un eveniment de circulaţie din cauza nepăstrării distanţei regulamentare. În urma impactului nimeni nu a fost rănit, dar după 10 minute şoferului vinovat i s-a făcut rău. La faţa locului a venit un echipaj SMURD care i-a acordat primele îngrijiri medicale.…

Mircea Baniciu îl vrea pe Emil Boc primar în Bucureşti. Ce a spus Dan Bittman - VIDEO
www.stiridecluj.ro - Cluj
Mircea Baniciu îl vrea pe Emil Boc primar în Bucureşti. Ce a spus Dan Bittman - VIDEO

Monumentul Facebook: La Alba Iulia, un monument dedicat Unirii seamănă cu sigla reţelei de socializare (VIDEO)
www.ebihoreanul.ro - Bihor
Înainte de sărbătoarea Marii Uniri, la Alba Iulia au fost date jos schelele de pe monumentul anume ridicat şi dedicat Centenarului. Construcţia este însă controversată, deoarece, pe lângă că a costat mult, peste 10 milioane de lei, seamănă mai degrabă cu logo-ul Facebook.

ACS Poli, aproape să se despartă de un jucător străin!
expressdebanat.ro - Caraş-Severin
După ce au făcut 2 puncte şi dau semne de redresare, cei de la ACS Poli vor pierde din nou un jucător. Din informaţiile noastre, clubul va rezilia contractul cu fundaşul Igor Basic, deoarece sârbul a depăşit cele 90 de zile şi nu este în regulă cu documentele. Cetăţeni sârbi pot sta, legal, în România…

Alexandra Presura, propunere legislativă pentru copiii ce nu deţin cod numeric personal
www.oltenasul.ro - Dolj
Related Posts via CategoriesDeputat PSD Dolj, Alina-Elena TĂNĂSESCU: Cabinetele medicilor de familie, cele de medicină dentară, ambulatoriile de specialitate, exceptate de la prevederile Legii nr. 185/2017ALDE DOLJ: REAFIRMĂM NEVOIA UNUI ”ARMISTIȚIU”POLITICALDE DOLJ: TINERII DIN ALDE CAUTĂ SOLUȚII INTELIGENTE PENTRU MODERNIZAREA ORAȘELORALDE DOLJ: CĂLIN POPESCU TĂRICEANU – PROFIL CONSOLIDAT DE PREZIDENȚIABILMarian- Jean Marinescu: Solicit ca proiectele de spitale regionale să fie […]

Pensii. CE SE ÎNTÂMPLĂ din 2021? SENATORII AU DECIS pentru români. CINE PIERDE? Breaking news social
evz.ro - Bucureşti
Un nou proiect privind sistemul de pensii din România a fost adoptat recent de Guvern. Modificările ar trebui să intre în vigoare începând cu anul 2021 când...

Putin acţionează chiar de 1 Decembrie. PLANETA, ATENTĂ LA RUSIA. Soarta omenirii, în joc! Breaking news
evz.ro - Bucureşti
Întrevederea tête-à-tête dintre preşedintele rus, Vladimir Putin, şi omologul său american, Donald Tramp, va avea loc la 17:30, ora Moscovei, la data de 1 d...

Între cer şi pămînt, un roman al despărţirii de moarte. Jón Kalman Stefánsson la Bucureşti
evz.ro - Bucureşti
Marţi, 4 decembrie, la ora 18.00, îl puteţi întîlni pe unul dintre cei mai îndrăgiţi scriitori europeni ai momentului la Café Verona Bucureşti (Cărtureşti, ...

Dublu Centenar la Caransebeş, cu prilejul organizării Cercului Pedagogic al Profesorilor de Limba şi Literatura Română
expressdebanat.ro - Caraş-Severin
La Colegiul Naţional „Traian Doda” din Caransebeş, sub înaltele şi solemnele auspicii ale sărbătoririi Centenarului Marii Uniri, s-a desfăşurat, zilele trecute, Cercul Pedagogic al profesorilor de Limba şi Literatura Română cu titlul „România 100 – 100 de ani de şcoală Caraş-Severineană”. Locaţia nu a fost aleasă întâmplător, deoarece anul 2018 marchează deopotrivă împlinirea a 100…

Un nou raport european în vederea stopării fenomenului de „exod al creierelor”
ziarharghita.ro - Harghita
Noul mandat de raportor al lui Borboly Csaba a fost votat cu unanimitate Borboly Csaba, preşedintele Consiliului Judeţean Harghita va elabora în calitate

Programul “gROwth– Contul individual de economii Junior Centenar”, aprobat prin Ordonanţă de Urgenţă
ziarulteleormanul.ro - Teleorman
Executivul a adoptat astăzi Ordonanţa de urgenţă privind implementarea Programului guvernamental “gROwth– Contul individual de economii Junior Centenar”, care are ca principal obiectiv asigurarea de către stat pentru toţi copiii din România a unui sprijin financiar, astfel încât, atunci când aceştia vor împlini vârsta de 18 ani, să aibă într-un cont o sumă de bani suficientă pentru educaţie, pregătire profesională sau pentru orice alte necesităţi. Programul îşi propune să stimuleze pe toţi părinţii, ca împreună cu statul, să contribuie la acest cont de economie al copiilor. În aces

METEO: Atenţionare de vreme deosebit de rece, până pe 2 decembrie
www.gazetadambovitei.ro - Dâmboviţa
ACTUALIZARE INFORMARE METEOROLOGICĂ Fenomene vizate: vreme deosebit de rece Interval de valabilitate: 29 noiembrie, ora 14 – 02 decembrie, ora

Program modificat la Evidenţa Persoanelor din Sibiu în minivacanţă – Când se pot declara decesele
revistapresei.oradesibiu.ro - Sibiu
Serviciul Public Comunitar de Evidenţă a Persoanelor Sibiu - Serviciul Stare Civilă informează cetăţenii municipiului că zilele de 30 noiembrie şi 1 decembrie au fost declarate zile de sărbătoare legală în care nu se lucrează. În consecinţă, personalul Serviciului Stare Civilă - decese din cadrul Serviciului Public Comunitar de Evidenţă…

Avansări în grad la Jandarmeria Satu Mare, de Ziua Naţională
portalsm.ro - Satu Mare
Avansări în grad la Jandarmeria Satu Mare, de Ziua Naţională

Neamţ: Bărbat găsit decedat. Cadavrul, descoperit la 12 ore de la deces
www.stiri-neamt.ro - Neamţ
Cadavrul unui bărbat de 57 de ani a fost găsit miercuri, 28 noiembrie, în jurul orei 8:00, pe un teren viran, de nişte tineri din localitatea Țolici

ASOCIATIA TINERILOR CU INITIATIVA DIN ZONA OLTENIEI – Stop excluziunii sociale a tinerilor defavorizaţi! – Proiect finanţat din fondurile bugetului judeţului Dolj, alocate pentru activităţi non-profit
www.oltenasul.ro - Dolj
Related Posts via CategoriesJandarmii prezenţi la datorie cu ocazia Zilei Naţionale a RomânieiMesajul preşedintelui Consiliului Judeţean Dolj, Ion Prioteasa, cu prilejul evenimentului „Doljul celebrează Eroii Reîntregirii Neamului”Primăria Craiova: CRAIOVA CELEBREAZĂ CENTENARULPrefectura Dolj: PROGRAMUL desfăşurării ceremoniei militar – religioasă şi a paradei militare locale din ziua de 1 Decembrie 2018 , ZIUA NAŢIONALĂ A ROMÂNIEICentrele de Relatii cu Clientii ale Grupului […]

Proiect de ucenicie şi stagii pentru şomerii non-NEET din Regiunile mai puţin Dezvoltate, implementat de ANOFM
ziarharghita.ro - Harghita
Agenţia Naţională pentru Ocuparea Forţei de Muncă (ANOFM) implementează pe o perioadă de 32 de luni, proiectul „UNIT 4 RMPD – Ucenicie şi stagii pentru

Atenţie! Milioane de români sunt vizaţi! Cine va primi 600 lei
evz.ro - Bucureşti
Milioane de români ar avea de beneficiat de pe urma noii ordonanȚe de urgenţă pe care o va adopta astĂzi Executivul condus de Viorica Dăncilă....

Se pregăteşte O MUTARE-BOMBĂ ÎN MEDIA din România? Omul lui Trump, şeful Euronews şi un MOGUL s-au întâlnit
evz.ro - Bucureşti
Michael Peters, bossul gigantului Euronews, şi Mark Robertson, „omul” lui Donald Trump, au aterizat în secret la Bucureşti, unde s-au întâlnit cu Cozmin Guş...

CUTREMUR în Justiţie: Dragnea detonează BOMBA! Se întâmplă în IANUARIE
evz.ro - Bucureşti
PSD este hotărât să dea OUG pe amnistie şi graţiere, conform informaţiilor digi24.ro....

Sute de persoane salvate in judetul Constanta in timpul ninsorii. Bilantul activitatilor de deszapezire
www.ziuaconstanta.ro - Constanţa
Presedintele Consiliului Judetean Constanta, Marius Horia Tutuianu si administratorul special al RAJDP Constanta, Lucian Lungoci sustin o conferinta de presa cu tema bilantul actiunilor de ...

Veşti noi despre muncitorul prins sub un mal de pământ
revistapresei.oradesibiu.ro - Sibiu
Bărbatul de 40 de ani accidentat la locul de muncă joi dimineaţa a fost detubat şi dus la terapie intensivă. Muncitorul ar fi intrat în comă, la scurt timp după ce a fost descarcerat de pompieri. Potrivit medicilor, de cum a ajuns la spital, omul a fost intubat. A fost…

Bebeluş născut prematur la Satu Mare. Are doar 1,2 kg!
portalsm.ro - Satu Mare
Bebeluş născut prematur la Satu Mare. Are doar 1,2 kg!

Sub auspiciile Filialei Constanta a Societatii de Stiinte Istorice din Romania: La scolile Ciprian Porumbescu din Constanta si Mihail Sadoveanu din Medgidia s-a omagiat Centenarul Bucovinei
www.ziuaconstanta.ro - Constanţa
La Scoala Gimnaziala nr. 3 Ciprian Porumbescu a avut loc ieri o serbare omagiala, sugestiv intitulata Dulce Bucovina, dulce Romanie! , ofranda afectiv-testimoniala pentru 1 Decembrie Ziua ...

Se deschid conturi pentru copii. Părinţii pot depune bani, statul contribuie cu o primă anuală
www.timponline.ro - Bistriţa-Năsăud
Guvernul a adoptat o Ordonanţă de Urgenţă privind implementarea Programului ”gROwth – Contul individual de economii Junior Centenar”, care are ca principal obiectiv asigurarea de către stat pentru toţi copiii din România a unui sprijin financiar, astfel încât, atunci când aceştia vor împlini vârsta

Jandarmii prezenţi la datorie cu ocazia Zilei Naţionale a României
www.oltenasul.ro - Dolj
Related Posts via CategoriesMesajul preşedintelui Consiliului Judeţean Dolj, Ion Prioteasa, cu prilejul evenimentului „Doljul celebrează Eroii Reîntregirii Neamului”Primăria Craiova: CRAIOVA CELEBREAZĂ CENTENARULPrefectura Dolj: PROGRAMUL desfăşurării ceremoniei militar – religioasă şi a paradei militare locale din ziua de 1 Decembrie 2018 , ZIUA NAŢIONALĂ A ROMÂNIEICentrele de Relatii cu Clientii ale Grupului CEZ in Romania nu vor avea program de lucru […]

Vineri, CSM Școlar Reşiţa – Industria Galda de Jos | Greu în Valea Domanului…
ziarulunirea.ro - Alba
Industria Galda de Jos va încheia cel mai modest tur petrecut în eşalonul terţ cu o deplasare extrem de dificilă în Valea Domanului, vineri, 30 noiembrie, de la ora 14.00. În faţa formaţiei pregătite de Paul Ciucă stă CSM Școlar Reşiţa (locul 7, cu 23 de puncte), cea mai în formă echipă a Seriei a […]

Cade cortina şi peste Liga III
www.zi-de-zi.ro - Mureş
Vineri, 30 noiembrie, de la ora 14.00 se dispută partidele din cadrul ultimei etape di Liga III de f

Putin acţionează chiar de 1 Decembrie. PLANETA, ATENTĂ LA RUSIA. Soarta omenirii, în joc, Breaking news
evz.ro - Bucureşti
Întrevederea tête-à-tête dintre preşedintele rus, Vladimir Putin, şi omologul său american, Donald Tramp, va avea loc la 17:30, ora Moscovei, la data de 1 d...

Întâlnire cu Dan Lungu la Bucureşti şi Iaşi: lansarea romanului Pâlpâiri
evz.ro - Bucureşti
Joi, 29 noiembrie, ora 19.00, în Mansarda Librăriei Cărtureşti Verona din Bucureşti (Str. Arthur Pictor Verona 13-15), va avea loc lansarea romanului Pâlpâi...

LIVE VIDEO/ FOTO: A doua zi de repetiţii pentru PARADA militară de 1 Decembrie, de la Alba Iulia
ziarulunirea.ro - Alba
A doua repetiţie pentru Parada militară de Ziua Naţională a început, joi, în zona Bulevardului 1 Decembrie 1918 din Alba Iulia. Sunt 23 de detaşamente de defilare pe jos cu aproximativ 1.600 de persoane din Ministerul Apărării Naţionale (Statul Major al Forţelor Terestre, Statul Major al Forţelor Aeriene, Comandamentul Comunicaţiilor şi Informaticii şi Comandamentul pentru […]

Vremea. GERUL loveşte România. ZECI DE GRADE iau SEMNUL NEGATIV
evz.ro - Bucureşti
Vremea. Alerta de ger ajunge şi în România. Zeci de grade iau semnul negativ, totul fiind îngheţat. Deja au fost înregistrate şi -16 grade Celsius....

CJ Timiş îşi face din nou ziar. Dobra: Nu o să apar eu cu poza pe toate paginile
www.tion.ro - Timiş
Agenda Consiliului Judeţean Timiş revine în forţă după mai bine de doi ani de absenţă... Consilierii judeţeni din cel mai vestic judeţ al ţării au aprobat editarea şi tipărirea unui ziar lunar, în 100.000 de exemplare, care să reflecte activitatea Consiliului Judeţean Timiş.

Timişoara Film Society iubeşte Timişoara
www.tion.ro - Timiş
Asociaţia Iubesc Timişoara, în parteneriat cu Timişoara Film Society, va găzdui, pentru al doilea an consecutiv în această formulă, evenimentul care îi poartă numele: Iubesc Timişoara.

Camion în flăcări pe DN14 – Este plin cu rumeguş
revistapresei.oradesibiu.ro - Sibiu
Un camion plin cu rumeguş a luat foc într-o parcare de la intrare în Șura Mare, dinspre Sibiu. La faţa locului au ajuns două echipaje de pompieri şi un echipaj SMURD. Nu sunt victime, iar focul nu riscă să se extindă. Traficul se desfăşoară normal în zonă.

Jandarm ARGEŞEAN decorat de Ministerul Afacerilor Interne
ziarulargesul.ro - Argeş
Cu prilejul aniversării Centenarului Marii Uniri şi pentru acordarea respectului cuvenit, în cadrul unei ceremonii organizate la sediul Ministerului Afacerilor Interne, plutonier Şugubete George - Mădalin, subofiţer operativ principal în cadrul Inspectoratului de Jandarmi Judeţean Argeş, a fost...

(Foto) Baia Mare: “100 de inimi canta Unirea” la Scoala Generala “Avram Iancu”
ziarmm.ro - Maramureş
"100 de inimi canta Unirea" este titlul activitatii dedicate Centenarului Marii Uniri la care au participat elevii claselor a I-a A, a II-a A, a II-a C si a IV-a A de la Scoala Gimnaziala " Avram Ianc

Restricţii de trafic de Centenar în judeţul Satu Mare. Anunţul Poliţiei
portalsm.ro - Satu Mare
Restricţii de trafic de Centenar în judeţul Satu Mare. Anunţul Poliţiei

PREMIERĂ în România. Aceşti ANGAJAŢI vor avea SALARIU minim diferenţiat. CRIZA a condus la asta
evz.ro - Bucureşti
Prim-ministrul României, Viorica Dăncilă, a anunţat astăzi că domeniul construcţiilor va fi declarat

Rusia blocheaza porturi ucrainene de la Marea Azov, anunta un ministru ucrainean
ziarmm.ro - Maramureş
Doua porturi ucrainene de la Marea Azov, Berdiansk si Mariupol, sunt efectiv blocate de Rusia in timp ce navele au interdictie sa plece si sa intre, a anuntat joi ministrul ucrainean al infrastructuri

Programul S.C. VITAL S.A. in 30 noiembrie 2018
ziarmm.ro - Maramureş
Vineri, 30 noiembrie 2018, casieriile S.C. VITAL S.A. din toate localitatile in care operam: Baia Mare, Baia Sprie, Sighetu Marmatiei, Viseu de Sus, Targu Lapus, Tautii Magheraus, Seini, Cavnic, Somcu

Judecătorii au amânat sentinţa definitivă în procesul lui Kiss şi Beni Rus. Avocaţii erau pregătiţi să sărbătorească...
www.ebihoreanul.ro - Bihor
Completul de judecată al Curţii de Apel Oradea care soluţionează cel mai important dosar de corupţie din Bihor, avându-i ca protagonişti pe fostul şef al Consiliului Judeţean şi al UDMR Bihor Alexandru Kiss şi pe proprietarul grupului de firme Selina, Beniamin Rus, a amânat, joi, pronunţarea sentinţei. Deşi inculpaţii au lipsit, avocaţii lor erau pregătiţi să sărbătorească, mizând pe anularea condamnărilor stabilite anterior de Tribunal şi pe rejudecarea procesului de la zero, ceea ce ar fi permis prescrierea răspunderii din cauza vechimii faptelor.

Programul Cimitirului Minicipal în minivacanţă – Acces gratuit pentru maşini
revistapresei.oradesibiu.ro - Sibiu
Serviciul Public Administrarea Cimitirului Municipal Sibiu informează cetăţenii municipiului faptul că zilele de 30 noiembrie şi 1 decembrie au fost declarate zile de sărbătoare legală în care nu se lucrează. În consecinţă, personalul Serviciului Public Administrarea Cimitirului Municipal Sibiu îşi va desfăşura activitatea după următorul program: VINERI 30 noiembrie 2018…

Siegfried Mureşan „este omul Serviciilor”: „Nu l-am adus noi în PMP l-au adus Serviciile şi ni l-au băgat pe gât”. Video în articol
evz.ro - Bucureşti
Declaraţii şocante vin din partea fostul consilier prezidenţial Adrian Rădulescu care a declarat aseară la Canal 33, în emisiunea realizată de Horia Alexand...

Aleretă. A dispărut după ce a plecat la şcoală
evz.ro - Bucureşti
O fată de 14 ani din Timiş este căutată de poliţişti. Conform familiei, ea nu s-a mai întors acasă, ieri, după ore....

Mesajul preşedintelui Consiliului Judeţean Dolj, Ion Prioteasa, cu prilejul evenimentului „Doljul celebrează Eroii Reîntregirii Neamului”
www.oltenasul.ro - Dolj
Related Posts via CategoriesPrimăria Craiova: CRAIOVA CELEBREAZĂ CENTENARULPrefectura Dolj: PROGRAMUL desfăşurării ceremoniei militar – religioasă şi a paradei militare locale din ziua de 1 Decembrie 2018 , ZIUA NAŢIONALĂ A ROMÂNIEICentrele de Relatii cu Clientii ale Grupului CEZ in Romania nu vor avea program de lucru cu publicul in data de 30 noiembrie 2018, reluandu-si activitatea in data de 03 […]

VIDEO/ Premierul Dăncilă, după şedinţa solemnă a Guvernului de la Sala Unirii: ”Este un moment emoţionant, pe care ni l-am dorit toţi membrii Guvernului”
ziarulunirea.ro - Alba
Premierul României, Viorica Dăncilă a declarat, joi, la finalul şedinţei solemne a Guvernului, care s-a desfăşurat, joi, la Sala Unirii, că a participat la un moment emoţionant, pe care şi l-au dorit toţi membrii Guvernului. ”Cred că acum, la 100 de ani de la Marea Unire, trebuie să ne gândim la sărbătorirea idealului naţional, la […]

Finalizare proiect – INTERMEDIA GROUP SRL”
www.zi-de-zi.ro - Mureş

Premierul Viorica Dancila: Guvernul are in vedere cresterea sumelor destinate finantarii Educatiei
www.ziuaconstanta.ro - Constanţa
Guvernul are in vedere cresterea sumelor destinate finantarii Educatiei cu cel putin 15 anual fata de bugetul anului precedent, astfel incat sa se ajunga la cel putin 6 din PIB, a declarat, joi, ...

Amendă de 12.000 de lei pentru un veterinar din Satu Mare. A sfidat autorităţile
portalsm.ro - Satu Mare
Amendă de 12.000 de lei pentru un veterinar din Satu Mare. A sfidat autorităţile

Primăria Craiova: CRAIOVA CELEBREAZĂ CENTENARUL
www.oltenasul.ro - Dolj
Related Posts via CategoriesPrimăria Municipiului Craiova invită toţi craiovenii la manifestările prilejuite de Ziua României precum şi de Centenarul Marii Uniri ce vor avea loc Sâmbătă, 1 Decembrie 2018Preşedintele Consiliului Judeţean (CJ) Dolj, Ion Prioteasa, şi preşedintele Consiliului Raional Cimişlia, Iovu Bivol, au semnat miercuri, în plenul şedinţei CJ, acordul de înfrăţireCJ Dolj: A început a 41-a ediţie a Târgului […]

Neamţ: Dus la închisoare pentru că şi-a înjunghiat copilul
www.stiri-neamt.ro - Neamţ
La data de 28 noiembrie, poliţiştii Secţiei de Poliţie Ion Creangă au depistat un bărbat de 62 de ani, din Pânceşti, pe numele căruia era emis de

Muzeul oraşului Oradea. Expoziţie de fotografii privind familia regală a României pe frontul Marelui Război
www.ebihoreanul.ro - Bihor
Muzeul Oraşului Oradea organizează vineri, de la ora 15, în corpul A din incinta Cetăţii vernisajul expoziţiei fotodocumentare „Familia regală a României pe frontul Marelui Război (1916 - 1918)”. Expoziţia cu peste 70 de fotografii este dedicată familiei regale Ferdinand şi Maria şi omagiază victoriile militare ale armatei române de la Mărăşti, Mărşeşti şi Oituz.

VIDEO: Scandări împotriva Guvernului şi huiduieli la ieşirea din Sala Unirii de la Alba Iulia
ziarulunirea.ro - Alba
Premierul Viorica Dăncilă şi miniştrii prezenţi, joi, la Alba Iulia, au avut parte de huiduieli şi la ieşirea de la Sala Unirii, unde a avut loc şedinţa solemnă a Guvernului. De altfel, şi înainte de şedinţă, aceiaşi protestatari au scandat împotriva Executivului înainte de ceremonialul de depunere a unei coroane de flori la statuia voievodului […]

Accident rutier pe bulevardul Tomis din municipiul Constanta. Un pieton a fost ranit
www.ziuaconstanta.ro - Constanţa
Un accident rutier a avut loc astazi pe bulevardul Tomis din municipiul Constanta. Din primele informatii un pieton a fost ranit. Cadrele medicale de la ambulanta au fost chemate in ajutorul ...

Prefectura Dolj: PROGRAMUL desfăşurării ceremoniei militar – religioasă şi a paradei militare locale din ziua de 1 Decembrie 2018 , ZIUA NAŢIONALĂ A ROMÂNIEI
www.oltenasul.ro - Dolj
Related Posts via CategoriesPrimăria Municipiului Craiova invită toţi craiovenii la manifestările prilejuite de Ziua României precum şi de Centenarul Marii Uniri ce vor avea loc Sâmbătă, 1 Decembrie 2018Din cauza unei avarii apărute la cazanul energetic nr.2 al Complexului Energetic Oltenia – Sucursala Electrocentrale II, Societatea Termo Craiova SRL se află în imposibilitatea de a furniza căldură populaţiei Municipiului CraiovaPiaţa […]

Cine sunt adversarii HC Dobrogea Sud Constanta din grupa C a Cupei EHF
www.ziuaconstanta.ro - Constanţa
Echipa masculina de handbal HC Dobrogea Sud Constanta si-a aflat astazi adversarele din grupa Cupei EHF. Tragerea la sorti a avut loc la Viena, iar formatia de pe litoral a fost repartizata in grupa ...

VIDEO: Convoiul de căruţe ”DRUMUL UNIRII” a ajuns în AIUD. Maramureşenii şi aiudenii au cântat într-un glas DEȘTEAPTĂ-TE ROMÂNE!
ziarulunirea.ro - Alba
Un convoi format din zece căruţe trase de câte doi cai şi însoţitorii lor au plecat, joi, din localitatea Apşa de Jos, din Maramureşul Istoric, Ucraina spre Alba Iulia pe un traseu care măsoară peste 300 de kilometri, refăcând acelaşi drum al străbunilor maramureşeni care au participat la Marea Unire din 1918. Joi, 28 noiembrie, […]

Adolescent bătut cu bestialitate în Parcul Cetăţii din Sibiu – I-au scos dinţii!
revistapresei.oradesibiu.ro - Sibiu
Un tânăr de 16 ani a trecut prin momente cumplite miercuri după-amiaza după ce a ieşit de la şcoală. A fost bătut de patru tineri în centrul Sibiului, în Parcul Cetăţii. Băiatul este elev la colegiul Octavian Goga. După cursuri se plimba cu o colegă prin Parcul Cetăţii. S-au aşezat…

Viktor Orban l-a primit pe Chuck Norris în Ungaria: Sunt un luptător de stradă. Liberalii mă urăsc
ziarharghita.ro - Harghita
Viktor Orban, premierul Ungariei, l-a primit în vizită pe Chuck Norris, pe care l-a plimbat cu maşina şi i-a arătat cum se antrenează trupele speciale

Caz socant la gradinita. O fetita nu a fost primita la serbarea de 1 Decembrie. Incredibil de ce a luat educatoarea aceasta decizie
www.ziuaconstanta.ro - Constanţa
O fetita de patru ani a fost data afara de la serbarea de la gradinita pe motiv ca nu avea costum popular. Decizia a fost luata de educatoare, conform Antena3.ro Acest lucru s-a petrecut la o ...

Sărbătorile de iarnă se petrec în familie! Centrele pentru bătrâni nu reprezintă soluţia ideală
expressdebanat.ro - Caraş-Severin
Singurătatea - boala secolului 21 s-a extins ca o molimă, dezvoltând stări de anxietate, tristeţe şi chiar atacuri de panică mai ales pentru vârsnicii „uitaţi” în căminele pentru bătrâni. Promedica24 aduce zâmbete pe chipurile acestora

ACCIDENT RUTIER provocat de un ȘOFER BĂUT. A pierdut CONTROLUL maşinii şi a intrat pe CONTRASENS
newsar.ro - Arad
Citeşte azi ce scriu ziarele de mâine!

Centrele de Relatii cu Clientii ale Grupului CEZ in Romania nu vor avea program de lucru cu publicul in data de 30 noiembrie 2018, reluandu-si activitatea in data de 03 decembrie 2018
www.oltenasul.ro - Dolj
Related Posts via CategoriesPrimăria Craiova: Restricţii rutiere pentru meciul dintre echipele CS UNIVERSITATEA CRAIOVA şi DUNĂREA CĂLĂRAŞI ce va avea loc în ziua de 02.12.2018, pe stadionul „Ion Oblemenco” din municipiul CraiovaPrimăria Craiova: Restricţii de circulaţie în centru, pe 30 noiembrie şi 1 decembrieBiblioteca Judeţeană „Alexandru şi Aristia Aman” găzduieşte joi, 29 noiembrie, în sala „Acad. Dinu C. Giurescu”, începând […]

GALERIE FOTO: Avansări în grad la IPJ Vrancea, cu ocazia Zilei Naţionale a României
www.jurnaldevrancea.ro - Vrancea
Cu ocazia Zilei Naţionale a României, 17 poliţişti din cadrul Inspectoratului de Poliţie Judeţean Vrancea au fost avansaţi în gradul profesional următor, | Jurnal de Vrancea

Mai multi magistrati, eliberati din functii de presedintele Romaniei, Klaus Iohannis
www.ziuaconstanta.ro - Constanţa
Presedintele Romaniei, Klaus Iohannis, a semnat miercuri, 28 noiembrie a.c., urmatoarele decrete Decret privind eliberarea din functia de judecator la Inalta Curte de Casatie si Justitie a ...

Serviciul de Stare Civila Constanta. Publicatii de casatorie 28 noiembrie 2018
www.ziuaconstanta.ro - Constanţa
Funda Radu Tonea Georgiana Ramona Sola Nicolae Bratu Teona-Daniela Sabareanu Ciprian-Emanuel Keusch Ingrid Balas Razvan Ionita Akten Pavel Ciprian Pena Marinela Deoarece suntem un ...

Primăria Craiova: Restricţii rutiere pentru meciul dintre echipele CS UNIVERSITATEA CRAIOVA şi DUNĂREA CĂLĂRAŞI ce va avea loc în ziua de 02.12.2018, pe stadionul „Ion Oblemenco” din municipiul Craiova
www.oltenasul.ro - Dolj
Related Posts via CategoriesPrimăria Craiova: Restricţii de circulaţie în centru, pe 30 noiembrie şi 1 decembrieBiblioteca Judeţeană „Alexandru şi Aristia Aman” găzduieşte joi, 29 noiembrie, în sala „Acad. Dinu C. Giurescu”, începând cu ora 17:00, lansarea volumului „Cântece de ani 1913-1918”, autor Elena MirescuExpoziţie de pictură – Case şi tradiţii româneştiProgramul Muzeului Olteniei, în perioada 30 noiembrie – 2 decembrie […]

INCIDENTE la Catedrala Neamului. Oamenii au RUPT GARDURILE şi au dat NĂVALĂ la ALTAR
evz.ro - Bucureşti
Incidente la Catedrala Mântuirii Neamului. Oamenii au distrus gardurile şi s-au îmbulzit spre altar, rupând rândurile de jandarmi....

S-a aflat cine este tânărul ROMÂN care a murit în Cambodgia
evz.ro - Bucureşti
Aşa cum se ştie deja MAE a confirmat că un român a murit într-un accident maritim care s-a produs în provincia Sihanouk. Două ambarcaţiuni s-au ciocnit în s...

Scene violente la Catedrala Manturii Neamului. Credinciosii s-au imbrancit cu jandarmii pentru a intra in lacasul de cult
www.ziuaconstanta.ro - Constanţa
Au fost scene violente astazi la Catedrala Manturii Neamului. Potrivit Antena3.ro, dupa ce in weekend oamenii s-au inghesuit la sfintirea locasului de cult, astazi credinciosii au rupt cordoanele de ...

Program 1 Decembrie 2018 la Cluj. Ce concerte sunt şi unde are loc focul de artificii
www.stiridecluj.ro - Cluj
Program 1 Decembrie 2018 la Cluj. Ce concerte sunt şi unde are loc focul de artificii

Direcţia pentru Cultură: Digitizarea monumentelor eroilor, expunere online a patrimonului
www.timponline.ro - Bistriţa-Năsăud
Direcţia Judeţeană pentru Cultură (DJC) Bistriţa-Năsăud, instituţie condusă de Alexandru Uiuiu, lansează platforma online ”Digitizarea Monumentelor Eroilor din Primul Război Mondial din Bistriţa-Năsăud”, pe domeniul ’’patrimoniubn.ro’’, pentru a omagia eroii din Marele Război.
Platforma online este

Program 1 Decembrie 2018 la Cluj. Ce concerte sunt şi unde are loc focul de artificii
www.stiridecluj.ro - Cluj
Program 1 Decembrie 2018 la Cluj. Ce concerte sunt şi unde are loc focul de artificii

Guvernul Dăncilă, huiduit la Alba Iulia – S-a scandat „Demisia!”
revistapresei.oradesibiu.ro - Sibiu
Premierul Viorica Dăncilă s-a aflat, joi, la Alba Iulia, pentru a vizita Monumentul Unirii şi pentru a se întâlni cu IPS Irineu, Arhiepiscop de Alba Iulia. În drumul lor spre statuia lui Mihai Viteazul, membrii Guvernului au fost huiduiţi de către trecători, care scandau „Demisia!”. Oficialii şi-au continuat însă drumul…

Primăria Craiova: Restricţii de circulaţie în centru, pe 30 noiembrie şi 1 decembrie
www.oltenasul.ro - Dolj
Related Posts via CategoriesPrimăria Craiova: Restricţii rutiere cu ocazia deschiderii Târgului de Crăciun Craiova 2018, în intervalul orar 17.30-24.00CONFERINȚA DE LANSARE A PROIECTULUI “Implementarea măsurilor de prevenire a corupţiei la nivelul Municipiului Calafat”Primăria Municipiului Craiova invită toţi craiovenii la manifestările prilejuite de Ziua României precum şi de Centenarul Marii Uniri ce vor avea loc Sâmbătă, 1 Decembrie 2018CJ Dolj: Vicepreşedintele […]

Mii de militari romani si straini participa la parada organizata de Ziua Nationala a Romaniei, la Arcul de Triumf din Bucuresti. Programul festivitatilor
www.ziuaconstanta.ro - Constanţa
Aproximativ 4.000 de militari si specialisti din Ministerul Apararii Nationale, Ministerul Afacerilor Interne, Serviciul Roman de Informatii, Serviciul de Protectie si Paza si Administratia ...

Elevi de la mai multe şcoli, scoşi afară în frig să „deseneze” harta României sau „100” (FOTO)
www.timponline.ro - Bistriţa-Năsăud
Mai multe şcoli din Bistriţa-Năsăud au întrerupt, joi, cursurile ca să organizeze diverse manifestări în cinstea Centenarului Marii Uniri întrucât vineri, 30 noiembrie, este zi liberă inclusiv pentru elevi. În ciuda vântului rece care a amplificat senzaţia de frig, elevii au fost scoşi în curţile un

Teodorovici, OMUL RUŞILOR? Acuzaţii grele la nivel înalt. Ce reacţie va avea Dragnea? News alert
evz.ro - Bucureşti
Propunerea ministrului de Finanţe, Eugen Teodorovici, privind limitarea dreptului de muncă al românilor din străinătate, a stârnit numeroase controverse....

Mii de militari romani si straini participa la impresionanta parada organizata cu ocazia Zilei Nationale a Romaniei, in Piata Arcul de Triumf din Bucuresti. Programul festivitatilor
www.ziuaconstanta.ro - Constanţa
Aproximativ 4.000 de militari si specialisti din Ministerul Apararii Nationale, Ministerul Afacerilor Interne, Serviciul Roman de Informatii, Serviciul de Protectie si Paza si Administratia ...

VIDEO: Convoiul de căruţe ”Drumul Unirii” a ajuns în AIUD. Maramureşenii şi aiudenii au cântat într-un glas DEȘTEAPTĂ-TE ROMÂNE!
ziarulunirea.ro - Alba
Un convoi format din zece căruţe trase de câte doi cai şi însoţitorii lor au plecat, joi, din municipiul Sighetu Marmaţiei spre Alba Iulia pe un traseu care măsoară peste 300 de kilometri, refăcând acelaşi drum al străbunilor maramureşeni care au participat la Marea Unire din 1918. Joi, 28 noiembrie, convoiul a ajuns în municipiul […]

Un text BIBLIC şochează! CONFIRMĂ teoria Big Bang: „Universul se extinde”
evz.ro - Bucureşti
Vechiul Testament confirmă legitimitatea teoriei Big Bang-ului, încheindu-se astfel dezbaterea dintre ştiinţă şi creaţionism asupra formării universului, co...

Anunţ de ultimă oră! Azi Guvernul decide! Mii de români vor lua mai mulţi bani de la 1 decembrie
evz.ro - Bucureşti
Cu ocazia Zilei Naţionale a României, premierul Viorica Dăncilă a ţinut un discurs tematic la Cetatea Alba Iulia şi a declarat ce se va discuta în şedinţa s...

AMENZI URIAȘE pentru şoferi. POLIŢIA VÂNEAZĂ „inteligenţii” de pe drumurile publice. Breaking news
evz.ro - Bucureşti
Poliţia anunţă noi amenzi pentru şoferii care nu respectă cea mai simplă lege. Amenzile ajung şi la câteva zeci de milioane....
 www.oltenasul.ro - Dolj
www.oltenasul.ro - Dolj
Related Posts via CategoriesExpoziţie de pictură – Case şi tradiţii româneştiProgramul Muzeului Olteniei, în perioada 30 noiembrie – 2 decembrie 2018!TRADEM: Evenimente culturale de 1 decembrieCu dor de BucovinaSculpturi în lemn şi piatră ocupă joi foaierul Teatrului ColibriCampanie de strângere de jucării „Să fim mai buni de sărbători”Stagiunea Colibri. ACTul 3: „CONSTELAȚII“, cu Ana Ularu şi Radu Iacoban, joi, pe […]

Expoziţie de pictură – Case şi tradiţii româneşti
www.oltenasul.ro - Dolj
Related Posts via CategoriesProgramul Muzeului Olteniei, în perioada 30 noiembrie – 2 decembrie 2018!TRADEM: Evenimente culturale de 1 decembrieCu dor de BucovinaSculpturi în lemn şi piatră ocupă joi foaierul Teatrului ColibriCampanie de strângere de jucării „Să fim mai buni de sărbători”Stagiunea Colibri. ACTul 3: „CONSTELAȚII“, cu Ana Ularu şi Radu Iacoban, joi, pe scenă la ColibriBiblioteca Judeţeană „Alexandru şi Aristia […]

La PITEŞTI, ca la SIBIU! Plasă cu iluminare LED, în PIAŢA PRIMĂRIEI
ziarulargesul.ro - Argeş
De 1 Decembrie, municipalitatea ne pregăteşte o seară de spectacol, piesa de rezistenţă fiind, în premieră, o plasă cu LED-uri care ar putea face senzaţie în Piaţa Primăriei. Dispunerea ornamentului este similară cu ce am văzut la Sibiu, la mijlocul acestei luni, iar faptul că aducem la Piteşti...

PMP solicită demisia lui Eugen Teodorovici! “PSD nu ştie cum să se mai răzbune pe românii din Diaspora”
www.gazetadambovitei.ro - Dâmboviţa
Comunicat de presă Declaraţie halucinantă a ministrului Teodorovici: Vrea limitarea la 5 ani a dreptului de muncă al românilor într-o

Atenţie şoferi: Restricţii de circulaţie pe 30 noiembrie şi 1 decembrie
ziarharghita.ro - Harghita
CNAIR SA reaminteşte participanţilor la trafic că potrivit prevederilor HG nr.1777/2004 privind introducerea restricţiei de circulaţie pe unele sectoare

Guvernul Dăncilă a aterizat la Sibiu – Un autocar i-a dus pe miniştrii la Alba Iulia
revistapresei.oradesibiu.ro - Sibiu
Toţi membrii Guvernului Dăncilă vor participa joi la o şedinţă solemnă în Sala unirii de la Alba Iulia. Cu toţii au aterizat joi dimineaţa pe Aeroportul Sibiu. I-a adus aici o cursă Tarom. Miniştrii Guvernului Dăncilă s-au îmbarcat apoi într-un autocar care i-a dus la Alba Iulia. Ședinţa solemnă de…

Interes mare pentru primul maraton cu Moşi Crăciun la Sibiu – Mulţi înscrişi
www.oradesibiu.ro - Sibiu
Prima cursă de Moşi Crăciuni care are loc în această iarnă la Sibiu, atrage ca un magnet doritori de participare. Cursa are loc în data de 13 decembrie. O sută de persoane s-au înscris la primul maraton cu Moşi Crăciun, care va avea loc în 13 decembrie, pe străzile municipiului…

Reguli noi pentru locurile de joacă din Sibiu – Primăria le-a făcut
revistapresei.oradesibiu.ro - Sibiu
După ce anul acesta doi copii s-au accidentat în locurile de joacă din Valea Aurie şi Ștrand, Primăria vrea să pună la punct felul în care aceste locuri sunt întreţinute şi folosite. Astfel a elaborat un set de reguli care urmează a fi aprobate de consilierii locali. Astfel, toate părţile…

Programul Muzeului Olteniei, în perioada 30 noiembrie – 2 decembrie 2018!
www.oltenasul.ro - Dolj
Related Posts via CategoriesTRADEM: Evenimente culturale de 1 decembrieCu dor de BucovinaSculpturi în lemn şi piatră ocupă joi foaierul Teatrului ColibriCampanie de strângere de jucării „Să fim mai buni de sărbători”Stagiunea Colibri. ACTul 3: „CONSTELAȚII“, cu Ana Ularu şi Radu Iacoban, joi, pe scenă la ColibriBiblioteca Judeţeană „Alexandru şi Aristia Aman”: Clubul Melomanilor – „MANON”„Cărticica pentru prichindei şi copii mai […]

Accident rutier grav pe DN2A la iesire din Slobozia. Doua masini implicate. Sunt mai multe victime
www.ziuaconstanta.ro - Constanţa
Un grav accident rutier a avut loc astazi la iesire din Slobozia spre Urziceni pe DN2A. Potrivit ISU Ialomita in accident au fost implicate doua autoturisme. La locul evenimentului rutier salvatorii ...

Veioză cu chipul Vioricăi Dăncilă, scoasă la vânzare pe OLX. Care e preţul
ph-online.ro - Prahova
O veioză de lux din inventarul Palatului Victoria a fost pusă la vânzare pe OLX, strângând în câteva ore de la publicare zeci de like-uri. Un buc...

Livia Stanciu PIERDE UN POST-CHEIE în sistem. Semnal primit de la Bruxelles pentru FOSTA ŞEFĂ A ÎCCJ? Breaking news în Justiţie
evz.ro - Bucureşti
Judecătorul Livia Stanciu nu mai este formator la Instititul Naţional al Magistraturii, locul de formare profesională a viitorilor magistraţi....

Un nou târg de joburi „O şansă pentru dezvoltare”
www.oltenasul.ro - Dolj
Related Posts via CategoriesASOCIATIA TINERILOR CU INITIATIVA DIN ZONA OLTENIEI – Stop excluziunii sociale a tinerilor defavorizaţi! – Proiect finanţat din fondurile bugetului judeţului Dolj, alocate pentru activităţi non-profitCampanie de strângere de jucării „Să fim mai buni de sărbători”1 şi 2 decembrie la Teatrul Colibri: Renii lui Moş Crăciun sau despre Ziua Naţională a României celebrată cu bucurii pentru copiiAsociaţia […]

De la capăt! Sindicatele din industria de apărare, întrevedere cu noul ministru al Economiei, Niculae Bădălău
www.gazetadambovitei.ro - Dâmboviţa
Liderul de sindicat de la Uzina Automecanica Moreni, Constantin Bucuroiu aşteaptă să aibă, cât de curând, o întrevedere cu noul

Primaria Ploiesti inchiriaza casute comerciantilor interesati, pe perioada Sarbatorilor de iarna
ph-online.ro - Prahova
20 de casute de lemn sunt scoase la inchirere, pe perioada sarbatorilor, in centrul Ploiestiului. Pretul pentru care acestea vor fi inchiriate es...

Ce măsuri s-a luat la nivelul judeţului pentru prevenirea pestei micilor rumegătoare
www.timponline.ro - Bistriţa-Năsăud
Având în vedere contextul epidemiologic actual, privind evoluţia pestei micilor rumegătoare (PMR) în Bulgaria, la nivelul judeţului Bistriţa-Năsăud s-au dispus următoarele măsuri, în conformitate cu cele luate la nivel naţional pentru prevenirea introducerii virusului pestei micilor rumegătoare din

TVR aniversează Ziua Naţională a României. Ce invitaţi vor veni pentru programele speciale
evz.ro - Bucureşti
De 1 Decembrie, TVR aniversează Ziua Naţională a României şi Centenarul Marii Uniri iar în zilele de sărbătoare. TVR 2 vine cu programe speciale şi invitaţi...

Sinucidere la penitenciar. Detinutul condamnat pentru viol, care nu s-a intors in termenul stabilit din invoire, s-a sinucis
www.ziuaconstanta.ro - Constanţa
Detinutul de la Penitenciarul Botosani, care a fost dat in urmarire dupa ce nu s-a intors la inchisoare dupa perioada de invoire, s-a spanzurat in camera de detinere, trupul sau fiind gasit de ...

MOL România oferă „Permis pentru viitor” tinerilor defavorizaţi Programul a ajuns la cea de-a patra ediţie
www.oltenasul.ro - Dolj
Related Posts via CategoriesTRADEM: Evenimente culturale de 1 decembrieMANIFEST! Unioniştii anunţă: FĂRĂ POLITICĂ ÎN ACEASTĂ ZI SFÂNTĂ!Casa de Cultură „Traian Demetrescu” lansează concursul de desen digital „Sărbători de iarnă cu braţele deschise”, ediţia a XI-a.Cu dor de BucovinaASOCIATIA TINERILOR CU INITIATIVA DIN ZONA OLTENIEI – Stop excluziunii sociale a tinerilor defavorizaţi! – Proiect finanţat din fondurile bugetului judeţului Dolj, alocate […]

Accident rutier la intrare in Slobozia dinspre Urziceni
obiectiv.net - Ialomiţa
Accident rutier, Slobozia, azi, in jurul orei 11:45. Știre în curs de actualizare... Vezi tot

Celebrarea Centenarului Marii Uniri la Liceul Teoretic Mihail Kogalniceanu (video)
www.ziuaconstanta.ro - Constanţa
Idealul de veacuri al neamului romanesc unirea tuturor romanilor intr-un singur stat si-a gasit implinirea in urma cu 100 de ani, la 1 Decembrie 1918. Actul istoric nu s-ar fi putut realiza fara ...

De Ziua Naţională, avansări în grad la Jandarmeria Argeş
ziarulargesul.ro - Argeş
La sediul Inspectoratului de Jandarmi Judeţean Argeş s-a desfăşurat, astăzi, ceremonialul militar organizat cu prilejul Zilei Naţionale a României, în cadrul căruia au fost avansaţi în gradul următor înaintea expirării stagiului minim în grad, pentru profesionalismul de care au dat dovadă pe...

PERICOL MAJOR pentru tinerii cu vârste cuprinse între 15 ŞI 29 DE ANI
evz.ro - Bucureşti
Aproape două miliarde de tineri din întreaga lume riscă să devină inadaptaţi la piaţa muncii în cea de-a patra revoluţie industrială (Industria 4.0), care s...

Tur încheiat cu un aparent derby, de clasament
www.zi-de-zi.ro - Mureş
Ultima etapă din cadrul turului Diviziei A la volei feminin programează sâmbătă, 1 decembrie, în ser

Cocoşul de Aur îşi va recăpăta înfăţişarea de odinioară
www.zi-de-zi.ro - Mureş
Reprezentanţii companiei ROMUR au anunţat miercuri seara, pe pagina de Facebook a firmei, obţinerea

MARATON CENTENAR – 100 DE ANI, 100 DE KM
ziarharghita.ro - Harghita
Sâmbătă, 24 noiembrie 2018, plutonierii Marius Afilipoaie, Mihail Dupu şi fruntaş Szabo Zolan aparţinând Brigăzii 61 Vânători de Munte „General Virgil

Vineri, de Sf. Andrei, se trage cortina turului sub Drăgana | Metalurgistul Cugir – Gloria Lunca Teuz Cermei, sau victoria – obligatorie!
ziarulunirea.ro - Alba
Metalurgistul Cugir încheie turul eşalonului terţ, de Sf. Andrei, cu o dispută pe “Arena CSO”, în faţa fanilor, vineri, 30 noiembrie, de la ora 14.00, cu Gloria Lunca Teuz Cermei. O confruntare între vecine de clasament, aflate la egalitate de puncte, 28, cu amftrionii situaţi pe ultima treaptă a podiumului, iar oaspeţii cu un loc […]

TRADEM: Evenimente culturale de 1 decembrie
www.oltenasul.ro - Dolj
Related Posts via CategoriesSculpturi în lemn şi piatră ocupă joi foaierul Teatrului ColibriCampanie de strângere de jucării „Să fim mai buni de sărbători”Stagiunea Colibri. ACTul 3: „CONSTELAȚII“, cu Ana Ularu şi Radu Iacoban, joi, pe scenă la ColibriBiblioteca Judeţeană „Alexandru şi Aristia Aman”: Clubul Melomanilor – „MANON”„Cărticica pentru prichindei şi copii mai măricei” Cocarde în culorile drapelului naţional–1 şi 2 […]

Ce adversari ar vrea să evite Cosmin Contra în grupa României din preliminariile pentru Campionatul European 2020
evz.ro - Bucureşti
Naţionala României îşi va afla duminică, 2 decembrie, viitoarele adversare din grupele preliminariilor Campioantului European din 2020....

Oltchim, legendara echipă care a falimentat din cauza unui combinat
evz.ro - Bucureşti
Timp de 40 de ani, la Râmnicu Vâlcea a existat cea mai importantă formaţie din handbalul feminin. La puţin timp după ce-a ajuns în finala Ligii Campionilor,...

Maramures: O alta zi, un alt tanar depus dupa gratii dupa ce a comis infractiuni rutiere
ziarmm.ro - Maramureş
O alta persoana condamnata dupa ce a comis infractiuni la regimul circulatiei pe drumurile publice a fost incarcerata miercuri, 29 noiembrie, de politisti si depusa in Penitenciarul Baia Mare. Este vo

Programul OTL pentru perioada 30 noiembrie - 2 decembrie 2018
www.ebihoreanul.ro - Bihor
OTL SA anunţă publicul călător că, în 30 Noiembrie, 1 şi 2 Decembrie 2018, mijloacele de transport în comun vor circula conform graficelor valabile pentru zilele de duminică şi sărbători legale.

OPINIE: Daniel Tache – Eu cred că noi nu ne mai vindecăm de comunism
www.gazetadambovitei.ro - Dâmboviţa
Eu cred că noi nu ne mai vindecăm de comunism. Iar prin comunism înţeleg struţo-cămila leninist-legionară pe care am cunoscut-o

Evoluţie dezamăgitoare, rezultat pe măsură
www.zi-de-zi.ro - Mureş
Echipa feminină de baschet CSM Târgu-Mureş a suferit miercuri seara prima înfrângere pe teren propri

Interes mare pentru primul maraton cu Moşi Crăciun la Sibiu – Mulţi înscrişi
ultimaora.oradesibiu.ro - Sibiu
Prima cursă de Moşi Crăciuni care are loc în această iarnă la Sibiu, atrage ca un magnet doritori de participare. Cursa are loc în data de 13 decembrie. O sută de persoane s-au înscris la primul maraton cu Moşi Crăciun, care va avea loc în 13 decembrie, pe străzile municipiului…

Un somn imens de 2 metri a fost prins în lacul Tâncăbeşti, din Ilfov. Cât cântăreşte
ph-online.ro - Prahova
O captură demnă de orice campionat de pescuit a fost făcută în lacul Tâncăbeşti, din judeţul Ilfov. Este vorba despre un somn, care cântăreşte 93 de k...

MANIFEST! Unioniştii anunţă: FĂRĂ POLITICĂ ÎN ACEASTĂ ZI SFÂNTĂ!
www.oltenasul.ro - Dolj
Related Posts via CategoriesCasa de Cultură „Traian Demetrescu” lansează concursul de desen digital „Sărbători de iarnă cu braţele deschise”, ediţia a XI-a.ASOCIATIA TINERILOR CU INITIATIVA DIN ZONA OLTENIEI – Stop excluziunii sociale a tinerilor defavorizaţi! – Proiect finanţat din fondurile bugetului judeţului Dolj, alocate pentru activităţi non-profitSculpturi în lemn şi piatră ocupă joi foaierul Teatrului ColibriCampanie de strângere de jucării […]

Afaceri ilegale cu tutun combatute de politisti: Perchezitii domiciliare la Borsa si Moisei
ziarmm.ro - Maramureş
Politistii specializati in investigarea criminalitatii economice din cadrul Inspectoratului de Politie al Judetului Maramures, cu sprijinul luptatorilor din cadrul Serviciului de Actiuni Speciale Mara

Romanul care conduce Bugatti Chiron: primul test cu masina de 3,5 milioane de Euro
ph-online.ro - Prahova
Soferul a condus un Bugatti Chiron, cea mai scumpa masina de serie a momentului. Automobilul de 1500 cp a fost special comandat de un client din Bulga...

Guvernul va adopta instituirea unui mecanism de economisire pentru copii, contul de economii "Junior Centenar". Ce presupune acesta
www.ziuaconstanta.ro - Constanţa
Guvernul va adopta instituirea unui mecanism de economisire pentru copii, contul de economii Junior Centenar , care sa faciliteze accesul la educatie si sa acopere lipsa de venituri, a anuntat ...

Singurul constantean judecat pentru bigamie a fost condamnat
www.ziuaconstanta.ro - Constanţa
Conform actului de sesizare a instantei, cel in cauza este suspectat ca, de-a lungul anilor, s-a casatorit cu trei femei, fara a divorta legal de primele doua.

Deputat Cătălina Bozianu:”Centenarul Marii Uniri – o sărbătoare a dezbinării provocate de politică, dar şi o şansă pentru un nou început”
ph-online.ro - Prahova
Deputat Cătălina Bozianu:”Centenarul Marii Uniri – o sărbătoare a dezbinării provocate de politică, dar şi o şansă pentru un nou început” Declaraţia p...

Casa de Cultură „Traian Demetrescu” lansează concursul de desen digital „Sărbători de iarnă cu braţele deschise”, ediţia a XI-a.
www.oltenasul.ro - Dolj
Related Posts via CategoriesASOCIATIA TINERILOR CU INITIATIVA DIN ZONA OLTENIEI – Stop excluziunii sociale a tinerilor defavorizaţi! – Proiect finanţat din fondurile bugetului judeţului Dolj, alocate pentru activităţi non-profitSculpturi în lemn şi piatră ocupă joi foaierul Teatrului ColibriCampanie de strângere de jucării „Să fim mai buni de sărbători”CEZ Vanzare lanseaza CEZ Shop si intra pe piata comertului online, cu o […]

Cum vad copiii din Harghita istoria scrisă de strămoşi şi cum şi-ar dori ei să fie ţara noastră România
ziarharghita.ro - Harghita
Peste 170 de elevi din clasele primare ale Colegiului Naţional „Octavian Goga” din municipiul Miercurea Ciuc au participat la concursul de desen „La mulţi

Lukoil îl aduce la conducerea Petrotel Ploieşti pe şeful uneia dintre cele mai mari rafinării din Rusia
ph-online.ro - Prahova
Petrotel Lukoil, rafinăria ploieşteană controlată de grupul petrolier rus omonim, va avea din 1 decembrie un nou director general executiv şi preşedin...

Muzeul Judeţean de Știinţele Naturii Prahova organizeaza vernisajul expozitiei “100 de clipe dintr-o zi mare”
ph-online.ro - Prahova
Muzeul Judeţean de Știinţele Naturii Prahova vă invită joi, 29 noiembrie, orele 11.00, la vernisajul expoziţiei “100 DE CLIPE DINTR-O ZI MARE”, care v...

Armaşu a turnat trei straturi de asfalt ca-n palmă pe drumul spre Șură! „Am pierdut bani, dar Nelu a spus: «Hai, frate, să-l facem!»”
expressdebanat.ro - Caraş-Severin
Drumul spre Lacul Secu arată mai bine ca niciodată după ce constructorul, omul de afaceri Valentin Armaşu, a fost convins de primarul Nelu Popa că are doar intenţii bune pentru Reşiţa! Firma lui Armaşu a câştigat contractul pentru reabilitarea şi modernizarea drumului spre Secu pe vremea primarului Stepanescu şi tot atunci s-a apucat de treabă.…

Ai TELEFON de acest tip? Amenda este USTURĂTOARE!
evz.ro - Bucureşti
Amendă pentru cei care deţin telefoane wireless ilegale este de până la 5.000 de lei...

Șeful NASA a primit un telefon MISTERIOS la câteva secunde după aterizarea sondei InSight pe Marte
evz.ro - Bucureşti
NASA a dat detalii despre un apel telefonic ciudat primit la câteva secunde după plasarea sondei InSight pe Marte, informează Daily Star....

Mircea Baniciu îl vrea pe Emil Boc primar în Bucureşti. Ce a spus Dan Bittman - VIDEO
www.stiridecluj.ro - Cluj
Mircea Baniciu îl vrea pe Emil Boc primar în Bucureşti. Ce a spus Dan Bittman - VIDEO

FOTO: Premierul Dancilă şi membrii Guvernului au fost decoraţi de ÎPS Irineu, cu ordin bisericesc, la Alba Iulia
ziarulunirea.ro - Alba
Aflaţi la Alba Iulia pentru a participa la şedinţa solemnă a Guvernului României, dedicată Centenarului, premierul Viorica Dăncilă şi miniştrii Cabinetului său au au fost decoraţi de ÎPS Irineu, cu ordine bisericeşti. Vizita la Catedrala Încoronării şi întâlnirea cu Arhiepiscopul Albei Iulia a făcut parte din programul oficial al premierului. Înainte de acest moment oficialii […]

Persoanele fizice pot cumpăra titluri de stat CENTENAR cu dobândă de 4,5% şi scadenţă la 2 ani
ziarulteleormanul.ro - Teleorman
Ministerul Finanţelor Publice lansează o emisiune aniversară de titluri de stat către populaţie, cu ocazia sărbătoririi Centenarului Marii Uniri, a treia în cadrul programului TEZAUR-ediţia CENTENAR. Valoarea nominală a unui titlu de stat este de 1 leu, cu maturitate de 2 ani şi o rată de dobândă foarte avantajoasă de 4,5%, iar veniturile aferente sunt neimpozabile. După încheierea perioadei de subscriere, MFP va organiza o tombolă prin care 1000 de investitori în această emisiune de titluri de stat vor fi selectaţi pentru a primi un bonus de dobândă în valoare de 5.000 lei, care va fi acordat

Cu unirea pe buze şi ura în suflet! Ce şi-au transmis foştii preşedinţi de CJD într-o şedinţă festivă
www.gazetadambovitei.ro - Dâmboviţa
Foştii preşedinţi şi foştii prefecţi de Dâmboviţa au primit, ieri, în cadrul unei ceremonii organizate de Consiliul Judeţean, plachete aniversare

Indemnizatiile acordate invalizilor, veteranilor si vaduvelor de razboi majorate de cinci ori. Cand intra in vigoare noile mariri adoptate de Guvern
www.ziuaconstanta.ro - Constanţa
Guvernul va aproba majorarea, in medie, de cinci ori a indemnizatiilor acordate invalizilor, veteranilor si vaduvelor de razboi, noile mariri urmand sa intre in vigoare de la 1 ianuarie 2019, a anuntat, ...

În atenţia şoferilor: Restricţii de circulaţie pe 30 noiembrie şi 1 decembrie
ziarharghita.ro - Harghita
Consiliul Judeţean Harghita a formulat propuneri de modificare a ordonanţei de urgenţă în ceea ce priveşte programul pilot de acordare a unui suport

Maşină furată din Olanda descoperită de poliţiştii de frontieră timişeni în Vama Moraviţa
www.tion.ro - Timiş
Dosar penal pentru tăinuire pe numele unui cetăţean român, în Vama Moraviţa. El este cercetat penal după ce a fost prins la volanul unui autoturism furat.

Avansari in grad pentru merite exceptionale la IPJ Constanta. Mai multi ofiteri si agenti, inaintati in grad de Ziua Nationala a Romaniei (galerie foto)
www.ziuaconstanta.ro - Constanţa
Cu prilejul Zilei Nationale a Romaniei 1 Decembrie, pentru merite exceptionale in activitatea profesionala, un numar de 16 ofiteri si 14 agenti de politie din cadrul Inspectoratului de Politie ...

In Anul Centenarului – O noua carte-album a profesorului Adrian Ilie: Medgidia, 100 de ani de istorie
www.ziuaconstanta.ro - Constanţa
Aratam, in urma cu un an, la Prefata intitulata Slujitor medgidian al lui Clio la 45 de ani, la volumul Primarii Medgidiei crestini si musulmani Cuvant inainte Valentin Vrabie Primar al Municipiului ...

Anunţ începere proiect „Achiziţie de utilaje şi echipamente în cadrul CROMATIC TIPO”
www.zi-de-zi.ro - Mureş

Baia Mare: Angajatii de la Serviciul Permise au muncit astazi cu tricolorul prins in piept
ziarmm.ro - Maramureş
Maramuresenii care au trecut astazi pe la Serviciul Public Comunitar Regim Permise de Conducere si Inmatriculare a Vehiculelor din cadrul Institutiei Prefectului Maramures au fost intampinati de catre

ATAC „SUBTIL” la PSD. DĂNCILĂ a fost ţinta PRINCIPALĂ a oamenilor FURIOȘI din stradă
evz.ro - Bucureşti
Membri PSD au fost huiduiţi la Alba Iulia, în frunte cu premierul Viorica Dăncilă care va conduce şedinţa de Guvern care va avea loc simbolic în oraşul Unir...

Lumea bună a Parisului solidarizează cu „vestele galbene”
evz.ro - Bucureşti
Celebra actriţă Brigitte Bardot, cântăreţul Michel Polmareff şi rapperul Kaaris, dar şi multe alte celebrităţi, şi-au exprimat susţinerea în aceste zile cu ...

Fosta preşedintă a Înaltei Curţi de Casaţie şi Justiţie nu mai este profesor la INM. Livia Stanciu nu le mai poate preda viitorilor magistraţi
evz.ro - Bucureşti
Judecătorul Livia Stanciu nu mai este formator la Instititul Naţional al Magistraturii, locul de formare profesională a viitorilor magistraţi....

7.077 persoane şi-au găsit un loc de muncă cu sprijinul AJOFM Teleorman
ziarulteleormanul.ro - Teleorman
În primele 10 luni ale anului 2018, ca urmare a implementării Programului Naţional de Ocupare a Forţei de Muncă, prin intermediul AJOFM Teleorman au fost încadrate în muncă 7.077 persoane, dintre care 2.971 femei. Din totalul persoanelor ocupate până la data de referinţă, 3.011 au peste 45 de ani, 1.793 au vârsta cuprinsă între 35 şi 45 de ani, 1.337 au între 25 şi 35 de ani, iar 936 sunt tineri sub 25 de ani . În funcţie de rezidenţă, din totalul persoanelor încadrate în muncă, 2.832 provin din mediul urban, iar 3.245 persoane sunt din mediul rural. Din punct …

Avansari in grad pentru merite exceptionale la IPJ Constanta. Mai multi ofiteri si agenti, inaintati in grad de Ziua Nationala a Romaniei
www.ziuaconstanta.ro - Constanţa
Cu prilejul Zilei Nationale a Romaniei 1 Decembrie, pentru merite exceptionale in activitatea profesionala, un numar de 16 ofiteri si 14 agenti de politie din cadrul Inspectoratului de Politie ...

Ce program de functionare vor avea chioscurile RATC Constanta in minivacanta de Sf Andrei si 1 Decembrie
www.ziuaconstanta.ro - Constanţa
Regia Autonoma de Transport in Comun Constanta anunta publicul calator programul de functionare al chioscurilor R.A.T.C., pentru procurarea tichetelor de calatorie si abonamentelor, in perioada ...

Dragnea, Tel Drum, Petre Pitiş şi conexiunile cu Brazilia. Rise Project a lovit din nou! Breaking news
evz.ro - Bucureşti
Rise Project susţine că Pitiş a cumpărat o vilă de lux situată pe malul oceanului, cu bani aduşi în Brazilia de Mugurel Gheorghiaş, un alt asociat al Tel Dr...

Victorie marca Mansour. Ripensia Timişoara bate în prelungiri Farul Constanţa
www.tion.ro - Timiş
Miercuri, în intermediară, a fost ziua echipelor timişorene: una dintre echipe a făcut egal, în timp ce celelalte două au câştigat, ambele în prelungiri. Ripensia a câştigat acasă, cu Farul, autorul unicului gol fiind Mansour.

Centenarul Marii Uniri, sărbătorit la Panciu
www.jurnaldevrancea.ro - Vrancea
Primarul Iulian Nica invită păncenii la manifestările dedicate aniversării Centenarului Marii Uniri şi Zilei Naţionale a României, care vor fi organizate | Jurnal de Vrancea

4 soluţii pentru amenajarea casei sau a sediului afacerii tale (FOTO)
www.ebihoreanul.ro - Bihor
Unul dintre cele mai importante aspecte este cel vizual. Iar asta se aplică mai ales în domeniul construcţiilor sau al amenajărilor exterioare şi interioare. Pentru ca un spaţiu să fie confortabil şi apreciat, trebuie în primul rând să fie plăcut privirii. În al doilea rând, spaţiul în care locuim, cel în care ne desfăşurăm activitatea profesională sau în care ne primim clienţii trebuie să fie funcţional şi util...

VIDEO: Ședinţa solemnă a Guvernului la Sala Unirii din Alba Iulia. Albaiulienii i-au primit pe miniştri cu pâine şi sare, dar şi cu protest şi huiduieli
ziarulunirea.ro - Alba
La Sala Unirii din Alba Iulia a avut loc, joi, o şedinţă solemnă de Guvern, dedicată celebrării Zilei Naţionale a României. Întâlnirea a debutat cu intonarea Imnului României, un discurs al premierului Viorica Dăncilă şi vizionarea filmului de prezentare a României aflată la momentul Centenarului. Pe Ordinea de zi a şedinţei s-au aflat: I. PROIECTE […]

Dragnea, Tel Drum, Petre Pitiş şi conexiunile cu Brazilia. Rise Project a lovit din nou! Breaking news GALERIE FOTO
evz.ro - Bucureşti
Rise Project susţine că Pitiş a cumpărat o vilă de lux situată pe malul oceanului, cu bani aduşi în Brazilia de Mugurel Gheorghiaş, un alt asociat al Tel Dr...

Putin ARE DOCUMENTELE SECRETE ale Ucrainei. Breaking news
evz.ro - Bucureşti
Serviciul Federal de Securitate din Federaţia Rusă a publicat documentele capturate de la marinarii ucraineni reţinuţi după incidentul din strâmtoarea Kerci...

Anunţ de ultimă oră din Costa Rica! Veşti groaznice pentru Elena Udrea. Este oficial
evz.ro - Bucureşti
Fostul ministru Elena Udrea, aflată în Costa Rica, în custodia autorităţilor locale, a mai primit o veste proastă. Alături de ea se află şi Alina Bica, fost...

Scena politică, ARUNCATĂ în AER de Mircea Badea. DEZVĂLUIRI INCENDIARE despre DĂNCILĂ
evz.ro - Bucureşti
Mircea Badea, moderatorul emisiunii „În Gura Presei”, a dezvăluit de ce nu o mai poate asculta pe Viorica Dăncilă, premierul actual al României....

În atenţia şoferilor: Restricţii de circulaţie pe 30 noiembrie şi 1 decembrie
ziarharghita.ro - Harghita
CNAIR SA reaminteşte participanţilor la trafic că potrivit prevederilor HG nr.1777/2004 privind introducerea restricţiei de circulaţie pe unele sectoare

Rudele celor DEPORTAŢI în lagărelele NAZISTE vor fi DESPĂGUBITE de Căile Ferate
evz.ro - Bucureşti
Pentru prima oară rudele eveilor transportaţi în lagărele de exterminare vor primi despăgubiri. După un an de bătălii dure, în sfârşit, Salo Muller a câştig...

FOTO / VIDEO: MOȚII trec munţii, pe jos, spre Alba Iulia, ca pe vremea lui Iancu şi Horea. Ei vor reface traseul delegaţiei din Lupşa, de acum 100 de ani
ziarulunirea.ro - Alba
Moţii trec munţii, pe jos, pentru a ajunge la Alba Iulia, ca pe vremea lui Iancu şi Horea. Ei vor reface traseul delegaţiei din Lupşa, de acum 100 de ani. În urmă cu 100 de ani, românii de pretutindeni se îndreptau spre Cetatea Neamului Românesc, sub faldurile tricolorului, de a se uni cu “fraţii” de […]

Dragnea amână pentru o lună şedinţele completurilor de 5 judecători
evz.ro - Bucureşti
Cauzele stabilite la Înalta Curte de Casaţie şi Justiţie pentru datele de 3 şi 10 decembrie, judecate de completurile de 5 judecători, vor avea noi termene,...

Flavius Buzilă, solistul trupei Hara, despre proiectul ”100 pentru România”: Să moară capra vecinului trebuie să dispară - VIDEO
www.stiridecluj.ro - Cluj
Flavius Buzilă, solistul trupei Hara, despre proiectul ”100 pentru România”: Să moară capra vecinului trebuie să dispară - VIDEO
![Piatra-Neamţ: „Il viaggio”, un nou restaurant în Piatra-Neamţ (by Chef Giovanni) [FOTO-VIDEO]](/showimg/300-200--zi/images/fullinfo.ro-images/news-273873.jpg)
Piatra-Neamţ: „Il viaggio”, un nou restaurant în Piatra-Neamţ (by Chef Giovanni) [FOTO-VIDEO]
www.stiri-neamt.ro - Neamţ
Giovanni, cunoscutul bucătar care a participat la show-ul „Chefi la cuţite” şi-a deschis un restaurant în Piatra-Neamţ. Cei interesaţi de o călătorie

Membrii Guvernului Dancila, huiduiti la Alba Iulia in timp ce depuneau coroane de flori
www.ziuaconstanta.ro - Constanţa
Membrii Cabinetului Dancila au depus, joi, o coroana de flori la statuia ecvestra a lui Mihai Viteazul din Alba Iulia. In timpul evenimentului membrii Guvernului au fost huiduiti de cateva persoane. ...

Romsilva a demarat cea de-a doua campanie de împăduriri din acest an
ziarharghita.ro - Harghita
Regia Naţională a Pădurilor – Romsilva a demarat cea de-a doua campanie de împăduriri din acest an, cu lucrări programate pentru împădurirea a peste 1.100

REGIO: Finalizarea proiectului „Investiţie performantă în domeniul productiv pentru dezvoltarea durabilă a firmei DIP INTERNAȚIONAL SRL”
www.gazetadambovitei.ro - Dâmboviţa

Spectacolul „Tatăl meu, preotul“ participă la Festivalul Teatrelor Naţionale Cluj Napoca 2018
www.zi-de-zi.ro - Mureş
Spectacolul Companiei Liviu Rebreanu, „Tatăl meu, preotul“ de Gabriel Sandu, în regia Letei Popescu,

Muncitor prins sub un mal de pământ pe strada Lyon
www.oradesibiu.ro - Sibiu
Un bărbat a fost prins joi dimineaţa sun un mal de pământ. Accidentul s-a petrecut pe strada Lyon. Pentru salvarea bărbatului la faţa locului au ajuns trei echipaje de pompieri şi descarcerare şi o ambulanţă SMURD. În cele din urmă bărbatul a fost scos, este conştient şi primeşte îngrijiri medicale…

FOTO Dezastru pe o stradă la doi kilometri de centrul Sibiului – Municipalitatea spune că ”se rezolvă”
www.oradesibiu.ro - Sibiu
Tot mai mulţi sibieni se plâng de faptul că străzile pe care locuiesc sunt pline de noroi, iar şantierele începute au fost lăsate de izbelişte o dată ce a început vremea rea. Un astfel de exemplu este strada Dorobanţilor. Locuitorii de aici sunt nemulţumiţi că după schimbarea reţelei de canalizare…

Concerte cochete la Christmas Food Carusel în Piaţa Huet
www.oradesibiu.ro - Sibiu
14 truck-uri cu cel mai gustos street-food din România au poposit miercuri în Piaţa Huet, iar până duminică, sibienii şi turiştii se vor putea bucura de delicatese gătite pe patru roţi, de la preparate mexicane la mâncăruri asiatice sau de la burgeri zemoşi la eclere fine, în Piaţa Huet le…

Colectare cadouri pentru copii nevoiaşi la Târgul de Crăciun din Sibiu
www.oradesibiu.ro - Sibiu
Târgul de Crăciun din Sibiu împreună cu Asociaţia WeHelp sunt din nou parteneri ai programului „ShoeBox”, prin care oricine poate dărui un cadou de Crăciun copiilor cu o situaţie materială dificilă. Cadoul din cutia de pantofi “ShoeBox” este o iniţiativă de ajutorare a copiilor din familii cu posibilităţi materiale reduse,…

Programul spitalului din Sibiu în minivacanţa de 1 decembrie
www.oradesibiu.ro - Sibiu
Policlinica Spitalului Judeţean Sibiu va avea un program special în minivacanţa care urmează. Astfel, în data de 30 noiembrie 2018 (Sfântul Andrei –sărbătoare legală), în cadrul Spitalului Clinic Judeţean de Urgenţă Sibiu se va lucra după următorul program: ■ În cadrul Ambulatoriului de Specialitate (Policlinica): - vineri 30 noiembrie 2018 -…

Semaforizare pe baza de buton, la mai multe treceri pentru pietoni din Ploiesti
ph-online.ro - Prahova
La aceasta ora, echipele directiei Tehnic-Investitii din Primaria Ploiesti lucreaza la implementarea sistemelor de semaforizare pe baza de buton, la m...

Spitalele clujene asigură serviciile medicale în perioada minivacanţei
feedproxy.google.com - Cluj
Spitalele clujene vor asigura permanenţa pentru serviciile medicale pe întreaga durată a sărbătorilor ce se apropie, Sfântul Andrei.

Din 3 decembrie, OTL îşi extinde reţeaua de transport public urban prin curse regulate: încă două linii noi de autobuz
www.ebihoreanul.ro - Bihor
Avându-se în vedere creşterea numericǎ a agenţilor economici din Parcul industrial 1 Oradea, solicitǎrile Agenţiei de Dezvoltare Localǎ Oradea şi a companiilor rezidente, pentru o mai bunǎ deservire a angajaţilor din cartierele situate în zonele periferice ale Oradiei, cu aprobarea Primǎriei Municipiului Oradea şi a Asociaţiei de Dezvoltare Intercomunitarǎ Oradea, începând cu data de 3 decembrie 2018 se înfiinţeazǎ liniile 31 şi 32 autobuz.

Continua actiunile de deszapezire in municipiul Constanta! Cum se circula pe bulevardele si strazile din oras (galerie foto)
www.ziuaconstanta.ro - Constanţa
Continua actiunile de deszapezire in municipiul Constanta! In acest moment, se circula in conditii normale pe bulevardele principale, iar pe strazile secundare, in conditii de iarna. Potrivit ...

De ce Luminiţa Jivan?! Pentru că e tânără!
expressdebanat.ro - Caraş-Severin
Împărţirea PSD Caraş-Severin, fie în tabăra lui Ion Mocioalcă, fie în cea a Luminiţei Jivan, nu mai este un subiect tabu. Unul din social-democraţii care nu se ascund după degete este Nicolae Tismănariu, primarul comunei Gârnic!

A fost descoperit un nou efect al aspirinei. Ce arată un studiu
ph-online.ro - Prahova
Aspirina, folosită în doze reduse, ar putea diminua gravitatea simptomelor şi anomaliilor sistemului imunitar la pacienţii cu scleroză multiplă, după...

TÂRGOVIȘTE: Marşul Tricolorului – un drapel lung de 100 de metri a fost purtat de elevi
www.gazetadambovitei.ro - Dâmboviţa
La initiativa Scolii Gimnaziale ”Vasile Cârlova” din Targoviste, cu sprijinul Primăriei Municipiului Târgovişte, Complexului Muzeal Curtea Domnească şi al Inspectoratului

Accident pe DN1, la intrare in Sinaia. O masina s-a izbit de un cap de pod
ph-online.ro - Prahova
Accident la intrare în Sinaia, joi dimineaţă. IJP Prahova anunţă că o maşină a intrat într-un cap de pod, trei persoane fiind rănite în urma impactulu...

Captura impresionanta la frontiera. Ce au gasit politistii de frontiera in trei microbuze in Punctul de Trecere a Frontierei Ostrov (galerie foto)
www.ziuaconstanta.ro - Constanţa
Politistii de frontiera din cadrul Garzii de Coasta impreuna cu lucratorii vamali de la Biroul Vamal Constanta Sud au descoperit in trei microbuze si semiremorcile acestora, articole vestimentare in ...

Accident la Paulesti. 4 masini implicate
ph-online.ro - Prahova
Un accident în lanţ s-a produs, în jurul orei 10.45, pe DJ 102, în localitatea prahoveană Păuleşti. Potrivit IJP Prahova, evenimentul a avut loc în zo...

Locuri de munca vacante in Braila
www.infobraila.ro - Brăila
Comentarii comentariu

De unde puteţi cumpăra lemn de foc pentru încălzirea locuinţelor şi care sunt preţurile
www.timponline.ro - Bistriţa-Năsăud
Două ocoale silvice din subordinea Direcţiei Silvice Bistriţa-Năsăud au lemn de foc necesar încălzirii locuinţelor, şi anume OS Bistriţa cu 600 mc şi OS Beclean cu 2.500 mc.
Preţurile de valorificare variază între 95 lei/mc şi 262 lei/mc (cu TVA inclus), în funcţie de specie, sortiment şi conditi

Reţeaua de sănătate Regina Maria a deschis o policlinică în Centrul Civic
feedproxy.google.com - Braşov
La 8 ani de la deschiderea primului centru medical din Braşov, Reţeaua de sănătate Regina Maria îşi consolidează prezenţa în oraş prin inaugurarea Policlinicii Centrul Civic. Cu o investiţie de peste 600.000 de euro, noua unitate este localizată în proximitatea Campusului Medical Braşov şi duce mai departe angajamentul de a susţine calitatea actului medical la

RĂSTURNARE de SITUAȚIE: Ce se întâmplă cu economia! Au anunţat ACUM
evz.ro - Bucureşti
Rata şomajului a ajuns, în România, la 4% în octombrie, în creştere cu 0,1% faţă de luna anterioară, arată datele Institutului Naţional de Statistică (INS),...

Programul spitalului din Sibiu în minivacanţa de 1 decembrie
ultimaora.oradesibiu.ro - Sibiu
Policlinica Spitalului Judeţean Sibiu va avea un program special în minivacanţa care urmează. Astfel, în data de 30 noiembrie 2018 (Sfântul Andrei –sărbătoare legală), în cadrul Spitalului Clinic Judeţean de Urgenţă Sibiu se va lucra după următorul program: ■ În cadrul Ambulatoriului de Specialitate (Policlinica): - vineri 30 noiembrie 2018 -…

Fumat fără fum. S-a lansat cea mai recentă generaţie IQOS, liderul produselor cu tutun încălzit (P)
evz.ro - Bucureşti
După lansarea globală din Tokyo, cele mai noi dispozitive IQOS 3 şi IQOS 3 MULTI au ajuns şi în România. Este ştiut, aceste dispozitive asigură un fumat făr...

Sute de călători au rămas blocaţi pe calea ferată. Trenuri blocate în ger şi zăpadă
evz.ro - Bucureşti
Sute de călători au rămas blocaţi pe calea ferată. Sunt trenuri blocate în ger şi zăpadă, conform centrului INFOTRAFIC al Inspectoratului General al Poliţi...

La peste un an de la mezo-ciclonul care a "măturat" Bihorul, jumătate din copacii doborâţi de vânt sunt încă în păduri
www.ebihoreanul.ro - Bihor
Birocraţie prea 'riguroasă' sau autorităţi prea încete? Jumătate din copacii doborâţi, în septembrie 2017, de mezo-ciclonul care a lovit Bihorul sunt încă în păduri. Şeful Direcţiei Silvice Bihor, Adrian Jurcău, spune însă că nu a fost afectată calitatea lemnelor. În plus, acestea vor fi evacuate în următoarele două luni.

FOTO. Bloc ghetou de pe Ostrovului, modernizat şi predat sătmărenilor
portalsm.ro - Satu Mare
Bloc ghetou de pe Ostrovului, modernizat şi predat sătmărenilor

La Constanta, incepe unul dintre turneele zonale ale Memorialului Gheorghe Ene“
www.ziuaconstanta.ro - Constanţa
Confruntarile turneului zonal 2 al Memorialului Gheorghe Ene rezervat fotbalistilor nascuti dupa 1 ianuarie 2010 vor avea loc, la Sala Sporturilor din Constanta, vineri, 30 noiembrie, si sambata, 1 ...

VIDEO: Guvernul României şi Viorica Dăncilă huiduiţi, la Alba Iulia, de un grup de protestatari: ”Ruşine să vă fie!”
ziarulunirea.ro - Alba
Prezenţi la Alba Iulia pentru o şedinţă solemnă dedicată Centenarului, miniştrii Cabinetului Dăncilă au fost aşteptaţi cu huiduieli la statuia voievodului Mihai Viteazul, unde trebuiau să depună o coroană. Cei aproximativ 10 protestatari au scandat ”Ruşine să vă fie”, ”Demisia”. De altfel, şi pe drumul de la Catedrală şi până în Piaţa Cetăţii au fost […]

Incendiu violent in municipiul Tulcea. O locuinta, cuprinsa de flacari. Doua persoane primesc ingrijiri medicale (galerie foto)
www.ziuaconstanta.ro - Constanţa
Pompierii din cadrul Inspectoratului pentru Situatii de Urgenta Delta al Judetului Tulcea, Detasamentul Tulcea au fost solicitati sa intervina pentru limitarea efectelor unui incendiu care se manifesta ...

Cea mai recentă generaţie de produse IQOS, lansată oficial de PMI pe piaţa din România
www.tion.ro - Timiş
ADVERTORIAL. După lansarea globală din Tokyo, cele mai noi dispozitive IQOS 3 şi IQOS 3 MULTI ajung şi în România, venind în întâmpinarea nevoilor utilizatorilor cu un design şi funcţionalităţi îmbunătăţite. Peste 5 milioane de fumători adulţi din întreaga lume au renunţat la consumul de ţigări convenţionale, în favoarea alternativei fără fum.

ANUNȚ de la Primăria Miercurea Ciuc
ziarharghita.ro - Harghita
Primăria Municipiului Miercurea Ciuc aduce la cunoştinţa locuitorilor că data de 30 noiembrie, ziua Sfântului Apostol Andrei este zi liberă, nelucrătoare,

Trump a dat lovitura. Arabia Saudită cumpără rachete din SUA în valoare de 15 miliarde de dolari
evz.ro - Bucureşti
Arabia Saudită va cumpăra sisteme de apărare antirachetă în valoare de 15 miliarde dolari americani de la compania americană Lockheed Martin....

Colectare cadouri pentru copii nevoiaşi la Târgul de Crăciun din Sibiu
ultimaora.oradesibiu.ro - Sibiu
Târgul de Crăciun din Sibiu împreună cu Asociaţia WeHelp sunt din nou parteneri ai programului „ShoeBox”, prin care oricine poate dărui un cadou de Crăciun copiilor cu o situaţie materială dificilă. Cadoul din cutia de pantofi “ShoeBox” este o iniţiativă de ajutorare a copiilor din familii cu posibilităţi materiale reduse,…

VIDEO: Guvernul României huiduit, la Alba Iulia, de un grup de protestatari: ”Ruşine să vă fie!”
ziarulunirea.ro - Alba
Prezenţi la Alba Iulia pentru o şedinţă solemnă dedicată Centenarului, miniştrii Cabinetului Dăncilă au fost aşteptaţi cu huiduieli la statuia voievodului Mihai Viteazul, unde trebuiau să depună o coroană. Cei aproximativ 10 protestatari au scandat ”Ruşine să vă fie”, ”Demisia”. De altfel, şi pe drumul de la Catedrală şi până în Piaţa Cetăţii au fost […]

Guvernul României huiduit, la Alba Iulia, de un grup de protestatari: ”Ruşine să vă fie!”
ziarulunirea.ro - Alba
Prezenţi la Alba Iulia pentru o şedinţă solemnă dedicată Centenarului, miniştrii Cabinetului Dăncilă au fost aşteptaţi cu huiduieli la statuia voievodului Mihai Viteazul, unde trebuiau să depună o coroană. Cei aproximativ 10 protestatari au scandat ”Ruşine să vă fie”, ”Demisia”. De altfel, şi pe drumul de la Catedrală şi până în Piaţa Cetăţii au fost […]

Atenţie! Doar aceste perioade vor fi considerate vechime în muncă! Milioane de români sunt vizaţi
evz.ro - Bucureşti
Doar anumite perioade vor fi considerate vechime în muncă, asta au decis senatorii, luni, când au votat noua Lege a Pensiilor. Potrivit proiectului, ...

Fumat fără fum. S-a lansat cea mai recentă generaţie IQOS, liderul produselor cu tutun încălzit
evz.ro - Bucureşti
După lansarea globală din Tokyo, cele mai noi dispozitive IQOS 3 şi IQOS 3 MULTI au ajuns şi în România. Este ştiut, aceste dispozitive asigură un fumat făr...

Pensii. EXEMPLU VIRAL şi ÎN ROMÂNIA? O viaţă mai bună pentru milioane de pensionari
evz.ro - Bucureşti
Se anunţă „cadouri” la pensii. Toţi cei care în mod normal încasează sub 2.000 de lei, de sărbători, vor primi din partea statului un ajutor financiar....

Zeci de amenzi aplicate de politistii locali din Constanta in cartierul Henri Coanda. Ce nereguli au fost sesizate
www.ziuaconstanta.ro - Constanţa
In perioada 15.11.2018 - 25.11.2018, politistii locali din cadrul Directiei Generale Politia Locala Constanta au desfasurat mai multe actiuni tematice avand ca scop asigurarea si mentinerea unui ...

Andrei Tase, fericit că va interpreta, la Piteşti, imnul pe care l-a compus, „La mulţi ani, România!”
ziarulargesul.ro - Argeş
Studentul Andrei Tase este fericit că a fost invitat să interpreteze imnul pe care l-a compus, "La mulţi ani, România!", în cadrul unor spectacole din Piteşti prilejuite de Ziua Naţională. În ajunul Centenarului Marii Uniri, tânărul compozitor şi interpret a ajuns la o magnitudine de postări pe...

Cele mai des intalnite 7 intrebari despre trotinete
feedproxy.google.com - Braşov
Trotinetele au devenit mijloace de transport care se bucura de o popularitate deosebita in ultima vreme. Acest lucru este posibil gratie mai multor calitati: sunt rapide, nepoluante, foarte potrivite in mediul urban, te ajuta sa te mentii in forma si iti ofera multe momente placute. Cu toate acestea inca exista multe persoane care nu au

SC VITAL: Program interventii – Baia Mare, joi 29 noiembrie
ziarmm.ro - Maramureş
Locuitorii de pe strada Victoriei 1B raman fara apa joi, 29 noiembrie, in intervalul orar 09.00-12.00 din cauza unor lucrari de reparatii la bransament. Fara apa vor ramane joi si locuitorii din satul

Amazon intenţionează să vândă software care citeşte înregistrările medicale
www.tion.ro - Timiş
Amazon plănuieşte să înceapă vânzarea de software care să citească dosarele medicale pentru a găsi informaţii ce pot fi folosite pentru a îmbunătăţi tratamentul pacienţilor şi a reduce costurile, a anunţat gigantul e-commerce.

Codul QR pe intelesul liceenilor
www.infobraila.ro - Brăila
Comentarii comentariu

De Sf. Andrei şi de Ziua Naţională se dă startul sărbătorilor de iarnă la Bistriţa
www.timponline.ro - Bistriţa-Năsăud
Vineri 30 noiembrie, de Sfântul Andrei, zi liberă prin lege, vor fi aprinse luminile de sărbători în centrul istoric şi pe principalele artere din Bistriţa. În aceeaşi zi se deschid Târgul de Crăciun din Piaţa Centrală, lângă Biserica Evanghelică, unde vor fi 30 de căsuţe cu produse tradiţionale şi

RUSIA a dat lovitura. Agenţii lui PUTIN au pus mâna pe DOCUMENTELE SECRETE ale Ucrainei
evz.ro - Bucureşti
Serviciul Federal de Securitate din Federaţia Rusă a publicat documentele capturate de la marinarii ucraineni reţinuţi după incidentul din strâmtoarea Kerci...

LOVITURĂ DE TEATRU în dosarul lui SORIN BLEJNAR. Ce ar putea hotărî judecătorii Înaltei Curţi de Casaţie şi Justiţie
evz.ro - Bucureşti
Lovitură de teatru în cazul lui Sorin Blejnar. La termenul din 28 noiembrie, în dosarul în care fostul preşedinte ANAF este cercetat pentru complicitate la ...

Vanghelie povesteşte de la DNA: ”Am fost şicanat”
evz.ro - Bucureşti
Marian Vanghelie a spus în sala de judecată că a fost de chemat de mai multe ori la sediul central al DNA, unde anchetatorii obişnuiau să creeze presiune di...

MĂSURI DRACONICE pentru ALUNGAREA IMIGRANȚILOR? Cum au transformat nişte CARICATURI politica DANEMARCEI?
evz.ro - Bucureşti
Pe 30 septembrie 2005, când cotidianul danez Jyllands Posten a publicat 12 caricaturi ale Profetului Mohhamed, nimenui nu-şi imagina ce efecte teribile va a...

Licitaţie pentru execuţia celui de-al treilea pod. Anunţul primarului
portalsm.ro - Satu Mare
Licitaţie pentru execuţia celui de-al treilea pod. Anunţul primarului

Decrete de inaintare in grad a mai multor ofiteri semnate de presedintele Romaniei cu ocazia Zilei Nationale. Lista completa
www.ziuaconstanta.ro - Constanţa
Presedintele Romaniei, Klaus Iohannis, a semnat miercuri, 28 noiembrie a.c., urmatoarele decrete Decret privind inaintarea in gradul de general-maior - cu doua stele, in retragere, a domnului general de ...

FOTO: Mesh imens cu ”Festival de România”, pe Hotel Cetate din Alba Iulia
ziarulunirea.ro - Alba
Un mesh imens, ce promovează ”Festival de România” la Alba Iulia a fost amplasat miercuri pe Hotel Cetate, una dintre cele mai mari unităţi de cazare din oraş. Imaginea de pe pânza publicitară afişează pe fundalul alb, inscripţia ”Festival de România” şi 100, simbolul Centenarului. Manifestările prilejuite de Ziua Naţională a României au început, în […]

Proiect inedit: Biro Emeric va fi pe scena Teatrului Municipal Baia Mare alaturi de actorii piesei “Povesti din bucatarie”
ziarmm.ro - Maramureş
De Ziua Internationala a Persoanelor cu Dizabilitati, ASSOC Baia Mare, in parteneriat cu Teatrul Municipal Baia Mare si DGASPC Maramures, invita baimarenii la un proiect artistic inedit, care va aduce

Ordinul Asistenţilor Medicali Argeş şi primarul Ion Georgescu, împreună pentru sănătatea argeşenilor
ziarulargesul.ro - Argeş
Ordinul Asistenţilor Medicali Argeş a dus, la Mioveni, mesajul campaniei ,,UN TEST SALVEAZĂ O VIAȚĂ” demarată, la începutul acestui an, ca acţiune de amploare în lupta continuă împotriva cancerului de col uterin. La eveniment a fost prezent şi primarul oraşului Mioveni, Ion Georgescu, care a...

Guvernul Dăncilă a aterizat la Sibiu – Un autocar i-a dus pe miniştrii la Alba Iulia
ultimaora.oradesibiu.ro - Sibiu
Toţi membrii Guvernului Dăncilă vor participa joi la o şedinţă solemnă în Sala unirii de la Alba Iulia. Cu toţii au aterizat joi dimineaţa pe Aeroportul Sibiu. I-a adus aici o cursă Tarom. Miniştrii Guvernului Dăncilă s-au îmbarcat apoi într-un autocar care i-a dus la Alba Iulia. Ședinţa solemnă de…

Concerte cochete la Christmas Food Carusel în Piaţa Huet
ultimaora.oradesibiu.ro - Sibiu
14 truck-uri cu cel mai gustos street-food din România au poposit miercuri în Piaţa Huet, iar până duminică, sibienii şi turiştii se vor putea bucura de delicatese gătite pe patru roţi, de la preparate mexicane la mâncăruri asiatice sau de la burgeri zemoşi la eclere fine, în Piaţa Huet le…

Centenarul Marii Uniri. Moment impresionant pregatit de zeci de elevi cu aceasta ocazie (galerie foto-video)
www.ziuaconstanta.ro - Constanţa
Mai sunt doua zile pana la implinirea a 100 de ani de la Marea Unire si, in toata tara elevii si prescolarii se intrec in festivitati si momente special pregatite pentru a marca acest moment unic din ...

Cum sărbătoresc STUDENŢII PITEŞTENI ziua de 1 DECEMBRIE
ziarulargesul.ro - Argeş
Sâmbătă, 1 Decembrie, România îşi sărbătoreşte Ziua Naţională într-un an Centenar. Cu această ocazie, în Piteşti, dar şi alte localităţi argeşene, vor avea loc numeroase manifestări dedicate acestei sărbători. Despre semnificaţia acestei zile, dar şi cum o sărbătoresc studenţii, puteţi afla din...

Pronunţare în Dosarul DIPLOMELOR FALSE obţinute Dragnea şi apropiaţii lui
evz.ro - Bucureşti
Scandalul diplomelor false care vizează două universităţi din Alexandria, Universitatea Alexandru Ghica şi Universitatea Europa Ecor se va finaliza în insta...

Lovitură pentru imigranţii din Austria. Ce le pregăteşte statul austriac
evz.ro - Bucureşti
Ajutor social de 863 euro doar pentru imigranţii care ştiu limba germană. Aceasta este decizia pe care au luat-o autorităţile austriece în ceea ce priveşte ...

Victorie pentru BUGETARI. Vor primi mai MULȚI BANI începând din DECEMBRIE. Despre ce SUME este vorba
evz.ro - Bucureşti
O nouă victorie pentru bugetari. Aceştia vor primi mai mulţi bani începând cu luna decembrie. Indemnizaţia de hrană va fi în valoare de 300 de lei....

Seria proastă continuă la UVT Agroland Timişoara. Echipa a avut un debut prost în cupele europene
www.tion.ro - Timiş
UVT Agroland Timişoara continuă seria rezultatelor proaste din campionat şi în cupele europene. Deşi era extrem de încrezătoare, echipa a pierdut prima manşă din 16-imile de finală ale Cupei Challenge, cu formaţia Vasas Budapesta, scor 3-1.

Super concert ”100 pentru România”, la BT Arena Cluj. Momente UNICE cu Bittman, Goia, Minculescu - VIDEO
www.stiridecluj.ro - Cluj
Super concert ”100 pentru România”, la BT Arena Cluj. Momente UNICE cu Bittman, Goia, Minculescu - VIDEO

FOTO, LIVE-TEXT: Unirea Alba Iulia – Crişul Chişineu Criş| Azi, pe „Cetate”, ora 14.00, ultima reprezentaţie a turului pentru “alb-negri”
ziarulunirea.ro - Alba
Confruntarea de astăzi, joi, 29 noiembrie, de pe “Cetate”, de la ora 14.00, dintre Unirea Alba Iulia şi Crişul Chişineu Criş, are o însemnătate aparte pentru amfitrioni. “Alb-negrii” vizează victoria la ultima reprezentaţie internă tocmai pentru a dedica succesul Zilei Naţionale, asta dincolo de importanţa celor trei puncte puse-n joc, în condiţiile în care uniriştii […]

FOTO Dezastru pe o stradă la doi kilometri de centrul Sibiului – Municipalitatea spune că ”se rezolvă”
ultimaora.oradesibiu.ro - Sibiu
Tot mai mulţi sibieni se plâng de faptul că străzile pe care locuiesc sunt pline de noroi, iar şantierele începute au fost lăsate de izbelişte o dată ce a început vremea rea. Un astfel de exemplu este strada Dorobanţilor. Locuitorii de aici sunt nemulţumiţi că după schimbarea reţelei de canalizare…

Spectacol: “Sara de colinde, folclor si traditii maramuresene” in Cluj-Napoca
ziarmm.ro - Maramureş
Asociatia Maramuresenilor din Cluj-Napoca organizeaza un spectacol aniversar de exceptie, intitulat “Sara de colinde, folclor si traditii maramuresene” unde vor evolua artisti de seama din judetul nos

Poliţiştii floreşteni au recuperat din Sibiu bunuri furate din centrul Vivo
feedproxy.google.com - Cluj
În urma unor percheziţii efectuate la Sibiu, poliţiştii clujeni au reţinut, pentru 24 de ore, un bărbat bănuit că a furta mai multe bunuri

”Junii Tarnavei”, parteneri în cadrul „Folk Friends Together”
www.zi-de-zi.ro - Mureş
În perioada 22-25 noiembrie 2018, ”Junii Tarnavei” au fost prezenţi la Bucureşti, în calitate de pa

Koln: 10.000 de locuitori evacuaţi din cauza unei bombe datând din al Doilea Război Mondial
www.tion.ro - Timiş
Cel puţin 10.000 de locuitori ai oraşului Koln, Germania, au fost evacuaţi miercuri seara, din casele lor, după descoperirea unei bombe datând din al Doilea Război Mondial. Experţii militari au fost chemaţi pentru a dezamorsa bomba.

Campania ”Nu arunca pâinea”, lansată la Cluj de către La Lorraine. Românii aruncă anual alimente care pot hrăni Clujul 20 de ani VIDEO
www.stiridecluj.ro - Cluj
Fabrica de produse de panificaţie şi patiserie La Lorraine, din Câmpia Turzii,...

Mega-lovitură pentru Liviu Dragnea-Se anunţă un protest uriaş
evz.ro - Bucureşti
Șoc pentru Liviu Dragnea! Se anunţă un protest masiv. Acesta va fi organizat de comunităţile civice #Corupţia Ucide şi #Rezistenţa, iar tema este ”La mulţi ani în UE, România! E timpul să scapi de hoţi!”....

De Centenar, onor la general!
ziarulargesul.ro - Argeş
Astăzi, la ora 11.00, la Muzeul Cula Racoviţa din Mioveni va sosi generalul de brigadă în retragere Constantin Năstase. Evenimentul se anunţă emoţionant. Constantin Năstase va primi din partea administraţiei judeţene Medalia centenară şi Tricolorul regal. Totodată, la muzeu va avea loc şi o...

Înalta Curte: Procesele lui Dragnea, Udrea şi Bica amânate
evz.ro - Bucureşti
Un comunicat al Înaltei Curţi de casaţie şi Justiţie arată că Adunarea generală a judecătorilor Instanţei supreme a decis ca şedinţele de judecată din 3 şi ...

Ambiguitate şi amânare pentru marile teme ale Brexit. Guvernul May, fără susţinere parlamentară. Pulsul planetei
evz.ro - Bucureşti
Liderii celor 27 de state membre ale Uniunii Europene au aprobat duminică acordul privind ieşirea Marii Britanii din blocul comunitar, după cum a anunţat pr...

Campania ”Nu arunca pâinea”, lansată la Cluj de către La Lorraine. Românii aruncă anual alimente care pot hrăni Clujul 20 de ani VIDEO
www.stiridecluj.ro - Cluj
Fabrica de produse de panificaţie şi patiserie La Lorraine, din Câmpia Turzii,...

Cenaclul literar LitArt, la o nouă întrunire. Mădălina Porime şi Adriana Pană, recital la „masa creaţiei”
www.zi-de-zi.ro - Mureş
Marţi, 27 noiembrie, s-a desfăşurat încă una din ediţiile Cenaclului Literar LitArt, cenaclu care re

Slobozia: Restricţii de circulaţie pe 1 Decembrie
obiectiv.net - Ialomiţa
Măsuri de ordine publică şi recomandări pentru participanţii la adunări publice Pentru gestionarea optimă a evenimentelor ce se vor desfăşura în... Vezi tot

Restrictii de circulatie pe Autostrada Soarelui si DN39 Constanta-Mangalia in minivacanta de 1 Decembrie
www.ziuaconstanta.ro - Constanţa
CNAIR SA reaminteste participantilor la trafic ca potrivit prevederilor HG nr.1777 2004 privind introducerea restrictiei de circulatie pe unele sectoare de autostrazi si drumuri nationale europene E ...

LIVE VIDEO/ FOTO: Premierul Viorica Dăncilă şi miniştrii ei, astăzi, la Sala Unirii, la şedinţa solemnă de Guvern dedicată celebrării Zilei Naţionale a României
ziarulunirea.ro - Alba
Premierul Viorica Dăncilă şi miniştrii din Cabinetul ei sunt, astăzi, în Alba Iulia. Vor participa la o şedinţă solemnă de Guvern dedicată celebrării Zilei Naţionale a României, la Sala Unirii unde acum 100 de ani s-a hotărât unirea Transilvaniei cu România. ”Prim-ministrul Viorica Dăncilă şi membrii Guvernului României vor participa joi, 29 noiembrie, la Alba […]

Opera Group Project Cluj, în concert la Reghin
www.zi-de-zi.ro - Mureş
Sub bagheta dirijorului Cristian Sandu, Casa de Cultură ”Eugen Nicoară” din Reghin va găzdui, vineri

Ministerul Educaţiei lansează de 1 Decembrie 2018 un concurs care începe peste alte două zile
evz.ro - Bucureşti
Ministerul Educaţiei Naţionale lansează, cu prilejul Zilei Naţionale de 1 Decembrie 2018, un concurs naţional de creativitate pentru elevi şi studenţi consa...

VIDEO. Pe jos spre Alba Iulia. Călătorie dificilă pentru careieni: ,,Doi dintre băieţi nu mai pot continua”
portalsm.ro - Satu Mare
Pe jos spre Alba Iulia. Călătorie dificilă pentru careieni: ,,Doi dintre băieţi nu mai pot continua''

5386 persoane angajate prin intermediul AJOFM Alba, în primele 10 luni ale anului 2018
ziarulunirea.ro - Alba
Ca urmare a implementării Programului de Ocupare a Forţei de Muncă, prin intermediul AJOFM Alba, în primele zece luni ale anului 2018 au fost încadrate în muncă 5386 persoane, dintre care 2377 femei. Din totalul persoanelor ocupate până la data de referinţă, 1868 au peste 45 de ani, 1753 au vârsta cuprinsă între 35 şi […]

Sava Negrean Brudaşcu, de Centenarul Marii Uniri la Ideciu de Jos
www.zi-de-zi.ro - Mureş
Primăria şi Consiliul Local al comunei Ideciu de Jos organizează vineri, 30 noiembrie, începând cu o

(FOTO) Un tablou de Renoir, furat de la o casa de licitatie din Viena
ziarmm.ro - Maramureş
Un tablou de mici dimensiuni realizat de pictorul impresionist francez Pierre-Auguste Renoir a fost furat din sediul unei renumite case de licitatii din centrul Vienei, a anuntat miercuri Politia loca

Senatorul Ioan Cristina, la Bruxelles: „Aplicarea uniformă a legislaţiei UE în toate statele membre este esenţială”
newsar.ro - Arad
Citeşte azi ce scriu ziarele de mâine!

Judecată în doi: Anchetat pentru fapte penale, judecătorul Ovidiu Galea vrea să judece… penali
www.ebihoreanul.ro - Bihor
Şedinţă mare, săptămâna trecută, la Tribunalul Bihor, unde colegiul de conducere s-a strâns să clarifice chestiuni legate de componenţa completelor de judecată. Întrunirea s-a desfăşurat cu săptămânalul BIHOREANUL pe masă, numărul precedent dezvăluind că unul dintre subiectele 'fierbinţi' îl privea pe Ovidiu Galea, judecat pentru că şi-a tăinuit apartenenţa la masonerie, dar reîntors la muncă mulţumită unor modificări controversate la statutul magistraţilor.

Program inedit de Ziua Naţională la ”Ariel”
www.zi-de-zi.ro - Mureş
Cu ocazia zilei de 1 Decembrie, aniversarea Marii Uniri, Teatrul pentru copii şi tineret „Ariel” vin

Permisul de conducere. VESTE EXCELENTĂ pentru şoferii din România. News alert!
evz.ro - Bucureşti
Camera Deputaţilor a adoptat, un proiect de lege prin care conducătorii auto pot să depună dovada înlocuitoare a permisului de conducere la Poliţia Rutieră ...

Pensii. EXEMPLU VIRAL şi ÎN ROMÂNIA. O viaţă mai bună pentru milioane de pensionari
evz.ro - Bucureşti
Se anunţă „cadouri” la pensii. Toţi cei care în mod normal încasează sub 2.000 de lei, de sărbători, vor primi din partea statului un ajutor financiar....

Restricţii de trafic, duminică, în zona Arcului de Triumf
evz.ro - Bucureşti
Duminică, între orele 9,00 şi 16,00, Arcul de Triumf va fi deschis pentru public, acesta fiind motivul pentru care nu se va circula pe banda adiacentă monum...

Oaspete inedit pentru tinerii creştini ortodocşi la Reghin
www.zi-de-zi.ro - Mureş
Protopopiatul Ortodox Român Reghin, Liceul Tehnologic ”Petru Maior” , cu binecuvântarea Înaltpreasfi

Aspirina ARE UN SECRET INCREDIBIL! Studiu de ultimă oră şi BREAKING NEWS în sistemul de sănătate
evz.ro - Bucureşti
Aspirina, folosită în doze reduse, ar putea diminua gravitatea simptomelor şi anomaliilor sistemului imunitar la pacienţii cu scleroză multiplă, după ce a f...

Este oficial! Schimbări importante în sistemul de pensii! Ce se întâmplă din 2021
evz.ro - Bucureşti
Un nou proiect privind sistemul de pensii din România a fost adoptat recent de Guvern. Modificările ar trebui să intre în vigoare începând cu anul 2021 când...

Robu, despre rectificarea bugetară neasumată: ”Este un act de boicot ce aţi făcut”
evz.ro - Bucureşti
Scandal, miercuri după-amiază, în Consiliul Local Timişoara, unde edilul a fost nemulţumit că nu a trecut rectificarea bugetară supusă la vot....

UPDATE. Judetul Constanta. Trafic ingreunat pe mai multe drumuri din cauza zapezii si a viscolului. In anumite zone sunt troiene de un metru (galerie foto)
www.ziuaconstanta.ro - Constanţa
Ninsoarea si viscolul pun probleme si in aceasta dimineata pe drumurile din judetul Constanta. Drumarii fac tot posibilul sa intervina la timp dar, din cauza unor conducatori auto mai grabiti ...

GHIVECIUL din Piteşti: mâncare şi GUNOAIE SUB… DRAPEL!
ziarulargesul.ro - Argeş
... Este imaginea pe care am surprins-o în această dimineaţă, la intersecţia dintre Calea Smeurei şi Strada Teilor. Tomberoanele unui supermaket dau pe dinafară, iar cetăţenii trag pe nas aerul rece de iarnă cu note subtile de mâncare stricată. Asta în vreme ce pe un afiş alăturat sunt promovate...

Prefectura Maramures: Liniile tehnologice vor putea fi achizitionate direct prin Baza de date cu preturile de referinta ale AFIR
ziarmm.ro - Maramureş
Prefectura Maramures a anuntat pe pagina de Facebook faptul ca, din luna noiembrie a.c., importatorii, producatorii sau dealerii vor putea achizitiona liniile tehnologice direct prin Baza de date cu p

Centenarul Marii Uniri, marcat prin tradiţii la „Petru Maior”
www.zi-de-zi.ro - Mureş
Liceul Tehnologic ”Petru Maior

Ștefan Hruşcă, recital de colinde la Casa de Cultură din Năsăud
www.timponline.ro - Bistriţa-Năsăud
Casa de Cultură ”Liviu Rebreanu” vă aşteaptă la un concert extraordinar de colinde marca Ştefan Hruşcă. Cunoscutul interpret se întoarce acasă pentru un turneu aniversar, iar vocea care întregeşte de un sfert de veac magia sărbătorilor de iarnă va bucura ascultătorii de pretutindeni cu acordurile co

Germania: Piata de Craciun din Ulm, pazita de vrabii uriase antiteroriste
ziarmm.ro - Maramureş
Cinci vrabii uriase pazesc una din intrarile principale in piata de Craciun din orasul Ulm, in sudul Germaniei, in efortul autoritatilor de a preveni un eventual atac terorist, relateaza miercuri dpa,

Viceprim-ministrul Ana Birchall, la receptia oferita de Ambasada Romaniei la Washington, cu ocazia aniversarii Centenarului Marii Uniri.
www.ziuaconstanta.ro - Constanţa
Viceprim-ministrul Ana Birchall a participat miercuri, 28 noeimbrie a.c., la receptia oferita de Ambasada Romaniei la Washington, cu ocazia aniversarii Centenarului Marii Uniri. La eveniment a participat si ...

160.000 de leduri şi 702 modele luminoase vor lumina străzile Braşovului
feedproxy.google.com - Braşov
Edilii braşoveni au pus la punct ultimele detalii ale iluminatului de sărbători pentru aniversarea Centenarului şi pentru „Braşov, oraş din poveste”. În acest an, iluminatul festiv de sărbători se aprinde în Braşov mai devreme, pentru a marca 100 de ani de la înfăpruirea Marii Uniri. Astfel, din seara de 1 Decembrie, când începe festivitatea aprinderii

Klaus Iohannis va promulga, joi, Legea privind realizarea Autostrăzii Iaşi-Târgu Mureş
evz.ro - Bucureşti
Legea privind realizarea Autostrăzii Iaşi-Târgu va fi promulgată de preşedintele Klaus Iohannis joi, într-o ceremonie publică. La eveniment vor participa şi...

Racolată de domni cu maşini argintii. Povestea unei bătrâne din Piaţa Unirii: „Mă întâlnesc cu şefu’ ăl mare. Unu’ Covaci. ”
evz.ro - Bucureşti
A nins abundent în Bucureşti, a nins viscolit, iar oraşul a intrat sub stăpânirea gerului aprig suflat din plămânii reci ai Siberiei, câştigător încă o dată...

Cine este amiralul Centenarului?
www.ziuaconstanta.ro - Constanţa
Singurul ofiter de marina inaintat de presedintele Klaus Iohannis la gradul de contraamiral de flotila,cu o stea, in retragere, cu prilejul Centenarului Marii U

Ziua Naţională, moment de aleasă sărbătoare pentru comuna Deda
www.zi-de-zi.ro - Mureş
Primăria şi Consiliul Local Deda şi Asociaţia Culturală ”Cununa Călimanilor” vor marca Ziua Naţional

CCR: Prevederea privind repartizarea aleatorie a cauzelor contravine principiului constituţional al subordonării ierarhice
evz.ro - Bucureşti
Repartizarea aleatorie către procurori a cauzelor, contravine principiului constituţional al subordonării ierarhice, precizează CCR în motivarea deciziei p...

Muncitor prins sub un mal de pământ pe strada Lyon
ultimaora.oradesibiu.ro - Sibiu
Un bărbat a fost prins joi dimineaţa sun un mal de pământ. Accidentul s-a petrecut pe strada Lyon. Pentru salvarea bărbatului la faţa locului au ajuns trei echipaje de pompieri şi descarcerare şi o ambulanţă SMURD. În cele din urmă bărbatul a fost scos, este conştient şi primeşte îngrijiri medicale…

Ce s-a ales de tanti Cornelia, nevasta eroului care şi-a pierdut o mână şi un ochi în Al Doilea Război Mondial
evz.ro - Bucureşti
A nins abundent în Bucureşti, a nins viscolit, iar oraşul a intrat sub stăpânirea gerului aprig suflat din plămânii reci ai Siberiei, câştigător încă o dată...

Preşedintele ucrainian Poroşenko cere intervenţia statelor NATO, în conflictul cu Rusia. Ce spune despre Putin
evz.ro - Bucureşti
Preşedintele Ucrainei, Petro Poroşenko, cere ajutor NATO. El a solicitat joi statelor membre al Alianţei Nord-Atlantice să trimită nave în Marea Azov, acolo...

Anunt
www.infobraila.ro - Brăila
Comentarii comentariu

SE RUPE EUROPA: O ţară este gata să scoată ARMATA pe străzi!
evz.ro - Bucureşti
Armata britanică a pus la cale un plan privind mobilizarea a mii de militari care să acţioneze în cazul în care Marea Britanie va ieşi din Uniunea Europeană...

FOTO: Spectacol la Cluj al Ansamblului „Maria Lătăreţu”
www.gorjeanul.ro - Gorj
Ansamblul Folcloric „Maria Lătăreţu” al Şcolii Populare de Artă Târgu Jiu, va participa, astăzi, 29 noiembrie 2018, Sala „Şantier” a Şcolii Populare de Arte „Tudor Jarda” , la spectacolul de folclor „Trei inimi româneşti” – Banat, Olteni

Comoditatea costă! Taximetriştii lugojeni vor să mărească tarifele
expressdebanat.ro - Caraş-Severin
Taximetriştii lugojeni au depus o solicitare la Primăria Lugoj prin care cer autorităţilor locale aprobarea creşterii tarifului maximal pe raza municipiului. Modificările de tarife se pot face doar prin decizia Consiliului Local, care poate aproba sau nu schimbarea regulamentului de transport, care este comun şi pentru cel în regim de taxi şi cel cu autobuzele.

Astazi: Temperaturi scazute in Maramures. A nins slab in zona montana inalta
ziarmm.ro - Maramureş
Vremea s-a racit fata de intervalul precedent. A nins slab in zona montana inalta, mai exact in zona localitatii Borsa. Carosabilul sectoarelor de drumuri nationale este curat si uscat. Pe DN 18 in Pa

Cum se circula pe bulevardele si strazile din municipiul Constanta. Ce le recomanda autoritatile cetatenilor (galerie foto)
www.ziuaconstanta.ro - Constanţa
Potrivit Centrului Meteorologic Regional Dobrogea, incepand din aceasta dimineata, vremea se mentine deosebit de rece si va bate vantul cu putere. Cerul va fi temporar noros si trecator va mai ninge ...

FOTO: Astăzi, concert Lyra Gorjului, la Teatrul „Elvira Godeanu”
www.gorjeanul.ro - Gorj
Cu prilejul aniversării Centenarului României, Orchestra de Cameră Lyra Gorjului, a Școlii Populare de Artă Târgu Jiu, vă invită joi, 29 noiembrie 2018, la Teatrul Dramatic „Elvira Godeanu”, începând cu ora 19:00, la un concert special, cu un program car

Criză de meseriaşi în construcţii
www.zi-de-zi.ro - Mureş
Forţa de muncă din construcţii se află în continuă scădere, iar în aceste condiţii, patronatele cer

Serbările CENTENARULUI, la Alba Iulia. PROGRAMUL evenimentelor din 29 noiembrie
ziarulunirea.ro - Alba
La Alba Iulia au debutat Serbările Centenarului cu două zile în care sunt programate vernisajele unor expoziţii, dar şi un ceremonial ce va avea loc la Sala Unirii şi un concert care va încheia seria de evenimente culturale. Astfel, după ce ieri au fost vernisate expoziţiile Scriitori români în Primul Război Mondial”, la Biblioteca judeţeană […]

Viaţă mai scumpă în Oradea! Taxele pentru parcări, aquapark, ştrand, zoo şi cimitir se majorează de la 1 ianuarie
www.ebihoreanul.ro - Bihor
Anul 2019 se anunţă de pe acum unul mai scump! Consiliul Local a hotărât, miercuri, cu votul exclusiv al reprezentanţilor PNL, majorarea taxelor locale pentru parcări, aquapark, ştrand, zoo şi cimitir, începând cu data de 1 ianuarie. Majorările sunt justificate de reprezentanţii municipalităţii prin actualizarea cu rata inflaţiei şi majorarea salariului minim pe economie.

„Petrecerea tuturor strigoilor“ la Castelul Bran
feedproxy.google.com - Braşov
Timp de patru zile Castelul Bran, credincios aparător al tradiţiilor şi obiceiurilor româneşti, propune vizitatorilor săi o incursiune în trecut cu gândul să creeze, în viitor, o noua tradiţie, prin evenimentul special „Petrecerea tuturor strigoilor”. Astfel, începând de astăzi şi până pe 2 decembrie, „vom spune adio tuturor relelor şi tuturor spaimelor de peste an

Peste 120 de străzi din Bistriţa, fără nume. De ce refuză primarul să le boteze
www.timponline.ro - Bistriţa-Năsăud
Peste 120 de străzi noi au apărut la Bistriţa în ultimii cinci ani, iar autorităţile locale nu le-au dat încă niciun nume, a atras atenţia secretarul municipiului Bistriţa, Floare Gaftone. În aceste condiţii, bistriţenii care locuiesc pe străzile respective nu îşi pot face cărţi de identitate. Prima

Campania umanitară „Ghetuţele lui Moş Nicolae” a ajuns la jumătatea drumului
expressdebanat.ro - Caraş-Severin
100 de copii proveniţi din familii defavorizate, de pe raza judeţului Caraş-Severin vor simţi căldura, atât la propriu cât şi la figurat. Încă 100 îşi aşteaptă ghetuţele.

Peste 120 de străzi din Bistriţa, fără nume. De ce refuză primarul să le boteze
www.timponline.ro - Bistriţa-Năsăud
Peste 120 de străzi noi au apărut la Bistriţa în ultimii cinci ani, iar autorităţile locale nu le-au dat încă niciun nume, a atras atenţia secretarul municipiului Bistriţa, Floare Gaftone. În aceste condiţii, bistriţenii care locuiesc pe străzile respective nu îşi pot face cărţi de identitate. Prima

Taekwon-do ITF: 37 de medalii obtinute de sportivii baimareni la Cupa Romaniei de la Deva
ziarmm.ro - Maramureş
37 medalii au obtinut baimarenii de la Clubului Sportiv Dragonul la Cupa Romaniei la Taekwon-do ITF pentru juniori 3, 2, 1 si seniori, care s-a desfasurat in localitatea Deva. Acestia au revenit acasa

Salarii mai mari pentru cadrele didactice – Două sporuri noi acordate
www.oradesibiu.ro - Sibiu
Cadrele didactice vor câştiga din decembrie mai mulţi bani. O nouă majorare de leafă va avea loc şi la începutul anului viitor. De la 1 Decembrie, fiecare cadru didactic primeşte 10% în plus, la salariu, spor de suprasolicitare, anunţă Digi24. Apoi, de la 1 ianuarie, spor pentru condiţii vătămătoare. Ministrul…

Se apropie sărbătorile – Pe ce canale tv vedem filmul ’’Singur Acasă’’
www.oradesibiu.ro - Sibiu
Producţia cinematografică cea mai savurată în prag de sărbători, se vede anul acesta pe două canale în România. Postul de filme al Digi, Film Now, va difuza în Ajunul Crăciunului şi în ziua de Crăciun, filmele Singur Acasă şi Singur Acasă 2: Pierdut în New York, anunţă paginademedia.ro. Fostul Digi…

Neamţ: Incendiu la o locuinţă din Taşca (FOTO)
www.stiri-neamt.ro - Neamţ
Miercuri, 28 noiembrie 2018, în jurul orei 18:30, Dispeceratul Integrat ISU – Ambulanţă al judeţului Neamţ a fost anunţat, prin Sistemul naţional unic

Masina de politie implicata intr-un accident in timpul unei misiuni e urmarire in trafic. Unde a avut loc evenimentul rutier
www.ziuaconstanta.ro - Constanţa
O autospeciala a Brigazii Rutiere a Capitalei a fost lovita noaptea trecuta in timpul unei misiuni de urmarire a unui autoturism condus de un minor in varsta de 17 ani, care nu a oprit la semnalul ...

Poveşti de spionaj şi Marea Unire. Cine a fost MARIA, REGINA SPIONAJULUI? Documente şi relatări istorice
evz.ro - Bucureşti
Serviciile secrete româneşti „penetraseră” informativ Ardealul şi Bucovina încă din perioada în care Regatul era în neutralitate....

Eveniment în Anul Centenarului: o replică a sabiei lui Ștefan cel Mare, adusă acasă din Turcia
feedproxy.google.com - Braşov
O replică a sabiei lui Ştefan cel Mare, care este adusă din Turcia, va ajunge, joi dimineaţă, la noi în ţară, la Giurgiu. Cu această ocazie, Jandarmeria Română împreună autorităţile locale au pregătit un ceremonial militar şi religios impozant în Piaţa Tricolorului. Sabia va pleca apoi, către Sibiu, unde de la ora 17.30, în prezenţa

De unde ştim că Apostolul Andrei a creştinat România?
evz.ro - Bucureşti
Există voci care susţin că Apostolul Andrei nu a călcat niciodată pe pământ românesc şi totul ar fi o mistifi care. Iată mai jos o selecţie de izvoare istor...

Cum să construieşti un bloc la Bistriţa cu atâtea etaje câte vrei. Mostră de urbanism cu interes
www.timponline.ro - Bistriţa-Năsăud
Sunt unii dezvoltatori imobiliari la Bistriţa care ridică blocuri acolo unde vor ei şi cum vor fără să respecte documentele pe baza cărora este reglementat urbanismul întrucât acestea nu sunt coerente, nici transparente, ci pitite prin sertare de funcţionarii din administraţia locală şi interpretate

Cum să construieşti un bloc la Bistriţa cu atâtea etaje câte vrei cu complicitatea unor funcţionari
www.timponline.ro - Bistriţa-Năsăud
Sunt unii dezvoltatori imobiliari la Bistriţa care ridică blocuri acolo unde vor ei şi cum vor fără să respecte documentele pe baza cărora este reglementat urbanismul întrucât acestea nu sunt coerente, nici transparente, ci pitite prin sertare de funcţionarii din administraţia locală şi interpretate

Ședinta a Guvernului Romaniei. Ce proiecte au fost incluse pe ordinea de zi
www.ziuaconstanta.ro - Constanţa
Guvernul Romaniei se intruneste astazi in sedinta, iar pe agenda ar putea fi incluse urmatoarele proiecte de acte normative PROIECTE DE ORDONANTE DE URGENTA PROIECT DE ORDONANTA DE ...

Elimină riscurile! Pompierii au început verificarea zonelor de acces şi a hidranţilor din cartierele de blocuri
expressdebanat.ro - Caraş-Severin
Detaşamentul de Pompieri Lugoj a început o acţiune de verificare a zonelor de acces din oraş, unde pătrunderea cu autospeciale de stingere a incendiilor şi alte utilaje specifice este dificilă.

Accident auto. Un MINOR a lovit o MAȘINĂ de POLIȚIE
evz.ro - Bucureşti
Accident teribil la intersecţia Gura Crivăţului cu Gura Caliţei. Un autoturism condus de un minor a lovit o maşină a poliţiei....

Istoria României - Marea noastră Doamnă Învăţătoare. Lecţia de modestie pragmatică a lui Ion C. Brătianu. România lui Cristoiu
evz.ro - Bucureşti
Contemporanii au trudit din greu să explice îndelungata şi autoritara domnie a lui Ion C. Brătianu în zorii României moderne. Constantin Bacalbaşa se opreşt...

Neamţ: Troiţă închinată Reginei Maria la Tarcău
www.stiri-neamt.ro - Neamţ
În urmă cu 80 de ani, la 18 iulie 1938, Regina Maria s-a stins din viaţă, la Castelul Pelişor din Sinaia, după o grea suferinţă. Printre cei profund

Medicii atenţionează: expunerea prelungită la frig poate cauza degerături şi hipotermie
www.gorjeanul.ro - Gorj
Urmează câteva zile geroase, la nivelul întregii ţări. Din acest motiv, medicii atenţionează că expunerea prelungită la frig poate cauza hipotermie, degerături, dar şi probleme legate de starea psihică, precum somnolenţă, pierderi de memorie, dificultăţi de vorbire, iar pe vreme fri

Ședinţa solemnă de Centenar. Şicanele între bărbaţii de stat au marcat momentul istoric
evz.ro - Bucureşti
Între votul din plen şi avionul spre casă, parlamentarii au bifat Centenarul printr-o şedinţă solemnă a celor două Camere ale Parlamentului, moment care, or...

Decizia ȘOC luată în PARLAMENT: Toţi românii sunt în pericol!
evz.ro - Bucureşti
Toţi românii sunt în pericol: Tâlharii şi violatorii pot avea arme. Senatorii nu văd o problemă în asta....

Evită riscul unei amenzi ANAF pentru noile case de marcat, cu un avans de 100 lei!
www.ebihoreanul.ro - Bihor
Nedotarea în timp util cu case de marcat cu jurnal electronic este acoperită de legislaţia prevenirii, ceea ce înseamnă că firmele pot scăpa fără amendă la prima abatere.

Isarescu: Comisia de trecere la euro va publica doua rapoarte
ziarmm.ro - Maramureş
Comisia pentru trecerea la euro va face publice doua rapoarte in decembrie, insa lucrarile sunt tehnice si au 300 de pagini, iar noi am facut eforturi serioase sa traducem documentul din romana in rom

Tensiuni între Ungaria şi SUA. Budapesta a refuzat să extrădeze în SUA doi cetăţeni ruşi suspectaţi de trafic de arme
evz.ro - Bucureşti
Ungaria a refuzat să extrădeze în SUA doi cetăţeni ruşi suspectaţi de trafic de arme, a informat Departamentul de Stat al SUA săptămâna aceasta....

Rona Hartner SE MĂRITĂ! Alesul ei este celebrul HMJ. Breaking news în showbiz
evz.ro - Bucureşti
Se pare că Rona Hartner şi-a găsit alesul inimii. Aceasta trăieşte o adevărată poveste de dragoste alături de faimosul DJ HMJ....

Trafic ilegal cu organe de copii. SCANDAL DIPLOMATIC în UE! „Case de sacrificii umane” Breaking news
evz.ro - Bucureşti
Fostul şef al diplomaţiei greceşti până acum o lună face dezvăluiri cutremurătoare despre reţele de traficanţi de copii camuflate în spatele fluxului de imi...

Constanta. Opt nave sunt avizate pentru sosire in porturile maritime romanesti. Un este pentru remorcaj
www.ziuaconstanta.ro - Constanţa
Conform listei navelor avizate pentru sosire in data de 29 noiembrie 2018 in porturile maritime romanesti, publicate de portalul Compania Nationala Administratia Porturilor Maritime Constanta, sunt avizate ...

Bătrân mort pe o bancă, într-un parc din Codlea
feedproxy.google.com - Braşov
Un bărbat, în vârstă de 78 de ani a fost găsit, miercuri, în stop cardio-respirator, într-un parc din Codlea. Omul se afla pe o bancă, iar câţiva trecători au observat că nu se mişcă şi au sunat la 112. La faţa locului a ajuns un echipaj SMURD, care a aplicat manevre de resuscitare, însă, din

Hoţ din magazine, prins de poliţiştii clujeni tocmai la Sibiu. Au recuperat bunuri de câteva mii de euro FOTO
www.stiridecluj.ro - Cluj
Poliţiştii clujeni au au reţinut, în urma unor percheziţii efectuate la Sibi...

Comisia Europeana va restitui fermierilor europeni 444 de milioane de euro
ziarmm.ro - Maramureş
Comisia Europeana a anuntat miercuri ca va restitui fermierilor europeni 444 de milioane de euro, suma care initial a fost dedusa din platile directe pentru 2018 conform reglementarilor PAC (Politica

Hoţ din magazine, prins de poliţiştii clujeni tocmai la Sibiu. Au recuperat bunuri de câteva mii de euro FOTO
www.stiridecluj.ro - Cluj
Poliţiştii clujeni au au reţinut, în urma unor percheziţii efectuate la Sibi...

Neamţ: Temperaturi negative în toată Moldova. Cum se circulă pe drumurile naţionale
www.stiri-neamt.ro - Neamţ
La acest moment, circulaţia pe drumurile naţionale din Moldova se desfăşoară normal, fără blocaje cauzate de condiţiile meteo. Carosabilul este uscat, cu

Hoţ din magazine, prisn de poliţiştii clujeni tocmai la Sibiu. Au recuperat bunuri de câteva mii de euro FOTO
www.stiridecluj.ro - Cluj
Poliţiştii clujeni au au reţinut, în urma unor percheziţii efectuate la Sibi...

Vezi anunţul meteorologilor!
www.gorjeanul.ro - Gorj
Începând de astăzi, va deveni deosebit de rece în toată ţara începând de miercuri seara, iar noaptea va fi ger (temperaturi sub -10 grade) în special în nordul, nord-estul şi centrul ţării. Se vor înregistra ninsori şi, până pe 30 noiembrie la ora 10:00, în sud-estul teritoriului

Oreste, actor în serialul „Poanta-i veche, prostu-i nou”. Povestea unei fotografii
evz.ro - Bucureşti
În aceste zile se desfăşoară sub ochii noştri o adevărată telenovelă, care are în centrul atenţie o vedetă tv, un autointitulat jurnalist şi un patron de te...

Piatra-Neamţ: Hai la FILM! Programul Cinema Dacia în perioada 30 noiembrie – 6 decembrie
www.stiri-neamt.ro - Neamţ
Programul Cinema Dacia în perioada 30 noiembrie – 6 decembrie Vineri – 30.11 Ora 13:30 GRINCH 3D (DUBLAT)(A.G.)(animaţie)(90 min.) Ora 15:30 THE

Teodorovici despre preluarea Presedintiei Consiliului UE: Romania va actiona cu buna credinta si va fi un “broker onest”
ziarmm.ro - Maramureş
Romania va actiona cu buna credinta si echilibru in exercitarea Presedintiei Consiliului Uniunii Europene si va fi un 'broker onest' (honest broker), atat in ceea ce priveste harta intereselor statelo

Judetul Constanta. Trafic ingreunat pe mai multe drumuri din cauza zapezii si a viscolului
www.ziuaconstanta.ro - Constanţa
Ninsoarea si viscolul pun probleme si in aceasta dimineata pe drumurile din judetul Constanta. Drumarii fac tot posibilul sa intervina la timp dar, din cauza unor conducatori auto mai grabiti ...
![Ziua Naţională, sărbătorită în avans la Căminul pentru Persoane Vârstnice din Reşiţa [FOTO/VIDEO]](/showimg/300-200--zi/images/fullinfo.ro-images/news-273675.jpg)
Ziua Naţională, sărbătorită în avans la Căminul pentru Persoane Vârstnice din Reşiţa [FOTO/VIDEO]
expressdebanat.ro - Caraş-Severin
Sărbătoare, muzică tradiţională, cuvinte mari şi emoţii şi mai mari în această seară, la Căminul pentru Persoane Vârstnice din Reşiţa. Instituţia a sărbătorit în avans Ziua Naţională şi Centenarul Marii Uniri.

Junii invită braşovenii la Hora Unirii în Piaţa Sfatului
feedproxy.google.com - Braşov
Sâmbătă, 1 Decembrie 2018, Uniunea Junilor din Şcheii Braşovului şi Braşovul Vechi îi invită pe braşoveni să ia parte între orele 12.00- 13.00, la festivitatea dedicată Zilei Naţionale a României în Piaţa Unirii (Prund) din Braşov, organizată în parteneriat cu Primăria Municipiului Braşov. Evenimentul va debuta cu un serviciu religios dedicat memoriei eroilor neamului, Te

Iarnă în Gorj! Zeci de utilaje au acţionat pe drumurile naţionale
www.gorjeanul.ro - Gorj
Iarna s-a instalat în judeţul Gorj. În intervalul orar 17:00/28.11.2018-05:00/29.11.2018, pe drumurile administrate de către Secţia Drumuri Naţionale Târgu-Jiu s-a acţionat cu 32 autoutilaje şi s-au răspândit 285 tone material antiderapant; drumarii au fost prezenţi pe DN 66, DN 67, DN 6

În an centenar, Centrul Comercial Auchan Târgu-Mureş îmbogăţeşte fondul de carte al bibliotecilor publice rurale alături de Educab
www.zi-de-zi.ro - Mureş
Centrul Comercial Auchan Târgu-Mureş demarează campania naţională de îmbogăţire a fondului de carte

Căpuşe de Binş: Cum au dovedit procurorii că primarul de Beiuş plătea din bani publici benzina pentru VIP-urile urbei
www.ebihoreanul.ro - Bihor
Cum l-au dovedit procurorii pe primarul Beiuşului, Petru Mlendea-Căluş, care îşi alimenta maşina proprie şi pe cele ale altor VIP-uri locale din bani publici. Rechizitoriul Parchetului Beiuş dezvăluie şi alte abuzuri, încă rămase în anchetă, unul dintre ele fiind al predecesorului lui Mlendea, celebrul Adrian Domocoş, acuzat că a folosit ani întregi maşina Primăriei în interes personal.

Piatra-Neamţ: Shopping City sărbătoreşte 2 ani cu un concert aniversar Lidia Buble şi multe premii
www.stiri-neamt.ro - Neamţ
500 de premii oferite în perioada 1-2 decembrie. Concert Lidia Buble pe data de 2 decembrie, de la ora 19:00 Shopping City Piatra Neamţ aniversează 2 ani

Acţiuni de integrare a minorităţilor etnice
expressdebanat.ro - Caraş-Severin
MĂSURA 6.6/6B Acţiuni de integrare a minorităţilor etnice (inclusiv minoritatea romă)

Un sfert dintre români se împrumută pentru a-şi plăti facturile curente. O treime, dispusă să emigreze din cauza situaţiei financiare – RAPORT
ziarulunirea.ro - Alba
Un sfert dintre români se împrumută pentru a-şi achita facturile curente, iar circa o treime (32%) dintre conaţionali afirmă că este dispusă să emigreze din cauza situaţiei financiare din ţară, potrivit rezultatelor Raportului European al Plăţilor Consumatorilor. Raportul de specialitate relevă, totodată, că 59% dintre români fac economii în fiecare lună, valoarea medie a economiilor […]

Lucrari la Politie: Sediul Biroului Rutier Baia Mare intra in reparatii
ziarmm.ro - Maramureş
Sediul Biroului Rutier din cadrul Politiei Municipale Baia Mare intra in reabilitare. Acesta va fi reparat din fonduri europene, valoarea investitiei ridicandu-se la aproximativ 19.000 de euro. "Pentr

CULISELE CRIMEI care a ȘOCAT România. Ce este o „SINUCIDERE BREATHLESS”? Irakianul, căsătoria CIUDATĂ, Richard Gere şi Jean Paul Belmondo
evz.ro - Bucureşti
Sorina Chivoiu AL Falahi, femeia omorâtă de soţul său, îşi dedicase viaţa orfanilor. Zece lovituri de cuţit şi cinci gloanţe au transformat într-o ştire...

Urmează un nou weekend prelungit. Ce zile libere mai sunt în 2018
feedproxy.google.com - Braşov
În următoarele zile, românii sărbătoresc Sfântul Andrei şi 1 Decembrie, Ziua Naţională a României. Potrivit Codului muncii, zilele de 30 noiembrie şi 1 Decembrie sunt sărbători legale în care nu se lucrează. Pentru că Sfântul Andrei pică într-o zi de vineri, iar Ziua Naţională a României este sâmbăta, angajaţii vor beneficia de o minivacanţă de trei

Programul cu publicul la SPCLEP Braşov în minivacanţa de Sf. Andrei şi Ziua Naţională
feedproxy.google.com - Braşov
Serviciul Public Comunitar Local de Evidenţa Persoanelor Braşov (SPCLEP) din cadrul Primăriei Braşov, a comunicat programul cu publicul în următoarea perioadă, care prevede câteva zile libere. Astfel, la Starea Civilăva fi închis vineri, 30 noiembrie şi sâmbătă, 1 Decembrie, iar pe 2 decembrie nu este programată nicio căsătorie. La biroul Decese în datele de 30

Centenarul Marii Uniri, sărbătorit la Panciu
www.jurnaldevrancea.ro - Vrancea
Primarul Iulian Nica invită păncenii la manifestările dedicate aniversării Centenarului Marii Uniri şi Zilei Naţionale a României, care vor fi organizate | Jurnal de Vrancea

Se apropie sărbătorile – Pe ce canale tv vedem filmul ’’Singur Acasă’’
ultimaora.oradesibiu.ro - Sibiu
Producţia cinematografică cea mai savurată în prag de sărbători, se vede anul acesta pe două canale în România. Postul de filme al Digi, Film Now, va difuza în Ajunul Crăciunului şi în ziua de Crăciun, filmele Singur Acasă şi Singur Acasă 2: Pierdut în New York, anunţă paginademedia.ro. Fostul Digi…

NEWS ALERT/ Anunţ de ULTIMĂ ORĂ de la Meteo
newsar.ro - Arad
Citeşte azi ce scriu ziarele de mâine!

Primaria comunei Limanu, judetul Constanta angajeaza manager. Ce conditii trebuie indeplinite si cand este programat concursul
www.ziuaconstanta.ro - Constanţa
Primaria Comunei Limanu, Judetul Constanta organizeaza concurs de recrutare pentru ocuparea pe perioada nedeterminata a functiei contractuale de executie vacante de manager la Clubul Sportiv Poseidon ...

Silviu Hurduzeu nu plăteşte fasolea de 1 Decembrie
expressdebanat.ro - Caraş-Severin
Banii pe care îi are Silviu Hurduzeu în mână prin prisma poziţiei pe care o ocupă în Consiliul Judeţean Caraş-Severin nu se vor duce, de Ziua Naţională, spre tradiţionala fasole cu ciolan.

”Eşecuri de succes” – 70 de poveşti despre eşecurile celor mai influenţi oameni de afaceri din ţară
expressdebanat.ro - Caraş-Severin
Eşecul nu înseamnă un sfârşit de drum, ci poate fi chiar primul pas către succes. A demonstrat-o Vlad Mocanu, un tânăr de 23 de ani, care, după ce a stat de vorbă cu unii dintre cei mai influenţi oameni de afaceri din ţară, a aflat că greşelile pot construi, nu doar dărâma. Asta, doar dacă…

MOMENTUL ASTRAL al acestui pământ numit ROMÂNIA!
expressdebanat.ro - Caraş-Severin
„MOMENTUL ASTRAL al acestui pământ numit ROMÂNIA!“, sub acest titlu am primit de la senatorul Ionuţ Chisăliţă gânduri aşternute pe hârtie, acum, în prag de 1 Decembrie 2018, la împlinirea Centenarului Marii Uniri.

Mircea Badea, REACȚIE ACIDĂ cu privire la JUDECĂTORUL DAT AFARĂ din INM: „Preferata lui Iohannis dată afară”
evz.ro - Bucureşti
Mircea Badea a reacţionat imediat după aflarea veştii conform căreia Livia Stanciu, judecător, a fost dată afară de la INM....

Regimentul 307 Infanterie Marina la ceas aniversar. Astazi este Ziua Infanteriei Marine Romane
www.ziuaconstanta.ro - Constanţa
Prima mentionare a infanteristilor marini apare in anii 1886-1888 care faceau parte din echipajul crucisatorului ELISABETA , conform unui scurt istoric postat pe site-ul Fortelor Navale Romane. ...

Salarii mai mari pentru cadrele didactice – Două sporuri noi acordate
ultimaora.oradesibiu.ro - Sibiu
Cadrele didactice vor câştiga din decembrie mai mulţi bani. O nouă majorare de leafă va avea loc şi la începutul anului viitor. De la 1 Decembrie, fiecare cadru didactic primeşte 10% în plus, la salariu, spor de suprasolicitare, anunţă Digi24. Apoi, de la 1 ianuarie, spor pentru condiţii vătămătoare. Ministrul…

AMENZI URIAȘE pentru ȘOFERI. Ce NU trebuie să ai la maşină. POLIȚIA CHIAR VERIFICĂ
evz.ro - Bucureşti
Poliţia anunţă noi amenzi pentru şoferii care nu respectă cea mai simplă lege. Amenzile ajung şi la câteva zeci de milioane....

Iarna in toata regula in judetul Constanta. CNAIR a instituit restrictii de tonaj pe DN 38 si pe DN 2A
www.ziuaconstanta.ro - Constanţa
CNAIR a instituit restrictii de tonaj 7,5 tone pe DN 38, Agigea Negru Voda Vama si pe DN 2A, Harsova Ovidiu, din cauza ninsorii viscolite ce provoaca o vizibilitate extrem de redusa ...

Zeci de utilaje ale DRDP Constanta au actionat in cursul noptii. In ce zone au intervenit drumarii
www.ziuaconstanta.ro - Constanţa
In cursul noptii drumarii din cadrul DRDP Constanta au actionat cu zeci de utilaje si au raspandit sute de tone de sare pentru a se putea circula fara probleme. Potrivit reprezentantilor DRDP ...

Din nou fără Contract colectiv de muncă la DGASPC Caraş-Severin? Negocieri sistate, presa nu trebuie să afle!
expressdebanat.ro - Caraş-Severin
Negocierea Contractului colectiv de muncă (CCM) la Direcţia Generală de Asistenţă Socială şi Protecţia Copilului Caraş-Severin a intrat în impas. Un lider sindical aduce în discuţie... clientelismul politic.

Condiţionare pentru votul PSD în Consiliul Local Caransebeş
expressdebanat.ro - Caraş-Severin
Condiţionare pentru votul PSD în Consiliul Local Caransebeş

Plouă cu maternităţi în Timişoara! „Stimaţi tineri, contribuiţi la creşterea natalităţii! Noi vă asigurăm condiţii!“
expressdebanat.ro - Caraş-Severin
Teoretic, într-un viitor nu foarte îndepărtat, Timişoara va avea două maternităţi moderne. Una construită de Consiliul Judeţean Timiş în parteneriat cu Universitatea din Szeged, dar şi una pe care vor să o construiască autorităţile locale. În stilu-i caracteristic, primarul îndeamnă, în acest context, tinerii să facă mai mulţi copii.

Iarna in toata regula in judetul Constanta. CNAIR a instituit restrictii de tonaj pe DN 38 Agigea – Negru Voda (Vama) si pe DN 2A Harsova – Ovidiu
www.ziuaconstanta.ro - Constanţa
CNAIR a instituit restrictii de tonaj 7,5 tone pe DN 38, Agigea Negru Voda Vama si pe DN 2A, Harsova Ovidiu, din cauza ninsorii viscolite ce provoaca o vizibilitate extrem de redusa ...
 www.zi-de-zi.ro - Mureş
www.zi-de-zi.ro - Mureş

Vremea. GER şi HAOS în România. IARNĂ extrem de grea pentru români
evz.ro - Bucureşti
Vremea din 29 noiembrie se anunţă deosebit de rece în toată ţara! Va fi una dintre cele mai friguroase zile din săptămână. Prognoza meteo anunţă ger....

FOTO, VIDEO. Lucrările la restaurantul KFC din Alba Iulia, aproape finalizate. Logo-ul, iluminat pe timp de noapte
ziarulunirea.ro - Alba
Lucrările de amenajare a spaţiului la restaurantul KFC din centrul comercial Alba Mall sunt aproape finalizate, însă cu toate acestea nu este posibilă deschiderea până la 1 Decembrie. După cum arată spaţiul sunt mari şanse să fie imediat după. Miercuri seara, logo-ul brandului, amplasat în două locuri, pentru a fi vizibil şi din stradă, de […]

Locuri de muncă ASISTENȚI MEDICALI – 44 posturi libere
feedproxy.google.com
Locuri de muncă ASISTENȚI MEDICALI - Spitalul Municipal din Hunedoara încearcă să reducă deficitul de asistenţi medicali.

Meteo. Ieri a fost cum a fost. Sa vedeti astazi. Ger, vant puternic, zapada viscolita
www.ziuaconstanta.ro - Constanţa
Ger si zapada viscolita in Dobrogea

Revista presei locale
www.ziuaconstanta.ro - Constanţa
Revista presei locale

COMUNICAT DE PRESĂ – Soluţii pentru dezvoltarea mobilităţii urbane durabile în Zona Urbană Funcţională a Municipiului Alba Iulia
ziarulunirea.ro - Alba
Agenţia pentru Dezvoltare Regională Centru a organizat vineri, 23 noiembrie 2018 un eveniment regional de diseminare a acţiunilor privind mobilitatea şi transportului durabil în Zona Urbană Funcţională a Municipiului Alba Iulia, formată din Municipiul Alba Iulia şi şapte localităţi rurale: Ciugud, Ighiu, Cricău, Galda de Jos, Sântimbru, Întregalde şi Mihalţ. Organizat ca parte a proiectului […]

ziarulargesul.ro - Argeş
ziarulargesul.ro - Argeş























































































































 www.oltenasul.ro - Dolj
www.oltenasul.ro - Dolj















































































![Piatra-Neamţ: „Il viaggio”, un nou restaurant în Piatra-Neamţ (by Chef Giovanni) [FOTO-VIDEO]](/showimg/300-200--zi/images/fullinfo.ro-images/news-273873.jpg)


































































































































































![Ziua Naţională, sărbătorită în avans la Căminul pentru Persoane Vârstnice din Reşiţa [FOTO/VIDEO]](/showimg/300-200--zi/images/fullinfo.ro-images/news-273675.jpg)




























 www.zi-de-zi.ro - Mureş
www.zi-de-zi.ro - Mureş





